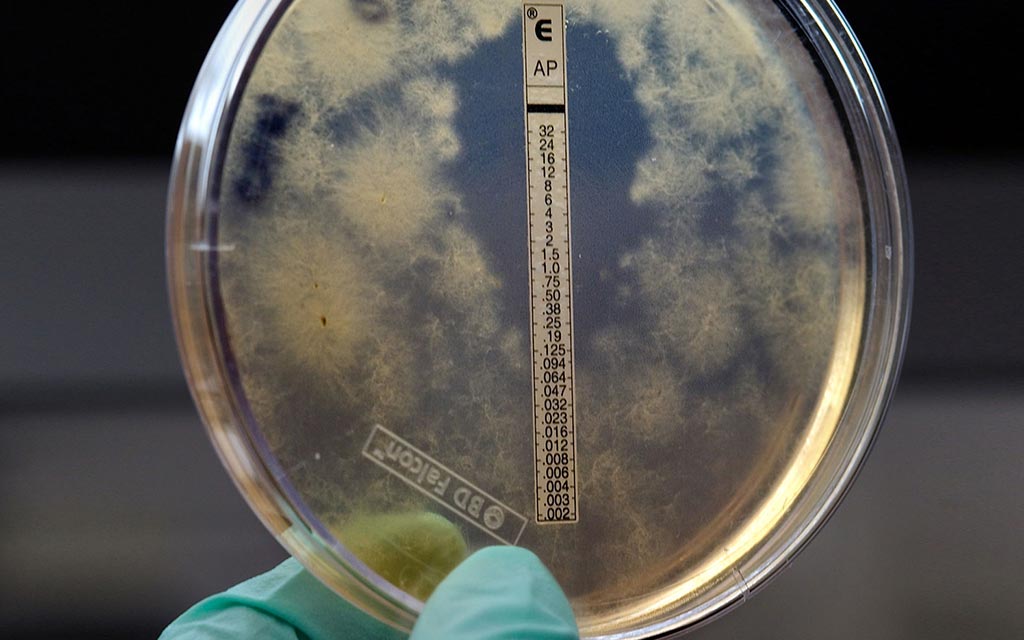

What Type Of Content Is This? Layer Map Scene App Quizlet
Back to Full Game
Select An Outbreak
Breathless in the Midwest

- Number Sick: 15
- Hospitalizations: 15
- Deaths: 7
- Location: US
A startling outbreak has been reported in Chicago and Milwaukee. Within the past 2 days, 15 people have visited emergency rooms complaining of high fever, fatigue, coughing, chest pain, and difficulty breathing. Several people have died, and others are near death!
Your help is needed to put an end to this outbreak!
Clue 1

The first reported case is a 37-year-old musician from Chicago named Zeke. You start by talking to Zeke to find out what he was doing before he got sick.
Zeke said that he started coughing and feeling very tired shortly after he led a music workshop for 50 students at a Chicago concert hall. He thought he might have picked something up from one of the students in the class, or perhaps he caught it 2 days ago on a flight home from vacation in Africa.
Tip

You decide to ask Zeke more about his trip to Africa.
You learn that Zeke and several of his friends took a trip to Mali last week. While they were there, Zeke took a side trip to meet a drum maker who taught him how to make djembes (African drums made of animal skins and wood). Zeke brought home 4 of the djembes he helped make.
Zeke and his friends returned home on the same 20-hour flight. After talking with Zeke's friends, you learn that he is the only one with a high fever, fatigue, cough, chest pain, and difficulty breathing.
1. Where do you think Zeke caught whatever made him sick?
Answer 1: The flight home from Mali
[Incorrect]
While sitting near other people for many hours on a flight can lead to sharing each other's germs, it's still too early to know exactly what's caused the outbreak.
Keep investigating to find out!
Answer 2: The music workshop
[Incorrect]
It's too early to know for sure, but Zeke remembered coughing and feeling very tired immediately after the class. Most colds, flus, and other viral infections take at least 1 day before symptoms are easily noticed.
Keep investigating to find out!
Answer 3: It's too soon to know for sure
[Correct]
You're right, it's too soon to tell when or how he caught his illness. We don't even know what disease we're dealing with yet.
You'll need to find out what Zeke has before you can determine what made him sick.
Keep investigating to find out!
Clue 2

More cases of the mysterious illness are being reported in Chicago and Milwaukee hospitals. Patients' loved ones are in a panic and are hoping you can help find out what's made everyone so sick.
Lab results show patients are infected with a bacterium that doctors suspect might be anthrax. You immediately send the samples to public health laboratories for testing, but that will take a couple of days.
In the meantime, you need to talk with everyone who is sick - and their families - to find out which activities they participated in before becoming sick. When you look at the responses to your questions, it seems that many of the sick people participated in the same activities recently - like working in a government building or attending a music event.
Data

You already have gotten information directly from sick patients or family members of those who died. You interview 85 people who are not sick, but participated in similar activities as those who are sick or died. In outbreak investigations we call these people the "population at risk of getting sick."
Each person was asked what they did in the 2 weeks before getting sick. The "attack rate" was calculated for each activity.
| Attack Rate | = | the number of people who participated in an activity and are sick |
| the total number of people who participated in an activity |
Hint: To find a possible source of the outbreak, look for both a high attack rate for those who participated in an activity and a low attack rate among those who did not participate.
Definition

Anthrax
Anthrax is a serious disease caused by a type of bacteria known as Bacillus anthracis. Anthrax is not contagious. You cannot catch it from another person, like you can catch the cold or flu.
Anthrax can be found naturally in the soil and can infect domestic and wild animals like cattle, sheep, and goats. The animals become sick when they eat spores (germs) in contaminated soil or vegetation.
People can get anthrax by:
- Handling products made from infected animals.
- Breathing in anthrax spores from animal products.
- Eating undercooked meat from infected animals.
- Being exposed to anthrax spores by bioterrorists.
Anthrax can get into the body through the skin, lungs, or digestive system.
2. What would you do next?
Answer 1: Re-check the data to see if there is one activity or exposure that all sick people have in common
[Correct]
You are correct. Knowing what activity or exposure these people have in common can help you find out where this outbreak may have started.
It looks like all of the sick people attended a music event in Chicago. You may be on to something! But what about the high number of sick people who work in or near a government building? Is that something to worry about too?
Answer 2: Interview workers in every government building in Milwaukee and Chicago
[Incorrect]
No. You've already interviewed well and sick people in the Chicago building where people got sick. Interviewing workers in every government building in these 2 cities would not be as helpful as knowing what activity or exposure these people have in common. Knowing this can help you find out where this outbreak may have started.
It looks like all of the sick people attended a music event in Chicago. You may be on to something! But what about the high number of sick people who work in or near a government building? Is that something to worry about too?
Answer 3: Cancel all music events in Chicago
[Incorrect]
No. Canceling all music events in Chicago is not necessary at this point and may cause a panic. That won't help solve the outbreak.
Instead, take this time to re-check your data and see what the sick people have in common.
It looks like all of the sick people attended a music event in Chicago. You may be on to something! But what about the high number of sick people who work in or near a government building? Is that something to worry about too?
Clue 3

With the large number of government workers who are sick, you decide to look into it more. Police reports show that there was a bioterrorism threat 3 days before Zeke and the others got sick - a former government employee threatened to mail anthrax to his old office building in downtown Chicago.
You interview the 2 sick people from Milwaukee to find that neither of them had been in or around any government building in Chicago in the 2 weeks before getting sick.
Definition

Bioterrorism
A bioterrorism attack is a deliberate release of viruses, bacteria, or other germs (agents) used to cause sickness or death in people, animals, or plants. Anthrax can be released quietly and without anyone knowing. Bioterrorists may send packages or envelopes that contain harmful germs, like in 2001, when anthrax was added to a powder and deliberately spread through the mail.
Anthrax is one of the most likely agents to be used in a biological attack. It only takes a small amount of anthrax to infect a large number of people.
3. How do you think the people in Milwaukee got infected with anthrax?
Answer 1: Anthrax was mailed from Chicago to Milwaukee
[Incorrect]
You're jumping to conclusions. You haven't even determined that any anthrax was ever actually mailed to the building.
All clues are pointing to something else. Keep searching!
Answer 2: The sick people in Milwaukee visited the government building in Chicago
[Incorrect]
No. You interviewed the 2 sick people from Milwaukee and found out they had not been in or near any government buildings in Chicago for the 2 weeks before getting sick. Besides, you haven't determined that anthrax was ever actually mailed to the building in the first place.
Other clues are pointing to something else. But, what could it be?
Answer 3: More evidence is needed before we can determine if the bioterrorism threat is real
[Correct]
That's correct. We need more evidence and lab tests before we can determine if this bioterrorism threat is real or a hoax. There are sick people 100 miles away near Milwaukee, Wisconsin. And remember, these sick people told you they had not been in or near the government buildings in Chicago.
Other clues are pointing to something else. But, what could it be?
Clue 4

After intense questioning, testing at government buildings, and lab tests, authorities find no evidence of anthrax. The bioterror threat was a hoax.
Meanwhile, the results of the blood tests you sent to the public health labs indicate a need for further testing, so you send them away to special labs at the Centers for Disease Control and Prevention (CDC). The results from CDC labs show Bacillus anthracis, the bacteria that causes anthrax!
Based on this finding and the patients' symptoms, the doctors diagnose each patient with inhalation anthrax. You tell all the patients to begin treatment immediately. But if it's anthrax after all, does that mean the police missed something?
Cases

Since you've ruled out the government building as the place where all of the sick people came in contact with anthrax, you review the attack rates and interviews again. You find that everyone who's tested positive for anthrax also attended a music event at the same Chicago concert hall where Zeke held his music workshop.
Health Tips

Treatment of anthrax
Someone with symptoms of anthrax should get medical treatment as quickly as possible to have the best chances for a full recovery. Doctors will use several antibiotics that work best for treating anthrax. They will also consider which antibiotics are best for a patient based on his or her medical history.
Prevention of anthrax
Antibiotics can also be used to prevent anthrax from developing in people who have been exposed but have not yet developed symptoms. Anthrax spores in a person's body typically take 1 to 6 days to be "activated" - to start releasing their toxins - but some spores can take more than a month before they do so. That's why people who have been exposed to anthrax must take antibiotics for 60 days - to ensure anthrax is no longer in their bodies.
Definition

Inhalation anthrax
If a person breathes in anthrax, they can get inhalation anthrax. When anthrax germs are inside your body, they start to grow and multiply. This could happen quickly or it could take a long time. After the anthrax starts to grow, it releases toxins - or poisons - that will attack your body and make you sicker and sicker.
Early symptoms of inhalation anthrax are much like symptoms of the flu - fever/chills, cough, nausea or vomiting. Other symptoms may include:
- Passing out
- Confusion
- Dizziness
- Trouble breathing
- Chest pain
- Headache
- Sweats (often drenching)
- Extreme tiredness
- Fatigue
- Body aches
4. What do you think started the outbreak?
Answer 1: A release of anthrax at the music event
[Correct]
Yes, it is very likely that the release of anthrax occurred at the music event. Maybe something or someone at the music event had been contaminated with anthrax.
Keep looking to find out exactly what happened.
Answer 2: A person at the workshop had contracted anthrax and was still contagious
[Incorrect]
No. Remember, anthrax can't be passed from one person to another the way cold or flu can be.
It's more likely that something or someone at the music event had been contaminated with anthrax.
Keep looking to find out exactly what happened!
Answer 3: Someone in the workshop had received anthrax in the mail
[Incorrect]
Remember, the authorities had already ruled bioterrorism out. There's no evidence that the suspected terrorist ever had access to anthrax.
Keep looking to find out exactly what happened!
Clue 5

All of the people who became sick in this outbreak were together on the day of the workshop. You're now convinced that the workshop is where anthrax was released, though you still aren't sure how.
While you try to figure that out, there's something else you need to do. The 35 workshop participants who are healthy must be given antibiotics to prevent them from becoming sick (this is called post-exposure prophylaxis), since they may have been exposed to anthrax.
You're one step away from finding out what caused the outbreak!
Cases

You talk to Zeke again. He remembers the drum maker in Mali was coughing and having trouble taking deep breaths, similar to the symptoms of all the sick people from the music workshop. You investigate further, contacting health authorities in Mali. They tell you that the drum maker passed away shortly after Zeke returned to Chicago.
Zeke also tells you that during the workshop in Chicago, he demonstrated how to make a drum, using goat skins he brought back from Africa.
You decide to go back to the other participants at the workshop to ask about it. Interestingly, most of the sick people report that while Zeke was showing them how to make the drum, they noticed a large amount of dust and particles floating in the air.
Tip

People can get anthrax through contact with infected animals or their products, such as hides or hair. In fact, anthrax used to be called "wool sorters' disease" and was considered a common risk for workers in wool mills, slaughterhouses, and factories that processed animal hides, hair, and bone.
Anthrax is rare in the United States, but outbreaks do occur in wild and domestic animals. Yearly vaccination of animals is recommended in areas that have had anthrax in the past. The disease is most common in parts of Central and South America, sub-Saharan Africa, central and southwestern Asia, southern and Eastern Europe, and the Caribbean.
5. How do you think the anthrax got into the music workshop?
Answer 1: Zeke caught the illness from the drum maker, then spread it to others
[Incorrect]
Sorry, no. Remember, anthrax can't be passed from one person to another the way cold or flu can be.
You conduct tests of the drums Zeke played and the goat skins he used to make drums at the workshop. They're contaminated with anthrax spores! When the drums and skins were shown to Zeke's workshop, spores were released into the air. People who came closest to the drums and skins breathed the spores, making them sick.
The drums and the goat hides he brought back from Mali were not treated effectively with chemicals to kill anthrax spores. Zeke also did not report the goat skins he brought back from Africa to Customs and Border Protection. Because of this, when he returned to the US, it wasn't verified that they had been properly treated to kill anthrax spores.
Answer 2: Spores were on Zeke's clothes, which he'd worn in Mali
[Incorrect]
No. If there were spores on Zeke's clothes, it is unlikely that enough would have come off his clothes to get 14 other people sick. But you're close.
You conduct tests of the drums Zeke played and the goat skins he used to make drums at the workshop. They're contaminated with anthrax spores! When the drums and skins were shown to Zeke's workshop, spores were released into the air. People who came closest to the drums and skins breathed the spores, making them sick.
The drums and the goat hides he brought back from Mali were not treated effectively with chemicals to kill anthrax spores. Zeke also did not report the goat skins he brought back from Africa to Customs and Border Protection. Because of this, when he returned to the US, it wasn't verified that they had been properly treated to kill anthrax spores.
Answer 3: Spores were on the drums and goat skins Zeke brought back from Mali
[Correct]
Yes! You conduct tests of the drums Zeke played and the goat skins he used to make drums at the workshop. They're contaminated with anthrax spores!
When the drums and skins were shown to Zeke's workshop, spores were released into the air. People who came closest to the drums and skins breathed the spores, making them sick.
The drums and the goat hides he brought back from Mali were not treated effectively with chemicals to kill anthrax spores. Zeke also did not report the goat skins he brought back from Africa to Customs and Border Protection. Because of this, when he returned to the US, it wasn't verified that they had been properly treated to kill anthrax spores.
Learn More

Your hard work helped to solve this outbreak!
Although this scenario was not real, there have been several real-life investigations of anthrax illness involving drums made of contaminated animal hides.
Disease Detectives worked in 2006 to determine that a drum maker in Pennsylvania caught inhalation anthrax by working with dried goat hides that had traces of anthrax spores. In 2009, a New Hampshire woman became sick with gastrointestinal anthrax (a very rare form of the disease that causes flu-like symptoms, sore throat, nausea, and diarrhea) after participating in a drumming event. Disease Detectives worked in each of these cases to determine the cause of the outbreak.
Anthrax also has been used as a bioterrorist threat in the United States. In 2001, Disease Detectives helped solve an anthrax terrorist attack which affected many people across the United States.
Note: Several aspects of the original outbreaks and investigations have been altered to fit the format and length of this application.
Back To Top
The Village of Gold

- Number Sick: 1400
- Hospitalizations: 1150
- Deaths: 400
- Location: Nigeria
Your help is needed in a terrible outbreak that's affecting children!
An international group that aids the sick has discovered a horrifying health emergency: more than 100 children in a remote corner of Nigeria have died, and many more are extremely sick.
The sick aren't responding to anti-malaria medicine or antibiotics. They desperately need your help to solve the outbreak!
Clue 1

Doctors Without Borders has been doing some routine health work in northwestern Nigeria. This is a remote area, with dusty and mountainous terrain. People here are very poor. Most are farmers or miners who dig for precious minerals like gold.
The doctors discovered that 3 villages are in the midst of a horrible outbreak: 118 children (many of them younger than 5) are dead. Many more are sick, with symptoms including vomiting, abdominal pain, headache, and convulsions (sudden, violent, uncontrollable shaking).
1. It could take days to reach the village. What should you do?
Answer 1: Recommend that Nigerian authorities take a closer look first
[Incorrect]
This is a major health crisis. With so many kids dead and more dying every day, there's no time for delay.
Grab your passport and suitcase, get your vaccinations, and line up your visas and security clearances from the American and Nigerian embassies. It's time to fly to Nigeria!
Answer 2: Closely monitor the situation from CDC headquarters in Atlanta
[Incorrect]
Sorry, but doing this slowly and deliberately won't fly this time. It's you who needs to fly, to Nigeria, right now!
This is a major health crisis. With so many kids dead and more dying every day, there's no time for delay.
Grab your passport and suitcase, get your vaccinations, and line up your visas and security clearances from the American and Nigerian embassies. It's time to solve the outbreak!
Answer 3: Go to Nigeria immediately
[Correct]
This is a major health crisis. With so many kids dead and more dying every day, there's no time for delay.
So grab your passport and suitcase, get your vaccinations, and line up your visas and security clearances from the American and Nigerian embassies. It's time to fly to Nigeria!
Clue 2

It's a major undertaking, but you and your team make it to the villages. There you find a terrible scene. Outside the villages is a graveyard with more than 100 newly dug, small graves.
Parents of children who died tell you that their kids had seizures, and you see that many of the sick kids are still having seizures. Others are listless, and some have gone blind.
Most of the sick are children. There are some sick adults, too, but they aren't as bad off, and no adults have died.
Notes

Just reaching the villages was a huge challenge: after a long flight, you then had to drive for 2 days across hundreds of miles of dirt roads, over mountains, while hauling a huge amount of gear. You had medical equipment, environmental testing equipment, computers, large batteries for power, and more.
GPS doesn't work out here, so simply finding the villages was an adventure. Sometimes you had to follow puzzling directions that people offered, like "turn left at the river."
You also need a team of security guards, and you work closely with the local emir (religious leader) so that people know you're here to help.
Cases

There are 3 villages in this area. Each village consists of open-air dwellings with dirt floors, separated by low walls. People from extended families live in compounds (a number of dwellings close together, enclosed by a common wall).
Some of the compounds have their own well for drinking water, but people in other compounds use a common village well.
A few of the villagers begin to wonder if the drinking water is contaminated.
2. What should you do next?
Answer 1: Take samples of the sick people's blood immediately
[Incorrect]
Because this is such an emergency, yes, it seems like a good idea to rush in and take those samples right away. But that could backfire on you.
This is a traditional Muslim community, and you're an outsider here, coming from another country. You need to earn people's trust and can't assume they'll just go along with whatever you say. The first step is to meet with the village elders, explain what you want to do, and win them over so the villagers will cooperate.
OK, now it's time to get those samples!
Answer 2: Get permission from the village elders, then take the samples
[Correct]
That's right! Because this is an emergency, it may have seemed like a good idea to rush in and take those samples right away. But that could have backfired on you.
This is a traditional Muslim community, and you're an outsider here, coming from another country. You need to earn people's trust and can't assume they'll just go along with whatever you say. So the first step is to meet with the village elders, explain what you want to do, and win them over so the villagers will cooperate.
OK, now it's time to get those samples!
Answer 3: Get everyone away from the villages immediately
[Incorrect]
You still aren't sure how people are getting sick, so moving them to a different area might not help. Plus, relocating 3 villages isn't exactly an easy thing to do, and it certainly isn't a good way for an outsider like you to win the villagers' trust!
It's important to get blood samples, but the thing to do first is to get the permission of the village elders. Because this is a very traditional community, earning that approval first will make the rest of your job a bit easier.
More kids are dying, you need to hurry!
Clue 3

Now that you have the village elders' permission, you take blood tests of all the sick people in the village, including children under 5.
While doing your research in the villages, you notice that in many cases entire families are involved in mining. Many children work in the mines and even very young children help their mothers break down rocks or dry the ore in their own family compound.
The blood tests show that the sick children have extremely high levels of lead in their blood, which means they have lead poisoning, a serious and often fatal condition. The sick children need immediate treatment, but you only have a limited amount of medicine.
Cases

As part of the investigation, you discover that 1 of the 3 villages is not involved in gold mining and has a much lower rate of sickness than the other 2 villages. This leads you to suspect that the mining is to blame for the lead poisoning, since it releases so much toxic lead dust into the air.
The people who mine gold don't have sophisticated machinery or protective equipment. They collect large rocks and then crush them (with simple tools or their hands) without wearing facemasks, goggles, or gloves. And they don't do this work solely in a mine, either. Much of the work is done in the village, and some is even done in family compounds, by mothers and children.
You try to talk to the head of each household to find out whether the family members have been mining.
Definition

What is lead poisoning?
Lead poisoning is a serious condition that occurs when lead builds up in the body. Even small amounts of lead can cause severe health problems. At very high levels, lead poisoning can be fatal.
Children under the age of 5 are especially vulnerable to lead poisoning because it can severely affect mental and physical development. Young children are also more likely to get lead poisoning because they're often on the ground and exposed to lead-contaminated soil and dust. They tend to put their hands in their mouth and nose, increasing their chances of infection.
Lead-based paint and lead-contaminated dust in older buildings are the most common sources of lead poisoning in children in the United States. Other sources include contaminated air, water, and soil.
3. You have a limited amount of medicine. Whom should you give it to first?
Answer 1: Children who are least sick and have the best chance of recovery
[Incorrect]
It's an awful choice to face, but in cases like this where there are so many sick and there is so little medicine, the best thing to do is focus on those who are having seizures or are in a coma. You simply don't have the ability to give medicine to every person who's been infected with lead at this point.
Answer 2: Children who are the most sick and have seizures or in a coma
[Correct]
That's right. It's an awful choice to face, but in cases like this where there are so many sick and such little medicine, the best thing to do is focus on those children who are the most sick.
Answer 3: Children under 5 years old, beginning with the youngest
[Incorrect]
It's an awful choice to face, but in cases like this where there are so many sick and a limited amount of medicine, the best thing to do is focus on those who are the most sick. You're right in realizing that all the children under the age of 5 are at risk, but for now you need to treat those who are having seizures or are in a coma.
Clue 4

You start treating the sickest kids with chelation therapy to help them recover.
You've learned that two-thirds of the families in the 2 sicker villages are mining gold. The mining could be responsible for the deaths, but because the villagers are so poor and this is the only way they can make money, they don't want to stop mining.
You need to determine what parts of mining put the villagers at highest risk. When interviewing the families, you ask about the types of mining activities they do. You need to figure out which of these activities are most dangerous.
Definition

What is chelation therapy?
Chelation therapy is a treatment used to address lead poisoning. In Nigeria, doctors used an oral medicine (Succimer), a chemical that binds, or attaches, to heavy metals such as iron, lead, mercury, cadmium, and zinc. The body then removes the chemicals through urination.
Children treated with chelation therapy receive it over the course of many weeks. Children often need more than one dose of chelation especially if their blood lead levels are very high.
Chelation therapy saves lives. The deaths from lead poisoning stop almost immediately as soon as the medicine becomes available. However, it doesn't reverse any damage that has already been done to the child's brain. Some children are blind, have paralysis or major seizure disorders that could be permanent.
Data

There are several steps to mining the gold. Some people break the rocks into smaller gravel, some grind the rocks into a fine powder, some wash and dry the ore powder to separate the gold out, and some use heat to vaporize the mercury out.
To figure out which steps are most dangerous, you have a talk with mothers who have healthy children as well as mothers who have sick children. In all, you gather data about 52 healthy kids and 50 sick kids. Then, you ask the parents about each mining activity they do so you can calculate the "attack rate" for each activity.
| Attack Rate | = | the number of people who participated in an activity and are sick |
| the total number of people who participated in an activity |
4. Based on your data, which children are most likely to get lead poisoning?
Answer 1: Kids whose parents grind rocks into powder, releasing toxic dust
[Incorrect]
You're right that parents who grind rocks into powder are very likely to have sick kids. The attack rate for that is 73%, the highest of any activity.
But it's even worse if parents do 3 or 4 different mining activities. Their kids have an attack rate of 85%!
Keep going to solve the outbreak!
Answer 2: Kids whose parents wash and dry ore
[Incorrect]
You actually chose the activity with one of the lowest attack rates. It's still pretty bad at 59%, but some of the other activities are even worse.
If parents do 3 or 4 different mining activities, their kids have an attack rate of 85%!
Keep going to solve the outbreak!
Answer 3: Kids whose parents perform the most mining activities
[Correct]
You're right: kids whose parents perform 3 or 4 different mining activities have the highest attack rate (85%). The data shows you that all of the mining activities are unhealthy, and that each additional activity makes it even worse for the kids.
Keep going to solve the outbreak!
Clue 5

Four weeks after arriving in the villages, you've given chelation therapy to the sickest kids younger than 5. Most of them have improved, though many may still have permanent disabilities. Teams of Nigerian workers and environmental specialists thought it was best to remove the top layer of contaminated earth from the villages to reduce the number of people who get sick, so it was removed and buried far outside the village. They had to hurry, because the rainy season is coming, and such work will be impossible then.
You've been working hard to educate the miners about the risks of this kind of mining. You tell them not to mine from inside their own compounds. They should always keep their living areas free of mining activities.
Still, they don't have good protective equipment. And even when they follow your advice, most of the miners come home covered in dust, tracking the dust when they walk to and from the village.
Data

You've kept careful track of the number of cases since the epidemic started by using an epi curve. An epi curve shows how an outbreak changes over time. It includes:
- Date when a person became sick.
- Number of people who became sick on each day.
Epi curves are updated as new data come in, so they are always changing. The shape of the curve can provide clues about the possible source of an outbreak.
Learn how to read an epi curve.
Health Tips

In this outbreak, lead dust from the mines was to blame. However, in the US, when children have high blood lead levels, it's usually because of lead-based paint (which was banned from use in housing in 1978) and lead-contaminated dust. To avoid lead poisoning in the US, follow these tips:
- Make sure children do not have access to peeling paint or chewable surfaces painted with lead-based paint.
- Regularly wash children's hands and toys. Hands and toys can become contaminated from household dust or exterior soil. Both are known lead sources.
- Create barriers between living/play areas and lead sources.
- Prevent children from playing in bare soil; if possible, provide them with sandboxes.
- Pregnant women and children should not be present in housing built before 1978 that is undergoing renovation. They should not participate in activities that disturb old paint or in cleaning up paint debris after work is completed.
- Household dust is a major source of lead, so parents should wet-mop floors and wet-wipe horizontal surfaces every 2-3 weeks.
5. Based on the epi curve, which of the following do you think is happening?
Answer 1: The epidemic is better, but hasn't gone away. The treatment hasn't worked
[Incorrect]
Not quite. The epi curve shows you that the number of sick has dropped quite a bit since you started chelation therapy and environmental repairs.
It's good that most families have stopped mining from inside their compounds. But the rate of illness is still way too high. What's likely happening is that miners are returning home covered in dust, which then infects their children. And even though the deaths have slowed down, the children are still being exposed to dangerous levels of lead, which can leave them with major handicaps such as blindness, spastic paralysis, seizure disorders, and mental retardation.
You did great work and helped solve the outbreak. But this is one case that, unfortunately, still hasn't been resolved. New cases are still appearing and will continue to appear until miners change their behaviors and environmental repairs can be completed.
Answer 2: The epidemic is better, but miners are still getting too much lead near their kids
[Correct]
That's right. The epi curve shows you that the number of sick has dropped quite a bit since you started chelation therapy and environmental repairs, but the villages are still facing a lead poisoning outbreak.
It's good that most families have stopped mining from inside their compounds. But the rate of illness is still way too high. What's likely happening is that miners are returning home covered in dust, which then infects their children. And even though the deaths have slowed down, the children are still being exposed to dangerous levels of lead, which can leave them with major handicaps.
You did great work and helped solve the outbreak. But this is one case that, unfortunately, still hasn't been resolved. New cases are still appearing and will continue to appear until miners change their behaviors and environmental repairs can be completed.
Answer 3: The epidemic appears to be ending
[Incorrect]
Sorry, but no. The epi curve shows you that the number of sick has dropped , but the villages are still facing a lead poisoning outbreak.
It's good that most families have stopped mining from inside their compounds. But the rate of illness is still way too high. What's likely happening is that miners are returning home covered in dust, which then infects their children. And even though the deaths have slowed down, the children are still being exposed to dangerous levels of lead, which can leave them with major handicaps.
You did great work and helped solve the outbreak. But this is one case that, unfortunately, still hasn't been resolved. New cases are still appearing and will continue to appear until miners change their behaviors and environmental repairs can be completed.
Learn More

The true story behind the outbreak
This fictional scenario is based on a real-life outbreak that is still claiming lives in Nigeria.
In May 2010, Doctors Without Borders contacted the CDC and other groups after it discovered that a staggering number of children were dying in villages in a remote part of Zamfara Province. CDC scientists raced to the scene, where tests quickly showed that the children (and some adults) had severe lead poisoning. The cause of the outbreak was traced to what is called "artisanal gold mining," or small-scale mining using primitive tools and little, if any, protective equipment.
Scientists have called this the worst case of mass lead poisoning in modern times.
Conditions were especially bad because much of the mining was done in family compounds, where children were exposed to huge amounts of lead through dust and other means. CDC, Nigerian authorities, Doctors Without Borders, and other organizations have worked hard to provide chelation therapy and to repair the environment by removing contaminated soil. But because much of the mining activities continue, the outbreak has not ended.
Note: Aspects of the original outbreaks and investigations have been altered to fit the format and length of this application.
Back To Top
The Queens Killer

- Number Sick: 62
- Hospitalizations: 59
- Deaths: 7
- Location: US (1 State)
We're sending you back in time a bit for this one.
It's 1999, and the New York City Department of Health calls you when 11 people in Queens come down with a mysterious illness. They all had been healthy until very recently, when they suddenly got bad fever with headaches, neck stiffness, and disorientation (confusion). Some of them are partially paralyzed.
Six are in the hospital, and 2 are in critical condition! Doctors suspect a virus, but what is it?
Clue 1

It's late August, and New York City is baking in a heat wave. Fred is a retired US veteran in his 70s and quite active for his age. He's an avid gardener and likes going for long walks every day.
Fred started feeling sick 5 days ago, and now he's in the hospital with a high fever, bad headache, and extreme muscle weakness. He's having so much trouble breathing that he's been put on a ventilator.
His doctor conducts tests that suggest Fred has a virus, although it's not yet clear what kind of virus. The next day, 2 people in their 60s with similar symptoms are admitted to the hospital.
Cases

New York City's Department of Health has reached out to all local hospitals to see if anyone else has been admitted with high fevers and headaches. As it turns out, a total of 11 people are hospitalized with similar symptoms, and they all live in northern Queens. Of the 11 cases, 9 live in the same general neighborhood, and the other 2 live only a short distance away.
Overall, 8 of the 11 are 55 years or older. Most of them had been relatively healthy until getting this sickness, although 2 had recently returned from hospital stays (one after having hip replacement surgery and the other after having a skin lesion removed).
1. Why do you think only older people are getting sick?
Answer 1: They have weaker immune systems
[Incorrect]
On the one hand, it's true that older people have weaker immune systems, so sometimes they're more likely to catch certain illnesses. But you don't have any reason to suspect that age has anything to do with this outbreak. In fact, you don't have much information at all. That's the problem!
You need to talk to the sick people and find out more about what symptoms they have, what they've been doing lately, whether they know each other, and what they might have in common.
Keep going before it spreads!
Answer 2: They're catching it from each other
[Incorrect]
On the one hand, it's certainly suspicious that all of the sick people live in the same part of town. But you still don't have any reason to suspect that this is a contagious illness. In fact, you don't have much information at all. That's the problem!
You need to talk to the sick people and find out more about what symptoms they have, what they've been doing lately, whether they know each other, and what they might have in common.
Keep going before it spreads!
Answer 3: It's too soon to tell
[Correct]
On the one hand, it's true that older people have weaker immune systems, and it's certainly suspicious that all of the sick people live in the same part of town. But you don't have any evidence to support the idea that this is a contagious illness or that older people are more likely to catch it. In fact, you don't have much information at all. That's the problem!
You need to talk to the sick people and find out more about what symptoms they have, what they've been doing lately, whether they know each other, and what they might have in common.
Keep going before it spreads!
Clue 2

Sadly, Fred dies in the hospital, as does another sick person. Three others are in critical condition, with very high fever, headache, disorientation (confusion), muscle weakness, and convulsions (sudden, violent, uncontrollable shaking).
The outbreak is getting worse. There are now 17 sick people, all of whom live in northern Queens.
You talk to the sick people and their relatives to find out what they had been doing in the days before they got sick. You visit their homes and investigate their environments, searching for clues.
Blood samples from the patients are sent to the New York State Health Department laboratory where they will run tests to see if they can identify what may be making these people sick.
Data

You visit with the sick people and their families, asking questions like:
- When did you first get sick?
- Have you traveled much recently?
- What have you had to eat in the last 5 days?
- Have you taken any drugs in the last 5 days? If so, what?
- What kinds of animals have you been around lately?
- Do you spend a lot of time outside? How about in the evening?
- Are any of your friends or relatives sick, too?
Notes

You've been hearing reports that an unusual number of dead crows are being found in the city. You don't have any reason to believe that this is connected to your investigation, because none of the sick people mention having been near birds lately.
Still, you make a point of staying in touch with local veterinarians who are trying to find out why the birds died.
2. Based on clues and data collected, what should you investigate next?
Answer 1: Diseases spread by birds
[Incorrect]
Sorry, but there's no reason to suspect birds at this point. None of the people have mentioned being around birds. Of the sick people, 7 own pets, and only 3 reported that they have been around other animals lately.
What should make you suspicious is the fact that 15 of the sick people have spent some time outdoors in the evening recently. That means they may have been bitten by mosquitoes, which can spread a variety of diseases.
And if it is being spread by mosquitoes, that means more people could get it very quickly. You need to hurry!
Answer 2: Diseases spread by contagious people
[Incorrect]
Sorry, but there's no reason to suspect that people are catching the illness from other sick people. Only 5 of the sick people know anyone else who is sick.
What should make you suspicious is the fact that 15 of the sick people have recently spent some time outdoors in the evening. That means they may have been bitten by mosquitoes, which can spread a variety of diseases.
And if it is being spread by mosquitoes, that means more people could get it very quickly. You need to hurry!
Answer 3: Diseases spread by mosquitoes
[Correct]
That's right! The fact that 15 of the sick people have recently spent some time outdoors in the evening means that they could have been bitten by mosquitoes, which can spread a variety of diseases.
And if it is being spread by mosquitoes, more people could get it soon. You need to hurry!
Clue 3

Many of the sick people said they'd recently spent time outdoors in the evening (walking or gardening). In talking with the sick people, many confirm that they were bitten by a mosquito in the last week, although others can't quite remember.
This evidence, along with test results from the laboratory that suggest infection with a mosquito-transmitted virus, leads you to believe that the sick people have St. Louis encephalitis, a rare disease that caused another outbreak in New York back in the 1950s.
Bad news: the outbreak is spreading to other areas! You learn that 2 people in the Bronx have what appears to be the same illness, as does someone in Manhattan and someone in Westchester County, north of the Bronx. Two of these people say they've been to Queens recently. And you also get an update about all those dead birds.
Definition

What is St. Louis encephalitis virus?
St. Louis encephalitis virus is transmitted to people by the bite of an infected mosquito. Most people infected with St. Louis encephalitis virus have no apparent illness, but some people do get quite sick. Initial symptoms include:
- Fever
- Headache
- Nausea
- Vomiting
- Tiredness
In rare cases, St. Louis encephalitis virus can kill or cause long-term disability. Severe illness occurs more commonly in older adults.
There is no specific treatment for St. Louis encephalitis virus infection. You can reduce your risk by using insect repellent, wearing protective clothing, and staying indoors in the evening when mosquitoes are most active.
Notes

The reports about dead crows keep coming. The Bronx Zoo calls to say that several of their birds have also died in the last 3 days, including exotic species like Chilean flamingos. But St. Louis encephalitis virus doesn't kill birds, so you assume that this is an unrelated disease.
To be safe, you talk to the team of veterinarians who took lab samples from the dead birds. The cause of death still hasn't been determined, so they're still investigating and will update you with any news.
Health Tips

You can help reduce the number of mosquitoes in outdoor areas where you work and play by draining sources of standing water. These are places where mosquitoes lay their eggs and breed.
- At least once or twice a week, empty water from flower pots, pet food and water dishes, birdbaths, swimming pool covers, kiddie pools, buckets, barrels, and cans.
- Check for clogged rain gutters and clean them out.
- Remove discarded tires and other items that could collect water.
Local mosquito control organizations may also spray insecticides to help further reduce the number of mosquitoes in your neighborhood.
- Support your local community mosquito control programs.
- Use mosquito repellents when you go outdoors.
Note: Vitamin B and "ultrasonic" devices are not effective in preventing mosquito bites.
3. You encourage people to use insect repellents. What else should you do?
Answer 1: Encourage people to empty standing water around their home
[Incorrect]
This is important because mosquitoes - the primary carriers of these diseases - like to breed in stagnant water in ditches, sewage treatment ponds, old tires, clogged gutters, and other sources of standing water but because of the scale and scope of the outbreak, we need to think bigger.
The best step now is to consider spraying insecticides in New York City to control the mosquito population.
Keep going to solve the outbreak!
Answer 2: Spray insecticides in New York City and other areas
[Correct]
That's right! The best step now is to weigh the risks and benefits of spraying insecticides in New York City and surrounding areas. You need to kill off the mosquitoes so they can't infect more people, and the fastest way to do it is by spraying insecticides from trucks or aircrafts to kill adult mosquitoes.
Local town/county mosquito control helps reduce the number of mosquitoes. This is a crucial part of reducing the risk of infection spreading to people. Mosquito control won't get rid of every last mosquito, but combined with repellent use, it can markedly reduce the chances of getting bitten.
Keep going to solve the outbreak!
Answer 3: Encourage people to get vaccinated
[Incorrect]
Yes, a St. Louis encephalitis virus vaccine would be great, if only one existed. But it doesn't.
That means that the best step now is to spray insecticides in New York City and surrounding areas. You need to kill off the mosquitoes before they infect more people.
Keep going to solve the outbreak!
Clue 4

Lab tests on the dead crows show that they have West Nile virus, which has never been found in the Western Hemisphere before!
Knowing this information, you decide to run a different test on the sick people. You learn they don't have St. Louis encephalitis virus after all; they have West Nile virus. West Nile virus is closely related to St. Louis encephalitis virus and causes a similar illness. Since West Nile virus has never been seen in the United States before, the clinical findings and lab tests could be confusing.
Mosquitoes spread West Nile virus to people, but mosquitoes can also spread it to birds. This is why the birds started dying at about the same time that so many people got sick.
Now that you know West Nile virus has come to the United States, you need to take some steps to prevent it from spreading even more!
Definition

What is West Nile virus?
West Nile virus disease is a potentially serious illness spread by mosquitoes. Before 1999, West Nile virus had never been found in the Western Hemisphere. Although it's not clear how the virus came to our area, experts believe West Nile virus disease is now a seasonal epidemic in North America that flares up in the summer and continues into the fall.
People typically get symptoms 4 to 10 days after they are bitten by an infected mosquito. West Nile virus affects everyone differently:
- About 4 in 5 people who are infected will not show any symptoms at all.
- Up to 1 in 5 people who become infected will have symptoms such as fever, headache, body aches, nausea, vomiting, or a rash. Most of the symptoms last for a few days. In some people, fatigue may linger for several weeks.
- A small number of people (about 1 in 150) will develop severe illness. These severe symptoms can include disorientation, coma, convulsions, tremors, and paralysis. These symptoms can last several weeks, and some damage to the brain and nerves may be permanent.
Cases

You work with city, county, and state authorities to set traps that will collect mosquitoes from across the area.
You test the mosquitoes for various viruses, including West Nile virus. You have already begun a carefully targeted program of spraying insecticides in northern Queens and the neighboring south Bronx to cut down on the mosquito population, decreasing the possibility that West Nile virus will spread.
The city sprays insecticides on September 10 (about 3 weeks after you were first called in). The surrounding areas are sprayed on September 14. During the next few days, a few more people get sick. You need to figure out if the insecticides are working or if the illness is still spreading. If it is, you'll need to try something else to stop the spread.
Data

To keep track of the outbreak, you've created an epidemiologic (epi) curve. This shows Disease Detectives how an outbreak changes over time. It includes:
- Date when a person became sick.
- Number of people who became sick on each day.
Epi curves are updated as new data come in, so they are always changing. The shape of the curve can provide clues about the possible source of an outbreak.
Learn how to read an epi curve.
4. Has the spraying of insecticides helped to stop the spread of West Nile virus?
Answer 1: Yes, the outbreak is tapering off
[Correct]
You weren't fooled by the fact that a few people got sick after the spraying of insecticides. That's because West Nile virus has an incubation period of 4-10 days, meaning that those people were probably bitten before the spraying but didn't get symptoms until afterwards.
The bottom line is that the various public health measures you've taken (encouraging people to avoid mosquito bites and spraying insecticides throughout the city and surrounding areas) have been a big help!
Things are looking better in New York City, but how about the rest of the country? There's one step to go to solve the outbreak!
Answer 2: No, because some people still got sick after the spraying
[Incorrect]
On the one hand, you're right that some people did get sick after the spraying of insecticides. But that's not because the spraying didn't work, it's because West Nile virus has an incubation period of 4-10 days. Those people were probably bitten before the spraying but didn't get symptoms until afterwards.
The bottom line is that the various public health measures you've taken (encouraging people to avoid mosquito bites and spraying insecticides throughout the city and surrounding areas) have been a big help! The outbreak appears to be fading in New York.
But how about the rest of the country? There's one step to go to solve the outbreak!
Answer 3: Too soon to tell
[Incorrect]
The epi curve shows us that the outbreak appears to be tapering off. A small number of people got sick after the spraying of insecticides, but that's because West Nile virus has an incubation period of 4-10 days. Those people were probably bitten before the spraying but didn't get symptoms until afterwards.
The bottom line is that the various public health measures you've taken (encouraging people to avoid mosquito bites and spraying insecticides throughout the city and surrounding areas) have been a big help!
Things are looking better in New York City, but how about the rest of the country? There's one step to go to solve the outbreak!
Clue 5

As October begins, a total of 62 people have gotten sick, and 7 have died. All of the people who died were in their 60s or older. Blood tests you've taken of other New Yorkers show that many other people have been infected with the virus, too, but they never showed any symptoms. As has been the case in other countries, only a small percentage of the people infected with West Nile virus actually became sick.
Now that the weather has gotten cooler, mosquitoes have stopped biting people in New York and other northeastern states. We may never know how West Nile virus first came to the United States, but odds are good that it will reappear next spring when mosquitoes return.
Notes

There are a few theories to explain how West Nile virus came to the United States:
- Infected migrating birds brought the virus to New York City.
- Infected birds may have flown to or been transported to the United States.
- Virus-infected mosquitoes may have been brought accidentally to the United States on boats or planes from other countries.
Health Tips

Mosquito bites are more than an itchy pain. They can also spread serious illnesses. Follow these steps to avoid bites:
- Apply insect repellent to exposed skin.
- When weather permits, wear long-sleeved shirts and long pants when outdoors.
- Place mosquito netting over infant carriers when you are outdoors with infants.
- Consider staying indoors at dawn, dusk, and in the early evening, which are peak mosquito-biting times.
- Install or repair window and door screens so that mosquitoes cannot get indoors.
- Spray clothing with repellents containing permethrin, since mosquitoes can bite through thin clothing. Do not apply repellents containing permethrin directly to your skin.
5. What should you do to prevent West Nile virus from spreading across the US?
Answer 1: Spray insecticides across the country
[Incorrect]
You would need a whole lot of insecticide to spray the entire United States. There's no need to go crazy!
The best thing to do at this point is to start educating people across the country about the importance of using insect repellents and taking other steps to avoid mosquito bites.
You'll also want to warn other local and state health departments that West Nile virus will likely spread into new areas. They'll need to start taking steps now for monitoring virus activity in the future, and they should start figuring out how they'll control their mosquito population when the virus reaches them.
Congratulations, your hard work helped solve the outbreak!
Answer 2: Tell people to avoid mosquito bites
[Correct]
That's right! The best thing to do at this point is to start educating people across the country about the importance of using insect repellents and taking other steps to avoid mosquito bites.
You'll also want to warn other local and state health departments that West Nile virus will likely spread into new areas. They'll need to start taking steps now for monitoring virus activity in the future, and they should start figuring out how they'll control their mosquito population when the virus reaches them.
Congratulations, you solved the outbreak!
Answer 3: It's here to stay and there's nothing you can do
[Incorrect]
Hey, what kind of attitude is that? On the one hand, you're right that once West Nile virus made it to the United States, it was here to stay. But there's plenty you can do to make sure we don't have big outbreaks!
The best thing to do at this point is to start educating people across the country about the importance of using insect repellents and taking other steps to avoid mosquito bites.
You'll also want to warn other local and state health departments that West Nile virus will likely spread into new areas. They'll need to start taking steps now for monitoring virus activity in the future, and they should start figuring out how they'll control their mosquito population when the virus reaches them.
Congratulations, your hard work helped solve the outbreak!
Learn More

Your hard work helped solve the outbreak!
Although the characters in this story were not real, this scenario is based on a real outbreak that CDC helped solve. In the summer of 1999, an unusually high number of New Yorkers were hospitalized with encephalitis (inflammation of the brain).
They were originally diagnosed with St. Louis encephalitis, but when a large number of birds started dying in the city, scientists learned that the birds actually had West Nile virus. This was the first time West Nile virus had ever been reported in the United States.
West Nile virus was first discovered in the West Nile District of Uganda in 1937. The virus became recognized as a cause of encephalitis in older patients during an outbreak in Israel in 1957. West Nile virus had been reported in Africa, Europe, and the Middle East, but it wasn't until 1999 that it was found in the Western Hemisphere.
Since then, West Nile virus activity has been reported in people, birds, other animals, or mosquitoes in every state except Alaska and Hawaii.
That means that every spring and summer, there is a possibility that a new outbreak could occur almost anywhere in the continental United States.
The best way to prevent West Nile virus and other mosquito-borne diseases like St. Louis encephalitis virus is to avoid getting mosquito bites by using insect repellents, reducing mosquito breeding sites on your property, supporting local mosquito control programs, and limiting your time outdoors when mosquitoes are present.
Note: Several aspects of the original outbreak and investigation have been altered to fit the format and length of this application.
Back To Top
Case of the Conference Blues

- Number Sick: 37
- Hospitalizations: 5
- Deaths: 1
- Location: US (5 States)
The Georgia state veterinary conference just ended. Dozens of people got sick at the conference, complaining of severe stomach cramps, diarrhea, and fever.
The conference coordinator called the state health department to report that several participants are sick and 2 have been hospitalized. As an officer in the CDC Epidemic Intelligence Service (EIS) stationed at the Georgia Department of Public Health, you have been called in to help.
Clue 1

You are on a mission to stop this outbreak! First, you call the event coordinator and ask for a schedule of events and a list of the conference attendees. The coordinator also gives you contact information for the 15 people she knows who are sick so far.
You begin by attempting to call each sick person to interview them and ask about their symptoms, when they first became sick, which events they attended at the conference, what they ate and drank while at the conference, and if they know of others who are sick. Since you don't have any lab results yet, you need other information to come up with a hypothesis (an idea or theory) about what is making people sick and what these people have in common.
Later, you'll need to find out:
- How many people are sick?
- What are the signs and symptoms of those who are sick?
- When did the illness begin?
- What do the individuals have in common?
- Which events did each of the sick people attend?
Data

You succeed in reaching 10 of the 15 sick people. To better understand how the attendees got sick, you ask about the activities in which they participated since arriving at the conference.
You also ask about the foods they ate, drinks consumed, as well as other activities that might have put them at risk.
You then study the data to see what the sick people have in common.
1. When were the conference attendees exposed to something that made them sick?
Answer 1: At the conference hotel
[Incorrect]
Sorry, while several people who stayed at the hotel are sick, there are a number of sick people who did not stay at the conference hotel.
You're trying to come up with a hypothesis, and since all 10 of the sick people you interviewed attended the Welcome Party, you suspect the Welcome Party is to blame. You'll need to investigate more to confirm or refute your suspicion.
Answer 2: At the welcome party
[Correct]
You're off to a great start!
You suspect the Welcome Party is to blame since all 10 of the people who are sick attended that event, but you need to investigate more to confirm or refute your suspicion.
Answer 3: At the opening session
[Incorrect]
Sorry. While several people who attended the opening session are sick, there are a number of sick people who did not attend the opening session.
You're trying to come up with a hypothesis since the lab results aren't back yet. You suspect the Welcome Party is to blame since all 10 of the people who are sick attended that function, but you need to investigate more to confirm or refute your suspicion.
Clue 2

The good news is most of the people who are sick are starting to get better. In talking with a few of the attendees, you learn that most of them met a lot of new people at the Welcome Party, shook hands, and ate some food.
Based on what they've told you about the party, you suspect something the participants ate at the Welcome Party is causing everyone to be sick. However, in order to be certain you'll need to interview as many of the conference attendees as possible.
The conference organizer tells you the food at the Welcome Party was prepared by a local caterer. You request a copy of the menu served at the Welcome Party in order to develop a list of items to which participants might have been exposed.
Data

During your initial 10 interviews you asked about attendee participation in various conference events, as well as the food items they ate during conference events.
Using the information gathered from the interviews, along with the Welcome Party menu, you create a standard questionnaire that you use to interview as many of the 75 conference attendees as possible. You make sure to ask clear, detailed questions about any items you suspect.
By interviewing most of the 75 conference attendees, you learn that at least 25 people are sick, including your 10 initial interviewees. A few individuals began feeling ill on Monday, with many more reporting symptoms on Tuesday and Wednesday.
You don't have laboratory test results yet, so you define a sick person as someone who attended the conference and began having diarrhea anytime between Jan. 29 through Feb. 5.
To analyze the data, you create an epidemic curve or "epi curve" which shows how an outbreak changes over time. It includes:
- Date when each person became sick.
- Number of people who became sick on each day.
Learn more about an epi curve.
Cases

After conducting these additional interviews, you calculate the attack rate and relative risk of each conference event and each menu item from the Welcome Party.
Based on the interviews, you confirm your initial hypothesis that the illness was associated with the Welcome Party and not any of the other conference events. You therefore focus on determining the attack rates of the food items at the party.
| Attack Rate for the Food Items | = | the number of people who ate a food item and are sick |
| the total number of people who ate a food item |
Notes

Relative risk is a measure of association that helps you to determine which items are most likely responsible for an outbreak. It allows investigators to compare risk factors or exposures among those who are sick, compared with those who are not.
| Relative risk | = | the attack rate for people who were exposed to the item |
| the attack rate for those who were not exposed |
Since you have identified the Welcome Party as the source of illness, you now focus on the relative risk of the food items served at the party.
2. What do you think is the likely source of the outbreak?
Answer 1: Chicken tenders
[Incorrect]
No need to be "chicken" to eat the chicken tenders! However, you should watch out for the spinach dip and veggie lasagna! These foods have the highest attack rates and elevated relative risks.
Maybe there's a common ingredient in these 2 dishes that is to blame?
Keep working to solve the outbreak.
Answer 2: Spinach dip
[Correct]
It does look like the spinach dip had a high attack rate and an elevated relative risk, but so did the veggie lasagna.
Maybe there's a common ingredient in these 2 dishes that is to blame?
Keep working to solve the outbreak.
Answer 3: More than one of the food items
[Correct]
The attack rates and relative risks for the spinach dip and veggie lasagna are very suspicious. Perhaps there's a common ingredient in these 2 dishes that is to blame?
Keep working to solve the outbreak.
Clue 3

Initial laboratory results are back and show that the outbreak is likely due to E. coli O157. The state health department has to confirm the results in their lab, but that could take several days.
In the meantime, you ask the caterer for a list of the recipes from the Welcome Party and review the ingredients. You notice that the 2 dishes with the highest relative risks (the spinach dip and veggie lasagna) both had raw spinach leaves added as a garnish after the dishes were cooked; no other dishes used raw spinach and there were no other common ingredients between these 2 dishes. You immediately contact the Food and Drug Administration (FDA) and tell them about your suspicions that raw spinach could be the source of this outbreak.
You don't have any time to waste, so you go visit the caterer. Luckily, you find some unopened bags of fresh spinach that were purchased at the same time as those used to prepare the food for the Welcome Party. Since the spinach is still in the bag, FDA is able to trace the lot numbers for this product to find out where it was grown and bagged.
Definition

What is E. coli?
Escherichia coli (abbreviated as E. coli) are bacteria found in the environment, foods, and intestines of people and animals.
Most E. coli are harmless and actually are an important part of a healthy human intestinal tract. However, some are pathogenic, meaning they can cause illness, either diarrhea or illness outside of the intestinal tract. The types of E. coli that can cause diarrhea can be transmitted through contaminated water or food, through contact with animals or their environments, or when infected people do not wash hands well after going to the bathroom, and the bacteria get from their hands into someone else's mouth.
Some kinds of E. coli cause disease by making a toxin called Shiga toxin. The bacteria that make these toxins are called "Shiga toxin-producing" E. coli, or STEC. The most commonly identified STEC in North America is E. coli O157:H7.
- People infected with E. coli O157:H7 usually get sick within 2 to 8 days (average of 3 to 4 days) after swallowing the organism. Most people develop diarrhea (usually watery and often bloody) and stomach cramps. Most illnesses resolve on their own within 7 days. Some illnesses last longer and can be more severe.
- Hemolytic uremic syndrome (HUS), a type of kidney failure, can begin as the diarrhea is improving. HUS can occur in people of any age but is most common in children under 5 years old and the elderly.
Get tips on how to stay safe.
Health Tips

The best way to protect yourself from an E. coli infection is to:
- Wash your hands thoroughly after using the bathroom or changing diapers and before preparing or eating food. You should also wash your hands after contact with animals or their environments (at farms, petting zoos, fairs, even your own backyard). This is important even if the animals appear healthy because they can still be shedding germs that can make you sick.
- Cook meats thoroughly. Ground beef and meat that has been needle-tenderized should be cooked to a temperature of at least 160°F (70°C). It's best to use a thermometer, as color is not a very reliable indicator of "doneness."
- Avoid raw milk, unpasteurized dairy products (like raw milk soft cheeses), and unpasteurized juices (like fresh apple cider).
- Avoid swallowing water when swimming or playing in lakes, ponds, streams, swimming pools, and backyard "kiddie" pools.
- Prevent cross-contamination in food preparation areas by thoroughly washing hands, counters, cutting boards, and utensils after you touch raw meat.
Notes

What is a Lot Number?
A lot number is an identification (ID) number given to each batch of a product (or subset of a batch). When manufacturers produce a product, they give each batch a unique lot number so that it is possible to track the product, including the ingredients used, the manufacturing plant, and the equipment used to process an item.
Lot numbers help with tracing and may even help you find the specific farm or field where the produce was grown and processed.
3. What would you do next in the investigation?
Answer 1: Test leftover spinach for E. coli O157:H7 and contact the spinach producer
[Correct]
You're exactly right! As you wait for the results, it's a good idea for you to jointly work with FDA to contact the spinach producer and inform them about the investigation.
Before you can determine if the spinach is contaminated, you'll need to rule out things like cross-contamination in the kitchen while the food was being prepared, as well as the possibility that someone who was sick prepared the food.
If the spinach is to blame, the state health department and FDA will work to find out where the spinach was produced, how it was packaged, and where it was distributed. FDA and the state work to collect and analyze records, looking for common producers or suppliers, as well as other companies who received the spinach of concern.
Answer 2: Recommend a recall of spinach by this producer
[Incorrect]
A recall is a bit premature at this point. Before you determine if the spinach is contaminated, you'll need to rule out things like cross-contamination in the kitchen while the food was being prepared, as well as the possibility that someone who was sick prepared the food.
You should work with the state health department and FDA to have the spinach tested for E. coli O157. As you wait for the results, it's a good idea for you to jointly work with FDA to contact the spinach producer and inform them about the investigation.
If the spinach is to blame, the state health department and FDA will work to find out where the spinach was produced, how it was packaged, and where it was distributed. FDA and the state work to collect and analyze records, looking for common producers or suppliers, as well as other companies who received the spinach of concern.
Answer 3: Issue an advisory about E. coli infections linked to spinach
[Incorrect]
Before you determine if the spinach is contaminated, you'll need to rule out things like cross-contamination in the kitchen while the food was being prepared, as well as the possibility that someone who was sick prepared the food.
You should work with the state health department and FDA to have the spinach tested for E. coli O157. As you wait for the results, it's a good idea for you to jointly work with FDA to contact the spinach producer and inform them about the investigation.
If the spinach is to blame, the state health department and FDA will work to find out where the spinach was produced, how it was packaged, and where it was distributed. FDA and the state work to collect and analyze records, looking for common producers or suppliers, as well as other companies who received the spinach of concern.
Clue 4

The results from the state health department are in! The bacterial testing shows the sick people are, in fact, infected with E. coli O157:H7.
The State Public Health Laboratory sends the DNA "fingerprints" to PulseNet (a national network of state and local public health laboratories and federal food regulatory laboratories).
PulseNet scientists at CDC headquarters in Atlanta compare "fingerprints" of this strain of E. coli O157 with the DNA "fingerprints" in the database and find that this particular strain is indistinguishable from that of 12 other cases that have been reported across the country in the last few weeks. You also discover that this strain has never been reported to PulseNet before now.
Cases

In fact, there is already another ongoing investigation of these 12 sick people. You learn from the EIS officer at CDC headquarters that they are already investigating this outbreak. They also tell you that 3 additional people have been hospitalized and 1 person has died.
In total, 37 people are infected with the outbreak strain from 5 different states. Twenty-five people were infected during the conference in Georgia, and another 12 people are spread across the country:
- California: 2
- Georgia: 25
- MIssouri: 2
- Tennessee: 5
- Utah: 3
4. What should you do next?
Answer 1: Shut down the production facility where spinach was packaged
[Incorrect]
We first need to find out if the other 12 people who are sick even ate spinach. If so, then we'll need to track down the point of contamination and that could be anywhere from the field, to the packaging plant, to the distribution center.
You still have more work to do!
Answer 2: Ask FDA to contact the spinach producer to suggest a voluntary recall
[Incorrect]
We first need to find out if the other 12 people who are sick even ate spinach. If so, then we'll need to track down the point of contamination and that could be anywhere from the field, to the packaging plant, to the distribution center.
You still have more work to do!
Answer 3: Determine if the 12 people also ate spinach
[Correct]
You're absolutely right. The next thing you need to do is talk to the 12 additional people who are sick in other states and find out if they ate spinach. If so, then we'll need to track down the point of contamination and that could be anywhere from the field, to the packaging plant, to the distribution center.
You still have more work to do!
Clue 5

Your hunch is right! The initial interviews from the state and local investigators reveal 11 of the 12 other sick people ate spinach, too. To find out if these people ate the same brand of spinach as those at the conference, you need to review the data collected during all of the interviews.
In the meantime, FDA visits the production facility where the spinach used at the conference event is cleaned and bagged. During their visit, FDA officials look at the possible points of contamination (such as dirty wash water, sick employees handling the spinach, or other problems). However, no likely points of contamination are found.
FDA decides to visit the spinach farm. Now this is a "field" investigation!
Data

You review data collected from interviews with each of the 11 additional sick people to find out if they ate the same brand of spinach that made conference attendees sick. You want to learn more about when and where they might have eaten it, including if they ate the spinach at home or in a restaurant. If the spinach was eaten at home, you'll also want to know what brand it was and from where it was purchased.
Based on your data review, you discover all of the people who are sick ate the same brand of spinach as the attendees from the conference. Fortunately, 2 of the individuals still have some of the spinach, so you collect the spinach to check the lot number and test it for E. coli O157:H7.
Not only do the lot numbers match the bags of spinach from the conference caterer, but lab testing of these new bags of spinach finds they were also contaminated with E. coli O157:H7.
Notes

During the visit to the spinach farm, the farm manager is interviewed so data can be collected about the farm and its operations.
The spinach farm is next to a creek. Across the creek, about a quarter a mile away, there is a farm with 300 cows The pastures the cows graze in is a very hilly area that is on higher ground.
There is a well maintained fence to keep the cows out of the fields and away from the creek. The spinach farmer reports that he uses treated well water for his crops, but there has been some flooding in parts of his fields due to recent heavy rains.
Tip

Did you know that cattle are natural carriers of E. coli O157:H7?
Cows do not always carry E. coli O157, but sometimes they do.
Although cows are usually not affected by the bacteria, they can carry it and shed it in their waste, even while appearing healthy. If the bacteria got into the spinach fields, it could contaminate the spinach.
5. What do you think caused the outbreak?
Answer 1: The cows ate the contaminated spinach
[Incorrect]
Because of heavy rains, the cows have been grazing in the pasture across the stream, uphill from the spinach farm. Also, there's a fence that prevents the cows from getting into the creek or the fields. There's no way they could have eaten the spinach.
Cow manure is collected and tests positive for the outbreak strain of E. coli O157. Floods from the rain most likely washed the cows' waste onto the plants closest to the stream (which explains why only 1 lot was infected). The cows are therefore the likely source of the spinach contamination.
You recommend that the spinach farmer improve drainage to avoid flooding from the creek when there is a heavy rain.
Answer 2: The fields were irrigated with contaminated water
[Incorrect]
Because of the proximity to the cattle farm, the farmer doesn't use the water from the stream to irrigate the fields and instead uses treated water from a well.
Cow manure is collected and tests positive for the outbreak strain of E. coli O157. Floods from the rain most likely washed the cows' waste onto the plants closest to the stream (which explains why only 1 lot was infected). The cows are therefore the likely source of the spinach contamination.
You recommend that the spinach farmer improve drainage to avoid flooding when there is a heavy rain.
Answer 3: The flooding washed the cows' waste into the spinach field
[Correct]
The cattle have been grazing in the pasture across the stream, uphill from the spinach farm. Cow manure is collected and tests positive for the outbreak strain of E. coli O157. Floods from the rain most likely washed the cows' waste onto the plants closest to the stream (which explains why only 1 lot was infected). The cows are therefore the likely source of the spinach contamination.
Thanks to the hard work conducted by your team, the state health department, and the FDA, the affected lots were located and recalled, potentially preventing many more people from getting sick. Additionally, the spinach farmer will make changes to improve drainage and help keep the spinach safe in the future.
Your quick thinking and keen detective skills were key to solving this outbreak!
Learn More

This fictional outbreak was based partly on a real-life outbreak of fresh spinach in the US in August and September 2006.
Over the course of this outbreak, 183 people became sick from E. coli O157:H7 in 26 states, 95 people were hospitalized, and 1 person died.
CDC's Disease Detectives partnered with state and local health departments to work diligently to solve this outbreak by interviewing the people who were sick. By doing so, they found that 95% of the people had eaten uncooked, fresh spinach during the 10 days before getting sick. Based on CDC's investigation, the FDA issued an advisory to warn people about eating fresh, bagged spinach.
CDC's National Center for Emerging and Zoonotic Infectious Diseases (NCEZID) aims to prevent disease, disability, and death caused by a wide range of infectious diseases.
Note: Several aspects of the original outbreak and investigation and findings have been altered to fit the format and length of this application.
Back To Top
Sugar Plantation Blues

- Number Sick: 11
- Hospitalizations: 1
- Deaths: 11
- Location: US (1 State)
It's midsummer in Louisiana: hot, humid, and time to harvest sugarcane. Several workers at a sugar plantation are sick with a mysterious illness that's left one man in the hospital. Harvesting sugarcane is a physically demanding job, and the men work in very tough conditions.
Do they just have a bad virus, or is it something they got from working close together in the scorching heat?
Local doctors need your help to solve the outbreak!
Clue 1

The workers reported to the sugar plantation for their first day on July 9. After 2 days on the job, 7 workers went to the doctor complaining of headache, fatigue, and muscle aches. Six of them have fevers. The doctor told them to take some painkillers and get some rest.
A couple of days later, one of those sick workers, a 20-year-old named Jorge, had to be taken to the nearest hospital. His left shoulder and arm were in a lot of pain, and his hand was numb. The manager just thinks his new workers are faking to get out of work, but one doctor thinks it could be a meningitis outbreak.
Notes

The temperature has been over 100 degrees since the beginning of July, and the humidity makes it even worse. Mosquitoes are thick in the air, and venomous snakes slither in the grass. Some of the workers have had to watch out for stray dogs that wander onto the plantation.
The workers share water bottles in the field, and many of them take dips in a nearby lake to cool off after work.
Definition
What is Meningitis?
Meningitis is a disease caused by swelling of the meninges, which are membranes that cover the brain and spinal cord. The swelling is usually a result of an infection of the fluid around the brain and spinal cord.
Meningitis is most often caused by bacteria or viruses. Meningitis also can be caused by physical injury, cancer, certain drugs, or even parasites.
Health Tips

Swimming in warm water (lakes, ponds, and pools) can put you at risk of recreational water illnesses (RWIs). These are caused by germs spread when people swallow or come into contact with contaminated (dirty) water.
RWIs include many different kinds of infections, affecting skin, ears, eyes, digestive systems, and the brain. Diarrhea is the most common symptom of RWIs.
1. What should you do first?
Answer 1: Install mosquito nets in the sleeping quarters
[Incorrect]
You don't have any reason to suspect that mosquitoes are spreading the illness. You need to find out what the patients have in common first.
Keep investigating before it spreads!
Answer 2: Talk to the sick workers
[Correct]
You're right! The first thing to do is get a better idea of what the sick people have in common.
Keep investigating before it spreads!
Answer 3: Test the plantation's lake and drinking water
[Incorrect]
Most recreational water illnesses lead to diarrhea, and none of the sick patients have that. Since one of the doctors suspects meningitis, there may come a time to test the water. But that shouldn't be first on your list.
You need to find out what the patients have in common first.
Keep investigating before it spreads!
Clue 2

Four more workers are sick on July 13, bringing the total to 11. You interview the sick workers and their manager to get more information.
The workers were split into 3 groups on 3 different fields. Some shared water bottles while they worked, and some swam in the lake afterwards. Some of the workers live in the town year-round, but many came from other parts of the state and even other countries.
Most live in cramped apartments, sharing bedrooms. A few sleep in small trailers on the plantation property.
Data

Of the 11 who are sick, 6 recently traveled from another country (4 are from Mexico and 2 are from Guatemala). Jorge, who's from Guatemala, is the only one in the hospital.
Eight of the sick workers have worked on this plantation in past summers, and they don't think the hard work or the heat has anything to do with why they've gotten sick.
2. What activity is most linked to the illness?
Answer 1: Living with people who are sick
[Incorrect]
Sorry, no. It's true that a lot of the sick workers are living with a sick person (7 out of 11). But an even bigger number have worked on the North Field (9 out of 11).
Both of those things lead you to believe that this is a contagious illness. You need to hurry!
Answer 2: Working on the North Field
[Correct]
That's right! The data shows you that people who worked on the North Field were much more likely to get sick.
But why? That's what you need to find out next!
Answer 3: Sharing a water bottle
[Incorrect]
Six of the sick workers shared their water bottle, which is a good way to spread germs. But what most (9) of the workers have in common is that they worked at the North Field.
You need to hurry and figure this out!
Clue 3

Doctors confirm that the other workers just had a bad virus, but Jorge seems to have something worse. Ten of the workers are feeling better on July 20, and have returned to work.
Jorge, however, has gotten worse: one of his eyelids is drooping, he hasn't been able to move his right arm for days, and he's had so much trouble breathing that he's been put on a breathing tube. On July 21, which is 10 days after he first felt sick, he slips into a coma. His symptoms suggest it's something affecting his nerves and brain.
Cases

Based on his symptoms, Jorge's doctors now think that he could have rabies, which is almost always caused by the bite of a rabid animal. There's a small scar on one of his shoulders that could be a bite mark. The doctors run some tests to confirm their suspicion, and you send the lab work to the Centers for Disease Control and Prevention (CDC) headquarters in Atlanta to analyze.
You also talk to a worker named Eduardo, who is from the same town in Guatemala as Jorge. He tells you that they left their town together on July 2, riding buses and trains through Guatemala and Mexico for 4 days. They spent the night in a small town in Texas and made it to the plantation on July 8.
He doesn't remember Jorge saying he'd been bitten by any animals, but he does tell you that there were a lot of stray dogs near the field where they were working.
Definition

What is Rabies?
Rabies is a virus most often spread by the bite of a rabid animal. The vast majority of rabies cases in the US happen in wild animals like raccoons, skunks, bats, and foxes.
The rabies virus infects the brain and nerves. People who get rabies usually have the virus in their bodies for many weeks before they show any symptoms. The early symptoms are like those of many other illnesses: fever, headache, and weakness or discomfort.
Over time, more symptoms show up: confusion, hyperactivity, trouble sleeping, slight or partial paralysis, hallucinations, hypersalivation (increase in saliva), difficulty swallowing, and fear of water. Within days of these symptoms, the person dies. Because there's no cure for rabies, people who have been bitten by a potentially rabid animal, need to seek medical care immediately, before the virus can travel to their brain.
3. How do you think Jorge might have caught rabies?
Answer 1: He was bitten by the dogs near the plantation fields
[Incorrect]
The incubation period for rabies is usually many weeks. Jorge was feeling sick by his second day in Louisiana, so he couldn't have caught it from anything at the plantation.
He likely was bitten by something back home in Guatemala, long before he traveled to the US.
But how do you make sure no one else gets rabies? Keep going!
Answer 2: He was bitten by something during his travels
[Incorrect]
Sorry, but the incubation period for rabies is usually many weeks. Jorge was feeling sick by his second day in Louisiana, so he couldn't have caught it from anything during his travels that week.
He likely was bitten by something back home in Guatemala, long before he traveled north.
But how do you make sure no one else gets rabies? Keep going!
Answer 3: He was bitten by something before traveling
[Correct]
That's right. We still don't know exactly how Jorge got rabies, but we do know that the virus is usually inside an infected person for many weeks before he or she has any symptoms. That means Jorge couldn't have gotten it from something in the US.
He likely was bitten by something back home in Guatemala, long before he traveled north.
But how do you make sure no one else gets rabies? Keep going!
Clue 4

The test results confirm that Jorge has rabies. When you call Jorge's mother in Guatemala, she tells you that he had been bitten by a vampire bat in May. A growing number of people in her town have been getting rabies, she says. Because Jorge's symptoms are so far along, unfortunately, there's little doctors can do to save him. On July 26, he dies in the hospital.
The key to preventing rabies after someone has been bitten is to give a series of shots called post-exposure prophylaxis (PEP) before the person has any symptoms. That means you have another big decision to make.
Cases

There could be more infected people who aren't showing any symptoms yet. Because rabies is a fatal illness, anyone who might be at risk should get the PEP shots as soon as possible.
You know that Jorge traveled for days with Eduardo, lived in an apartment with 3 other people, and worked in the fields with other workers. He even shared his water bottle with some of them. You need to make sure none of these people get sick.
Health Tips

How to prevent rabies:
- Take your pet dogs and cats to the veterinarian regularly and keep them up-to-date on rabies vaccinations.
- Maintain control of your pets: keep cats indoors, and keep your eye on dogs.
- Spay or neuter your pets to help reduce the number of stray, unvaccinated animals.
- Call animal control to remove all stray animals from your neighborhood, since they may be unvaccinated or ill.
- Children are often at greatest risk from rabies, since they're more likely to be bitten by dogs. Keep them away from wild or unfamiliar animals.
- Be especially careful around animals when traveling to other countries, as they don't always have access to PEP.
4. To make sure no one else gets rabies, who should you give PEP shots to?
Answer 1: Everyone who traveled with and worked with Jorge
[Incorrect]
There's no need to go overboard.
Scientists have proven that rabies can be transmitted through a sick person's saliva, for that reason you investigate further and find out the risk of exposure. As rabies is such a dangerous disease, you should give the PEP shots to the workers who shared Jorge's water bottle. You should also give it to health care workers who may have been exposed to some of Jorge's bodily fluids such as tears.
Your work's not done yet. You need to head south!
Answer 2: The workers who shared Jorge's water bottle
[Correct]
That's right. Scientists have proven that rabies can be spread through a sick person's saliva.
You investigate further and find out the risk of exposure. As rabies is such a dangerous disease, you should give the PEP shots to the workers who shared Jorge's water bottle. You should also give it to health care workers who may have been exposed to some of Jorge's bodily fluids such as tears.
Your work's not done yet. You need to head south!
Answer 3: Neither. People don't spread rabies; animals do
[Incorrect]
Not quite. It's true that there have been no documented cases of one person spreading rabies to another person, except for some instances involving transplanted organs and tissues. But scientists have proven that rabies can be spread through a sick person's saliva.
You investigate further and find out the risk of exposure. As rabies is such a dangerous disease, you should give the PEP shots to the workers who shared Jorge's water bottle. You should also give it to health care workers who may have been exposed to some of Jorge's bodily fluids such as tears.
Your work's not done yet. You need to head south!
Clue 5

As you work with health authorities in Guatemala, you learn that Jorge's mother was right: 11 people in his town have come down with rabies in the last 2 years. That's odd, because there had never been any cases in this town before.
The Guatemalan health department invites you to come down and investigate. This is a small village in the mountains, and it's only had electricity for about 2 years. Many of the cows and donkeys on local farms have bat bites, and so do some dogs.
Notes

You study where the vampire bats live and which farm animals have been bitten. You also notice that though the village recently added electric lights down its small roads, people still don't have electricity in their homes. Vampire bats prefer to feed in darkness.
It's possible that the new lights have disturbed the bats' usual patterns, which is why they've started coming to this town. Since the houses are still dark, the bats are flying in and biting people while they sleep.
5. Which of the following should you do?
Answer 1: Encourage people to bat-proof their homes by closing gaps in the roofs
[Correct]
That's right! The best way to prevent rabies is to avoid contact with rabid animals. Since bats have been getting into people's homes at night, you should help them find ways to seal openings into the house.
You were right not to try to kill the local bats, as there's no scientific reason to do this. In fact, because of rabies' long incubation period, most of the bats that were infected have probably already died by now. This means the ones that are still alive have some immunity to rabies. If you killed them off, they'd only be replaced by a new population of bats that would be more likely to get rabies. That's the last thing you want.
And giving PEP shots to every single person in the entire village is a bit too much.
Congratulations, you solved the outbreak!
Answer 2: Offer PEP shots to everyone in the village
[Incorrect]
Nope. Giving PEP shots to every single person in the entire village is a bit too much. Certainly anyone who's been bitten by a vampire bat should get one, and so should anyone who's come into contact with saliva or other body fluids from a rabid animal or a vampire bat. But that's it.
What you should really do is encourage people to fill any holes in the roofs or walls of their homes to prevent bats from getting in.
Your hard work helped solve the outbreak!
Answer 3: Try to control the bat population by applying poison in their caves
[Incorrect]
There's no scientific reason to try to kill the local bats. In fact, because of rabies' long incubation period, most of the bats that were infected have probably already died by now. This means the ones that are still alive have some immunity to rabies. If you killed them off, they'd only be replaced by a new population of bats that would be more likely to get rabies. That's the last thing you want.
What you should do is encourage people to fill any holes in the roofs or walls of their homes to prevent bats from getting in.
Your hard work helped solve the outbreak!
Learn More

Your hard work helped to solve the outbreak!
Although this scenario was not real, it's based on some recent incidents. A young man in Louisiana died from rabies after being bitten weeks earlier by a vampire bat in Mexico. It was the first time someone in the US died from rabies after a vampire bat bite. And it's unlikely to be the last, as vampire bats have been moving north.
In the real outbreak, CDC workers traveled to the worker's home town in Mexico. Because cats and dogs in the town were frequently bitten by vampire bats, health workers from the US and Mexico vaccinated dogs and cats to protect them. Local health workers also took steps to control the vampire bat population.
In another recent case, CDC workers traveled to a village in Peru, deep in the Amazon jungle. The town had never had a rabies case before, but suddenly many people were getting rabies. CDC investigators believe that new electric lights had altered the bats' behavior, and CDC worked with local authorities and the villagers to stop the outbreak.
Rabies is a killer. If you're ever bitten by an animal, see a doctor immediately.
Note: Several aspects of the original outbreaks and investigations have been altered to fit the format and length of this application.
Back To Top
Hiding in Plain Sight

- Number Sick: 1128
- Hospitalizations: 357
- Deaths: 290
- Location: US (10 States)
You might not be able to trust your own eyes on this next outbreak.
It begins with a surprising increase in a rare eye condition. At least, it's supposed to be rare, but it seems to be becoming a lot more common!
A number of people are being infected by a tiny ameba (single-celled living organism) that's causing permanent eye damage. Dozens of people in these states need transplants of their cornea (the transparent, outermost layer of the eye), and many are going blind!
We need your help to solve the outbreak!
Clue 1

Dr. Lee is an ophthalmologist (eye doctor) in Athens, Georgia. He recently noticed that more of his patients were getting a rare disease called Acanthamoeba keratitis (known as "AK"). There wasn't a sudden rise in the number of cases; in fact, the increase was so gradual that he only realized it after several years.
He calls the Georgia Department of Public Health, and it turns out he isn't the only doctor suspecting an increase. Three other doctors have recently called about the same thing. The Department then calls the Centers for Disease Control and Prevention (CDC) and asks you to figure out what's going on, and fast!
Data

Soon after the call from Georgia, New York's Department of Public Health calls you about the same thing. It's strange that two states nearly 1,000 miles from each other could have the same problem. You wonder if AK is increasing around the country, or if this is a false alarm. It's possible that a few doctors just happen to have sicker patients than other doctors.
You decide to gather 6 years of medical records from a sample of eye doctors in Georgia, New York, and 3 other states across the country to see if AK really is becoming more common.
Definition

What is Acanthamoeba keratitis?
Acanthamoeba is a microscopic ameba ("amoeba" is the British spelling) that can cause rare but severe infections of the eye, skin, brain, and spinal cord.
One of the diseases it causes is Acanthamoeba keratitis (AK), an infection of the eye that causes eye pain, redness, sensitivity to light, and the feeling that something is stuck in your eye. AK can permanently damage your vision or cause blindness.
The ameba is found around the world in soil and dust, as well as in water. It lives in the ocean and freshwater lakes and rivers. It can also be found in swimming pools, hot tubs, and drinking water. Most people will be exposed to it during their lifetime, but very few will become sick from it.
1. Based on the data, is the problem getting worse, getting better, or neither?
Answer 1: Getting worse
[Correct]
The problem seems to be getting worse. Although some states have seen more cases than others, the data shows you that there have been more cases each year in each state for at least 6 straight years.
You'll need to act fast. A new person is coming down with it nearly every day!
Answer 2: Getting better
[Incorrect]
The problem is actually getting worse. Although some states have reported more cases than others, the data shows you that there have been more cases each year in each state for at least 6 straight years.
You'll need to act fast. A new person is coming down with it nearly every day!
Answer 3: Neither
[Incorrect]
The problem is actually getting worse. Although some states have seen more cases than others, the data showed you that there have been more cases each year in each state for at least 6 straight years.
You'll need to act fast. A new person is coming down with it nearly every day!
Clue 2

In order to figure out why so many people are getting AK, you need to learn more. You and a team of Epidemic Intelligence Service (EIS) officers take a closer look at the medical records for all the AK case patients, this time expanding to 10 states. This additional work takes some time, but once you've got all the information you have a better sense of what's happening.
It turns out that 97% of the infected people wear contact lenses. For comparison, only 13% of all Americans wear contacts.
Cases

You take a look at the medical records for all 1,128 people with AK in 10 states. A typical example is Justin, a 19-year-old college student in Syracuse, NY, who has been wearing contacts for 2 years. He stays up late and sometimes falls asleep in his contacts. Four months ago his right eye started to feel sore, and it looked red. He started using rewetting drops, but they didn't help.
So he stopped wearing contacts for a few days. He didn't want to spend money on the doctor and was hoping the problem would just go away. Instead, it got worse: his vision became blurry.
He finally saw his doctor a month after the problem started, and the doctor told Justin he had AK. Unfortunately, the infection had gotten so bad that Justin will never have normal vision again unless he has corneal transplant surgery.
Data

Of the 1,128 people with AK:
- 359 (32%) are younger than 20.
- 107 (9%) are age 20-29.
- 115 (10%) are age 30-39.
- 117 (10%) are age 40-49.
- 175 (16%) are age 50-59.
- 255 (23%) are older than 60.
2. What should you do next?
Answer 1: Warn contact lens wearers about their lenses
[Incorrect]
You know that most of the infected people wear contact lenses, but that doesn't necessarily mean that the lenses themselves are to blame. And because you know so little about why this outbreak is happening, you wouldn't know what to warn people about yet.
You need to find out what else the infected people have in common, and fast, before the outbreak gets worse!
Answer 2: Warn contact lens wearers about proper use of rewetting drops
[Incorrect]
We don't have any evidence yet that the use of rewetting drops is related to the outbreak. Remember, Justin started using them after he developed his first symptoms of AK.
You need to find out what else the infected people have in common, and fast, before the outbreak gets worse!
Answer 3: Find out if the infected people have anything else in common
[Correct]
That's right. You know that 97% of the people with AK wear contact lenses, so that's a good start. Now you need to see what else they have in common.
Keep going, before the outbreak gets worse!
Clue 3

You decide to find out what contact lens products the people infected with AK use. There are different brands of lenses, different types of lenses (like soft lenses or hard lenses, extended wear, and disposable), and different types of solutions (like disinfecting solutions and rewetting drops).
You also ask the infected people how they use their lenses. Do they ever forget to take their contacts out at night? Do they wear them for too long before replacing them? Do they ever use expired solution?
You and your EIS team review the data to see what's causing the outbreak.
Data

Of the 1,128 people with AK infection, you interview a sample of 194 people who wear contacts. You also talk to 410 people who wear contacts but don't have infections. In outbreak investigations, we call this second group the "control group."
Each person was asked what they did in the month before becoming infected. The "attack rate" was calculated for each activity.
| Attack Rate | = | the number of people who participated in an activity and have AK |
| the total number of people who participated in an activity |
3. Based on your data, which of the following is most linked to AK?
Answer 1: Using lenses from Manufacturer A
[Incorrect]
A lot of the sick people (96) are using that kind of lens, but so are a lot of healthy people. In fact, the attack rates for people who use them (32%) is the exact same as the attack rate for people who don't. That means it's unlikely to be the problem - it's just a popular kind of lens.
Maybe you should take a closer look at Solution D. Its attack rate of 41% is much greater than the attack rate among people who didn't use that solution (27%).
Let's work harder to solve the outbreak!
Answer 2: Using Solution D
[Correct]
The data tells you that people who use Solution D have an attack rate of 41%, much higher than the 27% attack rate for people who didn't use it. That makes you suspicious that the solution could actually be part of the problem.
Great work, your investigative skills are solid!
Answer 3: Using Rewetting Drops
[Incorrect]
Only 38 of the infected people said they've used rewetting drops, so that can't be the reason so many people are getting AK.
Maybe you should take a closer look at Solution D. Its attack rate of 41% is much greater than the attack rate among people who didn't use that solution (27%).
Let's work harder to solve the outbreak!
Clue 4

Hundreds of people around the country are becoming blind because of AK, and most of them will need surgery to be able to see again. Doctors are alarmed and need to know what's going wrong.
The good news is, you finally have a solid lead! Since you know that many of the people with AK used Solution D, you immediately test the solution for Acanthamoeba.
But it's a dead end. Surprisingly, you don't find the ameba in any of the new bottles you test. Maybe the contact solution isn't to blame. Something else must be causing the increase in AK. Keep investigating!
Cases

When you first looked at the medical records, you noticed that many of the people with AK were either elderly or teenagers, but you weren't sure what that meant.
Then, when talking again to Dr. Lee and some of the other doctors, they mention that Solution D is marketed toward new contact users. In fact, these doctors even give out a free sample of Solution D as part of their "How to Wear and Care For Your Contact Lenses" packets to patients who are first-time contact lens wearers.
You decide to take another look at your data. Interestingly enough, you find that two thirds (66%) of infected people have been wearing contacts for less than 3 years.
Tip

Acanthamoeba is usually present in the water and soil. There are a number of ways people can be exposed to Acanthamoeba, but it's usually through water. You wonder if Acanthamoeba has become more common in the country's tap water over the years.
While you're interviewing people, you find out that a separate team from the environmental health department has been testing, for years, the tap water in some of the states you're studying. Their lab results show that the tap water in those states doesn't have any more Acanthamoeba now than it had in the past 15 years. So, exposure to tap water alone isn't causing these infections.
4. What do you think might be causing this outbreak?
Answer 1: The packets for new patients have bad information in them
[Incorrect]
Because many of the people with AK are new contact users, you're right to be suspicious. But when you read the information packet, you don't see anything wrong.
What's most likely happening is that the new contact wearers are not handling their lenses properly. They may be putting in, taking out, disinfecting, or storing their lenses incorrectly.
You've almost figured it out, only one step to go!
Answer 2: New contact lens wearers aren't taking proper care of their contacts
[Correct]
That's right. What's most likely happening is that the new contact wearers are not handling their lenses properly. They may be putting in, taking out, disinfecting, or storing their lenses incorrectly.
You've almost figured it out, only one step to go!
Answer 3: The organism is getting into Solution D bottles somehow
[Incorrect]
The test results didn't find any amebas in Solution D bottles, so this is not likely to be the reason for the outbreak.
Since you've ruled so many other things out, what's most likely happening is that the new contact wearers are not handling their lenses properly. They may be putting in, taking out, disinfecting, or storing their lenses incorrectly.
You've almost figured it out, only one step to go!
Clue 5

Now it's starting to make sense! You know that 66% of the infected people are new to wearing contact lenses, and sometimes people who are new at something don't quite know how to do it well. Since you also know that Acanthamoeba is usually spread through water, you suspect that perhaps the new contact lens wearers are letting their lenses touch water or aren't taking proper care of them.
You ask the infected people and your control group another series of questions, this time about their daily routine and habits with their contacts.
Data

You ask questions about whether people are doing something that might put them at greater risk of infection, such as:
- Not washing their hands properly before handling their contact lenses.
- "Topping off" their cleaning/disinfecting solution (adding fresh solution to used solution in the contact lens case).
- Storing their contact lenses in water instead of solution.
- Letting water touch their contact lenses at the sink.
- Showering, bathing, or swimming while wearing contact lenses.
Health Tips

Contact lens users should follow these guidelines to avoid infections:
- Remove contact lenses before any activity involving contact with water, such as showering, swimming, or using a hot tub.
- Before handling contact lenses, wash your hands with soap and water, then dry them completely.
- Clean contact lenses according to instructions from your eye care provider and the manufacturer's guidelines.
- Never reuse or "top off" old disinfection solution, or add new solution to old solution in a contact lens case.
- Never use saline solution or rewetting drops to disinfect lenses. Neither solution is an effective or approved disinfectant.
- Clean, rub, and rinse your lenses each time you take them out to remove harmful microbes and residues.
- Store lenses in their proper contact lens case.
- Rub and rinse contact lens cases with contact lens solution (never use tap water), then empty them and leave them open to dry.
- Replace your contact lens case at least once every three months.
- Visit your eye care provider for regular eye examinations.
- See your eye care provider if you have any eye pain or discomfort. Eye infections can be serious.
5. Which of the following is partially responsible for the increase in AK?
Answer 1: Showering or swimming with contact lenses in
[Incorrect]
Washing your face with your lenses in is a bad idea, but the results don't suggest that it's responsible for this outbreak.
It appears that "topping off" the disinfecting solution and storing lenses in water are the two most likely behaviors to lead to AK: they both have attack rates of 50% or greater. This is because Acanthamoeba can grow quickly in the right environment, including your lens case! If water gets into your case, the amebas will grow and multiply so much that they will contaminate the lens, which then infects the eye.
Your hard work helped solve the outbreak!
Answer 2: Failing to cap their solution bottle after use
[Incorrect]
It appears that "topping off" the disinfecting solution and storing lenses in water instead of solution are the two likeliest behaviors to lead to AK: they both have attack rates of 50% or greater.
This is because Acanthamoeba can grow quickly in the right environment, including your lens case! If water gets into your case, the amebas will grow and multiply so much that they will contaminate the lens, which then infects the eye.
Your hard work helped solve the outbreak!
Answer 3: "Topping off" solution
[Correct]
That's right! Topping off the disinfecting solution appears to be closely linked to cases of AK. The other behavior that's closely linked is storing lenses in water instead of solution - both have attack rates greater than 50%.
This is because Acanthamoeba can grow quickly in the right environment, including your lens case! If you top off your solution, the disinfectant in the solution is not as good at preventing the amebas from growing and multiplying. The ameba will contaminate the lens, which then infects the eye.
Congratulations, you solved the outbreak!
Learn More

Your hard work helped solve this outbreak!
Though the characters in this scenario are not real, this was based on the fact that more and more people have been diagnosed with Acanthamoeba keratitis over the last decade. Investigators from the Centers for Disease Control and Prevention have worked with several other federal, state, and local agencies to identify why this is happening.
Because Acanthamoeba is present in the water and soil, it is a normal part of our environment. But certain people are at greatest risk for infection, including people who wear contact lenses but do not follow important steps to keep their lenses clean or safely put them in their eyes. It's extremely important to make sure that water never touches your lenses and that you never top off your disinfecting solutions. Remember that contact lenses are medical devices - treat them that way!
This might not be what you typically think of as an outbreak, since there wasn't one particular source, like a bad piece of food. But it reminds us how our own actions can lead to disease, and if enough people start doing the same action, an outbreak can start.
Note: Aspects of the original outbreaks and investigations have been altered to fit the format and length of this application.
Back To Top
Deadlier than War

- Number Sick: 200
- Hospitalizations: 147
- Deaths: 34
- Location: US (1 State)
You've been called to investigate a deadly illness that's causing a nationwide panic. More than 100 military veterans are sick, some have died, and more people are dying every day.
No one can tell how they got sick or how the illness is spreading. And it's an election year, with the President scheduled to visit the city soon. Local police, and the media, have been on high alert. Is it a new flu outbreak? A terrorist attack?
News reports are creating a scare throughout the country. We need your help fast!
Clue 1

On July 27, a retired Air Force Captain returned home tired and sick after a trip to Philadelphia. Three days later, he was rushed to the hospital with chest pains, fever, and trouble breathing. He soon died.
Within a week, 10 more Pennsylvania veterans have died, and the state Department of Health calls to ask for your help. You and a large team of Epidemic Intelligence Service (EIS) officers race to Philadelphia, where the city is in a panic and all types of theories are being debated. You start gathering data about when people got sick.
Tip

Some of your coworkers are worried this is the start of a new flu epidemic! Older people often get pneumonia from a bad flu, and a few months ago a deadly kind of flu was discovered at a military base only 40 miles from Philadelphia.
Another theory is that it's a terrorist attack, since it's mostly military veterans who are sick. Some people think it could be a rare disease spread by city pigeons, others think it's poisoning from nickel.
Reporters are anxious to know what's happening, and they're following your every move. Well, almost: they're so scared about getting sick themselves that they don't follow you into any hospital rooms.
Data

Currently 151 are sick and 11 have died, though doctors are warning that many others are near death. Many of the sick are older and most are men. Though they live all over Pennsylvania, they were all in Philadelphia during July 21-24. Many of them were at a military veterans' conference.
Most of them have the following symptoms:
- Chest pains
- Fever (as high as 107 degrees)
- Cough
- Pneumonia
To keep track of the data, you make an epidemic curve (epi curve).
Definition

What's an epidemic curve (epi curve)?
An epi curve shows how an outbreak changes over time. It includes:
- Date when each person became sick.
- Number of people who became sick on each day.
Epi curves are updated as new data come in, so they are always changing. The shape of the curve can provide clues about the possible source of an outbreak.
Learn how to read an epi curve.
1. Reporters ask you what's happening. What should you tell them?
Answer 1: "This is the start of a serious outbreak; people should avoid public places"
[Incorrect]
It's important that EIS officers be honest and up-front about what's happening when talking to the media and the public. But it's too soon to warn people about avoiding public places. You don't even know if this outbreak is contagious.
There's a lot of pressure on you this time. You need to hurry!
Answer 2: "We don't know if it's contagious yet, but we'll let you know as soon as we find out"
[Correct]
During outbreaks, EIS officers need to be honest about what's happening when talking to the media and the public. If you don't tell them what's going on, your silence will frighten them even more than the sickness.
You should be honest that you don't have any information about whether it's contagious. But you also need to be calm and reassuring.
There's a lot of pressure on you this time. You need to hurry!
Answer 3: "No comment" - You don't want to start a panic
[Incorrect]
Sorry, but no. During outbreaks, EIS officers need to be honest about what's happening when talking to the media and the public. If you don't tell them what's going on, your silence will frighten them even more than the sickness. That's why you need to be calm and reassuring.
There's a lot of pressure on you this time. You need to hurry!
Clue 2

The pressure on you is building. There are now 200 sick people (147 of them are in the hospital), and 23 more people have died! To stay on top of things, you ask a team of nurses to check in with every hospital in the state daily. You also set up a hotline for people to call with tips and information.
You and a team of EIS officers spread out across the city, and place calls all over the state, to talk to 200 sick people and their families. You ask about their symptoms to make sure they all have the same illness. You also need to find out what they did while in Philadelphia in order to figure out what links them together.
Notes

Since you don't even know what the illness is or how it's spread, you make a list of questions to ask the sick people and their families, asking things like:
- When did you first get sick?
- Where did you stay overnight?
- Did you visit any of the following: the Liberty Bell, Independence Hall, the Museum of Art, the military conference?
- Where did you eat? What did you order? Did you take a bite of anyone else's food? Did you have any condiments (mustard, ketchup, mayonnaise, tartar sauce) on the side?
- Did you drink water or a soda? Did it have ice in it?
- Is anyone else in your family sick?
2. Which of the following is true of the greatest number of sick people?
Answer 1: They stayed in the Deluxe Hotel
[Incorrect]
Close, but not quite. Your data does show that the majority of the sick (56%) stayed at the Deluxe Hotel. But an even greater number (84%) attended the conference, so that's the one thing most of them have in common.
You've still got a lot of work to do, and more people are dying!
Answer 2: They attended the conference
[Correct]
That's right! It's true that most of the sick are older men, and that more of them stayed at the Deluxe Hotel than anywhere else. But the one thing the vast majority of the sick (84%) have in common is that they attended the conference.
You've still got a lot of work to do, and more people are dying!
Answer 3: They are older men
[Incorrect]
Your data does show that many of the sick are older men. But the thing that's even more common among the sick is that most of them (84%) went to the military veterans' conference.
You've still got a lot of work to do, and more people are dying!
Clue 3

Panic is spreading across the country. Major magazines are putting the outbreak on their covers!
You've learned that many of the sick had stayed at the Deluxe Hotel, but, strangely, only one of the hotel's 400 workers got sick.
Your best lead is the military conference, which was actually held at that same hotel. You need to figure out exactly what the sick people did at the conference, which is going to take some detective work. The conference was 4 days long, and people went to different events on different days.
Data

You also need to talk to people who went to the conference but aren't sick. This is harder than it sounds, since no one at the conference kept an attendance list. You and a team of EIS officers have to call veterans' groups all over the state, trying to track people down. After a few days of work, you finally get information on 400 healthy people and 200 sick people.
You need to ask each sick person which events they attended at the conference and calculate the "attack rate" for each event.
| Attack Rate | = | the number of people who participated in an activity and are sick |
| the total number of people who participated in an activity |
3. Which event most likely made people sick?
Answer 1: The lunch on Day 2
[Incorrect]
All that data didn't get us any closer to the source. None of the events seem any likelier than the others to have gotten people sick. We still don't know what started the outbreak.
The public is getting more frightened. We need to hurry!
Answer 2: One of the speeches
[Incorrect]
Sorry, but no. All that data didn't get us any closer to the source. None of the events seem any likelier than the others to have gotten people sick. We still don't know what that started the outbreak.
The public is getting more frightened. We need to hurry!
Answer 3: Too soon to tell
[Correct]
You're right! None of the conference events seem any likelier than the others to have gotten people sick. We still don't know what it was that started the outbreak.
The public is getting more frightened. We need to hurry!
Clue 4

One bit of good news: you haven't turned up any evidence that sick people have spread the illness to anyone else. So at least it doesn't seem to be contagious.
But you still have a lot of unanswered questions. One hotel guest, an airline pilot, got sick even though he was only there for a few hours, taking a nap between flights. A local taxi cab driver who never even entered the building is also sick.
In fact, there are a surprising number of people with the same illness who did not go to the conference but were in the city during those same days. You go back and talk again to these people, and this time you specifically ask about the Deluxe Hotel.
Cases

You find out that all of these people had gone into or at least passed by the Deluxe Hotel on the days of the conference.
Some of them say they went into the hotel to get a drink to cool off from the heat. Others stood near the entrance, where they could rest in the shade and feel the air conditioning. Some only walked on the opposite side of the street, yet they still got sick!
Whatever bacteria or virus you're facing is incredibly powerful. One man tells you that his wife went into the hotel just to use the bathroom. She was there less than 20 minutes, yet she died days later!
4. Where do you think the source of the disease came from?
Answer 1: Water served at the hotel
[Incorrect]
Remember, a number of people who got sick never even set foot in the hotel or drank the water. They only stood near the entrance or walked past it on the street. That means it must have been something in the air, not something they drank.
You're so close. One more clue to solve the outbreak!
Answer 2: The air in and around the hotel
[Correct]
That's right! Some people who got sick never even set foot in the hotel or drank the water. They only stood near the entrance or walked past it on the street. That means it must have been something in the air.
You're so close. One more clue to solve the outbreak!
Answer 3: Someone who worked in the hotel lobby or near the doors
[Incorrect]
Remember, only one hotel worker got sick, and you haven't uncovered any evidence that it's contagious. That means it's unlikely that one person spread it.
The right answer is the air in and around the hotel. That explains why nearly everyone who's sick either went into the hotel, stood near the entrance, or walked past it on the street.
You're so close. One more clue to solve the outbreak!
Clue 5

Weeks and then months go by, and despite all the hard work from you and so many others, you still don't know what caused the outbreak. You don't even know what the illness was! The unsolved mystery drives you crazy.
Then you finally get a break. Working late one night in December (nearly 6 months after the outbreak started) a laboratory scientist on your team reruns some new tests. He sees something he'd missed before: it looks like a new type of bacterium! He and others on the team look through more samples from the sick and see that the unfamiliar bacterium is present in many of these samples, too.
Cases

More research shows that the new bacterium causes an infection of the lungs, a form of pneumonia. Early symptoms of the illness are much like the flu. After a short time (in many cases, a day or two), more severe pneumonia-like symptoms appear. If it isn't treated with the right kind of antibiotics right away, it can kill.
As a result of your discovery, you look at 2 other unsolved outbreaks from recent years and learn that this bacterium was present in those cases, too. You've actually solved 3 outbreaks with one discovery!
Definition

Your team names the new bacterium Legionella, and the disease Legionnaires' disease, after the American Legion conference where the outbreak started.
Additional research shows that Legionella bacteria are found naturally in the environment and grow best in warm water, like the kind found in hot tubs, hot water tanks, cooling towers that air condition large buildings, plumbing systems, and fountains.
People get Legionnaires' disease when they breathe in a mist or vapor (small droplets of water in the air) that has been contaminated with the bacteria. Antibiotics can cure most cases, but some people can die even if they do receive treatment.
5. Based on this new information, what most likely caused the outbreak?
Answer 1: The hotel's air conditioning
[Correct]
That's right! Legionella can grow in the warm water of cooling towers, which are used in the air conditioning systems of large buildings. That explains why people who never even entered the building but stood near it got sick.
Congratulations! You solved this outbreak!
Answer 2: Inhaling steam from the hotel's showers
[Incorrect]
Answer 3: The hotel's hot tub and swimming pool
[Incorrect]
Nope. A number of people who got sick never even set foot in the hotel. That means they didn't weren't swimming in the pool, either.
Because Legionella can grow in the large air conditioning towers of big buildings, that's the most likely explanation of what happened in this outbreak. That would have put the bacteria in the air that everyone in the hotel (and even people standing outside of it) breathed.
Learn More

Your hard work helped solve this outbreak!
This fictional outbreak was based on a real-life deadly outbreak that occurred during a 1976 American Legionnaires conference in Philadelphia.
The real outbreak took dozens of scientists, epidemiologists, and researchers across the country several months to solve. It captured the attention of the nation, with dozens of newspaper headlines, front-page magazine stories, and TV news programs.
It also happened during a Presidential election, just before the Pope made a historic visit to America, and right after the Vietnam War and anti-war protests, so there were many theories about what had caused it.
The discovery of Legionella solved not only the Philadelphia outbreak but a few others as well, such as the Pontiac fever outbreak of 1968.
The day CDC first received the call from Pennsylvania authorities (August 2, 1976) happened to be the first day at EIS for Stephen B. Thacker. He played a major part in solving that outbreak and many others during his distinguished career at CDC. He served many roles over his 37-years with the agency, including Deputy Director. He passed away in 2013.
Today, an estimated 8,000 to 18,000 people are hospitalized with Legionnaires' disease each year in the US. Reported numbers of cases are rising, but CDC is not yet sure why and is still battling outbreaks every year.
Note: Several aspects of the original outbreak and investigation have been altered to fit the format and length of this application.
Back To Top
Connect the Spots

- Number Sick: 14
- Hospitalizations: 6
- Deaths: 0
- Location: US (1 State)
A serious illness with a terrifying rash is popping up all over Wisconsin. Doctors are puzzled because people who don't seem to have anything to do with each other are coming down with it. And no one has any idea what's causing it.
Local health workers need your help figuring out what this disease is and how it's spreading so you can stop this outbreak!
Clue 1

A 7-year-old girl named Cindy has been in serious condition since May 16 with a high fever, headache, swollen glands, and a rash. The rash looks similar to chickenpox with large swollen spots all over the body.
Doctors have run tests for different illnesses like MRSA (Methicillin-resistant Staphylococcus aureus), herpes, or a fungus. The results won't be back for a day or so, but a few doctors actually think the rash looks like smallpox, a deadly disease that was wiped out a few decades ago.
Fears are rising as doctors can't agree and calls are coming in about similar rashes across the state.
Cases

Four new cases have been reported. The most common symptoms are:
- Very high fever
- Rash
- Chills
- Sore throat
- Swollen glands
Some people also have nausea or diarrhea.
The cases are spread across the state. Most of those who have become sick don't know each other, except for one household where 2 people are sick. No one is sure how the illness is spreading.
Definition

What is Smallpox?
Smallpox is a serious, contagious, and sometimes fatal disease. Infected persons get high fevers and raised bumps on their face and body.
Smallpox has been around for thousands of years, but a successful vaccination program finally ended the disease (the last naturally occurring case was in 1977).
After the terrorist attacks on September 11, 2001, however, governments are concerned that terrorists might find a way to use smallpox as a weapon. For this reason, the US government has stockpiled vaccine and an antiviral for smallpox treatment.
1. Which of the following should you NOT do next?
Answer 1: Contact other states to see if they have similar cases
[Incorrect]
Looks like it fooled you - The question asked what you should NOT do.
In this case, you should find out if there are similar cases in other states. You should also find out what the sick people have in common, so you can get a better sense of what is causing this and how people are getting sick.
It's definitely too early to warn schools about a mysterious and potentially contagious rash. You should wait for test results before jumping to any conclusions as you wouldn't want to scare the local schools.
Answer 2: Warn schools about a serious and potentially contagious rash
[Correct]
This was a trick question, but we didn't fool you! The question asked what you should NOT do.
At this point in your investigation, you should find out what the sick people have in common. And it's a good idea to see if there are similar cases in other states, too.
It's definitely too early to warn schools about a mysterious and potentially contagious rash. You should wait for test results before jumping to any conclusions as you wouldn't want to scare the local schools.
Answer 3: Find out what else the sick have in common
[Incorrect]
Looks like it fooled you - The question asked what you should NOT do.
In an outbreak, one of the first things you should do is get as much information as you can about the sick people. You need to find out what they have in common, so you can get a better sense of what the illness is and how they got it.
Because this sounds like an unusual outbreak, it's also a good idea to find out if it's also happening in other states.
It's definitely too early to warn schools about a mysterious and potentially contagious rash. You should wait for test results before jumping to any conclusions as you wouldn't want to scare the local schools.
Clue 2

The good news is that the tests that doctors ran came back negative for chickenpox and other expected illnesses. Doctors are concerned, however, that the rash might be a rare disease and are worried about how quickly it's progressing.
Seven new cases have been reported for a total of 11 people who are sick.
There's no time to waste! You immediately contact the people who are sick and their families to find out what's causing this outbreak.
Data

You've never seen anything like this in Wisconsin before! It's your job to figure out what the mysterious, rare disease is.
You ask the sick people what they've done lately, and interestingly enough, you learn that 2 of the sick just returned from a trip to Costa Rica. They tell you that while on vacation they took a tour of the rainforests and came into contact with several rare and exotic plants and animals.
Most of the people didn't have any serious health problems before this and haven't had any contact with the other sick people. You're still struggling to find the connection between all of these cases.
2. Based on the data, what should you investigate next?
Answer 1: The international travelers and their contact with rare, exotic plants
[Incorrect]
You're correct that the international travel is very suspicious, especially since these world travelers visited very remote areas and came into contact with exotic plants and animals in the rainforest.
However, since the travelers haven't been in contact with the others who are sick, it seems unlikely that this is the key to the puzzle.
You also notice that 9 of the 11 people who are sick either have pets or live on farms with animals, so you decide check into this more as well.
Answer 2: The reason so many children are sick
[Correct]
You're correct, there are an unusual number of children that are sick. But, you also notice that 9 of the 11 people who are sick have pets or live on a farm near animals, so you should probably check into this more as well.
Keep trying to solve the outbreak!
Answer 3: The people who live on farms or have pets
[Correct]
Since 9 out of the 11 people who are sick had some contact with animals, you should definitely check into this more. Even if your suspicions are right, you'll need to figure out why there are 2 sick people who haven't been around animals at all.
Keep trying to solve the outbreak!
Clue 3

You need to act fast! Cindy, the 7-year-old girl, has been in intensive care for several days and is now on a breathing tube because her throat is so inflamed. There are a total of 6 people in the hospital now, 4 of whom are in critical condition.
What's worse, 3 new cases have just been reported. And the scary thing is, there may be more cases out there. Since the disease starts out fairly mild with fever, headache, muscle aches, and exhaustion, there's no telling how many others may be sick, as the rash doesn't appear until 1-3 days after the fever.
Cases

In talking with the 3 new people who are sick, you learn that one of them works at a local pet store, which only makes you more suspicious. Now, you really start to consider that the disease is zoonotic (a disease that can be spread from animals to humans).
You decide to get more information about the types of animals the sick people have come into contact with. During your interviews, many of the sick talk very affectionately about their pets and how they interact with them. This interaction includes kissing, cuddling, and often letting them sleep in their beds.
In the back of your mind, you're still not sure the animals are to blame as there are 2 sick people who haven't had any contact with animals. However, it's the best lead you've got, so you need to follow-up on it.
Data

Of the 14 who are now sick, 12 have been in contact with animals. Many of the sick people have several pets, and others live on farms with many different kinds of livestock.
The couple who vacationed in Costa Rica also came into contact with a vast number of exotic animals (such as red-eyed tree frogs, black iguanas, and howler monkeys) during their trip.
However, you rule out these exotic creatures since the couple hasn't had contact with any of the others who are sick.
3. Based on your findings, what do you think is the source of this outbreak?
Answer 1: Farm animals, such as horses dairy cows, and goats
[Incorrect]
In looking at the data, 12 of the 14 people who are sick have been around a rather unusual pet: a prairie dog. Based on this, you immediately call everyone and ask them about their interactions with prairie dogs and try to figure out how the other 2 patients are connected to this case.
Keep plugging away. You're on the verge of a breakthrough!
Answer 2: Household pets, such as cats, dogs, and hamsters
[Incorrect]
In looking at the data, 12 of the 14 people who are sick have been around a rather unusual pet: a prairie dog. Based on this, you immediately call everyone and ask them about their interactions with prairie dogs and try to figure out how the other 2 patients are connected to this case.
Keep plugging away. You're on the verge of a breakthrough!
Answer 3: Exotic pets, such as ferrets, prairie dogs, and chinchillas
[Correct]
In looking at the data, 12 of the 14 people who are sick have been around a rather unusual pet: a prairie dog. Based on this, you immediately call everyone and ask them about their interactions with prairie dogs and try to figure out how the other 2 patients are connected to this case.
Keep plugging away. You're on the verge of a breakthrough!
Clue 4

You're on a mission to learn more about these pesky prairie dogs. You start by calling Cindy's parents who tell you that they bought the pet at a local flea market on May 1 as a birthday present for Cindy. She named the little guy Scooter and used to play with him every day, until he got sick and died a few weeks later.
Cindy's mom also mentions that Scooter scratched Cindy during her birthday party on May 4, as she distinctly remembers her daughter crying and asking for a bandage.
You have a solid lead! Immediately, you call the rest of the people who are sick.
Cases

In talking to the other families, you discover that everyone, except 2 of the patients, had purchased a pet prairie dog in the last few weeks and that many of the pets seemed sick, almost from the very beginning.
While 2 of the patients didn't come into contact with a prairie dog, their grandson (who is also sick) recently had gotten one as a pet.
One of the families allows you to run tests on their prairie dog. The results tell you that the pets are sick with a disease that's never been found before in the US: monkeypox.
Data

You have a mystery on your hands. You need to find out how the prairie dogs got a disease that's usually found in Africa.
You track one of the prairie dogs with monkeypox back to a local pet store. The owner of the pet shop tells you he purchased several prairie dogs over the last few weeks and gives you the name of the distributor.
The distributor reports that he's made at least 3 deliveries across the entire state in the last month. It's your job to figure out which shipment brought disease into Wisconsin.
Definition

What is Monkeypox?
Monkeypox is a rare viral disease found mostly in Africa. It's typically spread by infected animals that bite or scratch others and can also be spread from person to person through long periods of face-to-face contact.
Symptoms usually appear about 12 days after someone is exposed to the virus. Initial symptoms include fever, headache, muscle aches, and backaches. A few days after the fever appears (approximately 1-3 days), a rash with raised bumps with fluid appears. The illness can be very serious and may last up to 2-4 weeks.
4. Which shipment of prairie dogs do you think was infected with the illness?
Answer 1: The shipment on April 23
[Correct]
You're exactly right! Your keen detective skills helped you to put the pieces together.
To recap, here's what we know: Cindy's parents purchased the prairie dog on May 1 and Cindy was scratched on May 4 at her birthday party. Cindy began to get sick on May 16, which was 12 days after she was scratched, matching the exposure period for monkeypox.
The hardest part of this case is that many of the people who are ill didn't get sick until several days after getting scratched or bitten. By that point, most had forgotten about it, so it took a while to piece everything together.
Answer 2: The shipment on May 2
[Incorrect]
Actually, it looks like the shipment on April 23 is most likely to blame.
To recap, here's what we know: Cindy's parents purchased the prairie dog on May 1 and Cindy was scratched on May 4 at her birthday party. Cindy began to get sick on May 16, which was 12 days after she was scratched, matching the exposure period for monkeypox.
The hardest part of this case is that many of the people who are ill didn't get sick until several days after getting scratched or bitten. By that point, most had forgotten about it, so it took a while to piece everything together.
Answer 3: The shipment on May 8
[Incorrect]
It looks like the shipment on April 23 is most likely to blame.
To recap, here's what we know: Cindy's parents purchased the prairie dog on May 1 and Cindy was scratched on May 4 at her birthday party. Cindy began to get sick on May 16, which was 12 days after she was scratched, matching the exposure period for monkeypox.
The hardest part of this case is that many of the people who are ill didn't get sick until several days after getting scratched or bitten. By that point, most had forgotten about it, so it took a while to piece everything together.
Clue 5

In order to prevent others from getting sick, you need to track down all of the animals that traveled with the prairie dogs to see if other animals are sick as well.
After much work, you're able to find each of the animals. Interestingly enough, you find that one of the Gambian giant rats from the shipment on April 23 died a few days after it arrived at the pet store.
Since the Gambian giant rats were imported from Ghana, you suspect that they may have infected the prairie dogs during the transport. But, there's no way to know for sure until you track the Gambian giant rats back to Africa.
Data

In tracking the Gambian giant rats, you find that there were 6 different types of animals on the flight from Africa in early April.
Once again, you find yourself tracking down exotic animals, but this time they are spread all over the country. You're able to find many still in pet stores, but others have been sold to families or have died.
You order lab work to look for monkeypox virus in the tissues of animals you're lucky enough to find.
5. Which of these animals also may have brought monkeypox into the US?
Answer 1: Gambian sun squirrels
[Incorrect]
Did the name confuse you? In looking at the data, you see that rope squirrels, dormice, and Gambian giant rats tested positive for monkeypox virus. Gambian sun squirrels, however, did not.
The rope squirrels, dormice, and Gambian giant rats must have brought the disease from Ghana to the US. They most likely infected the prairie dogs, which then infected 14 people.
Your hard work helped to save lives!
Answer 2: Rope squirrels
[Correct]
In looking at the data, you see that rope squirrels, dormice, and Gambian giant rats tested positive for monkeypox virus. This means that these animals probably brought the disease from Ghana to the US.
One or more of these animals most likely infected the prairie dogs, which then infected 14 people.
Congratulations, your hard work helped to solve this outbreak and save lives!
Answer 3: African hedge hogs
[Incorrect]
Sorry. In looking at the data, you see that rope squirrels, dormice, and Gambian giant rats tested positive for monkeypox virus. This means that these animals probably brought the disease from Ghana to the US. One or more of them most likely infected the prairie dogs, which then infected 14 people.
Your hard work helped to save lives!
Learn More

Your hard work helped solve this outbreak!
Although this scenario was not real, it's based on an outbreak that started in Wisconsin in the spring of 2003. A number of people came down with a mysterious illness that turned out to be monkeypox, which they'd caught from their new pet prairie dogs.
Investigators from CDC and several other agencies worked together to track down the prairie dogs and the various other animals involved in the shipments that brought the illness to the US. Regulations were passed temporarily banning the shipment of certain animals across state lines, and banning the import of certain animals from Africa.
This was the first time monkeypox was found in the US. Though no one died, many were seriously ill. The transport of new animals into the US needs to be carefully monitored to make sure that foreign illnesses don't cause harm to people and native animals.
Note: Several aspects of the original outbreaks and investigations have been altered to fit the format and length of this application.
Back To Top
Laid Low in the Desert

- Number Sick: 23
- Hospitalizations: 5
- Deaths: 2
- Location: US (1 State)
A strange outbreak seems to have hit a single county in the desert Southwest. A number of people are reporting severe flu-like symptoms. But it's early summer, an unusual time for flu season to kick in. And no other counties are reporting anything similar.
Two adults have died, and a number of children are sick as well. The local doctors and nurses are baffled. They need your help to solve the outbreak before it spreads!
Clue 1

It started when a 9-year-old boy was taken to his doctor. He'd been sick 2 days with a fever of 103 degrees, a cough, headache, and chills. The doctor said it was a bad virus and sent him home to get some rest, take medicine for the fever, and drink lots of fluids. He returned to his doctor the next day with nausea and stomach pain, and was again sent home.
After another 3 days, his doctor checked him in to the hospital with a fever of 106 degrees and trouble breathing. He died hours later. The local department of health calls you after learning that several other people in the same county have similar symptoms.
Cases

According to medical records from the local department of health, of the 25 people who are sick or who died:
- 10 are age 12 and younger.
- 6 are ages 13-19.
- 6 are ages 20-59.
- 3 are 60 and older.
And the sick people are reporting the following symptoms:
- 25 (100%) high fever.
- 22 (88%) chills.
- 21 (84%) headache.
- 13 (52%) muscle aches.
- 10 (40%) rash.
- 3 (12%) nausea or diarrhea.
- 2 (8%) confusion.
- 2 (8%) abdominal pain.
1. What would you do first?
Answer 1: Shut the town down so the illness doesn't spread
[Incorrect]
No. That's a serious move, and one you shouldn't just jump into. First you need to learn more about the sick people and what they have in common.
Keep investigating to find out!
Answer 2: Ask the sick people what else they've been doing lately
[Correct]
You're right! The best move here is to get more information.
It's time to question the sick people, their doctors, and family members, and try to figure out what's happening.
Answer 3: Ask the sick people what they've been eating lately
[Correct]
The data tells you that only 3 sick people (12%) have nausea or diarrhea, and yet these are often the first symptoms of illness caused by food. So while it's always possible the illness could have come through food, it's highly unlikely.
The first thing you should do is interview the sick people about what they've been doing lately, to get a better sense of how they might have caught this illness.
Keep investigating to find out!
Clue 2

Seven days after the first person got sick, 3 more people have checked into the hospital, and a second person has died.
You arrive in the county and start your interviews with the people who are sick, which helps you get detailed information about them: what they do for a living, where they've traveled lately, whether they have pets, and more.
Data

Twenty-five sick people or their family members were interviewed. Of the sick people:
- 20 (80%) have a pet dog or cat that spends time outdoors.
- 12 (48%) regularly play outdoors.
- 6 (24%) work outdoors as landscapers, construction workers, or laborers.
- 5 (20%) have a sick family member.
- 4 (16%) have other health conditions.
- 3 (12%) returned from a trip to Asia in the last week.
2. Based on the information you've gathered, which of the following is most likely true?
Answer 1: The sick people are catching the illness from each other
[Correct]
This actually isn't right, but we'll give you a few points for making a common mistake.
Because so many families are getting sick together, a lot of local doctors have assumed this is a virus they're giving to each other. But only 5 out of 25 (20%) of the sick people have a sick relative. That means plenty of the sick are the only sick member of their family. That seems to show that it isn't very contagious, and maybe it isn't contagious at all.
Keep trying to solve the outbreak!
Answer 2: Someone brought a new disease from out of the country
[Incorrect]
No, the 3 sick people who had left the country told you that they came back to the US within the last week. At that point, the illness was already here in town. The first patient went to the doctor 7 days ago.
The outbreak is getting worse, so keep trying to solve it!
Answer 3: The sick people are getting sick from something outside
[Correct]
It was hard to figure out the data, but you nailed it: Many of the people who are sick either work outdoors, spend a lot of time outside, or have pets that roam around outdoors. Since the sick people don't seem to have anything else in common, this is your best lead yet.
You're getting warmer. Keep going!
Clue 3

It turns out that all of the people who are sick either work outdoors, spend a lot of time outside, or have pets that roam around outdoors. Also, all of them live near woods bordering the desert. This suggests that the culprit lurks somewhere in the dry desert landscape - but what is it?
More people are being hospitalized, and more are developing a rash, particularly the sick children. Unlike chicken pox, this rash isn't itchy. And the patients are a lot sicker than they'd be with chicken pox. You need to hurry!
Cases

Doctors run a number of tests, which the health department sends to a special lab at the Centers for Disease Control and Prevention (CDC). While you wait for the results, you take a closer look at your interview data to see what the sick people have been doing outdoors.
The data shows that a lot of people have used the swimming pool. And when you visit some of the patients' houses, you notice that some of their pet dogs have ticks.
Data

You interview 100 people. Twenty-five of them are sick. The others are not sick, but they participated in the same activities as those that are sick. In outbreak investigations we call these people "controls."
Each person was asked what they did before getting sick. The "attack rate" was calculated for each activity.
| Attack Rate | = | number of people who participated in an activity and are sick |
| total number of people who participated in an activity |
Hint: To find a possible source of the outbreak, look for both a high attack rate for those who participated in an activity and a low attack rate among those who did not participate.
3. What should your next step be?
Answer 1: Give the sick patients medicine aimed at diseases spread by ticks
[Correct]
The answer was small and easy to miss, but you found it! It turns out that one of the tiniest animals around is to blame for the big problems.
You still aren't out of the woods yet. Keep working to solve the outbreak!
Answer 2: Close the public pool
[Incorrect]
It was tempting to blame the pool, since 60% of the sick people had gone swimming. But it's hot out, so a lot of people have been swimming. If the pool was to blame, you'd have more sick people.
The good news is, you're about to get a big piece of the puzzle. Remember those tests you ran on the patients? The results are in from the labs at CDC. Keep going to see what they say!
Answer 3: Perform tests looking for radiation and other problems in the environment
[Incorrect]
Yes, something in "the environment" is to blame, but testing the air and soil won't get you anywhere.
The good news is, you're about to get a big piece of the puzzle. Remember those tests you ran on the patients? The results are in from the labs at CDC. Keep going to see what they say!
Clue 4

Rashes have become more common with patients who have been sick for a few days, especially the kids. That, combined with test results that have come in from CDC, point to a new diagnosis: Rocky Mountain spotted fever (RMSF). Your first step is to put all of the patients on a special antibiotic that can cure RMSF.
RMSF is spread by bites from infected ticks. One of the things that makes RMSF so dangerous is the fact that its early symptoms are so similar to a bad virus, tricking doctors. This is particularly bad because untreated RMSF can be fatal.
Still, there are 2 things that bother you. For starters, only 10 out of 25 (40%) of the patients said they'd been bitten by ticks. And second, RMSF has never been reported in this state before.
Definition

What is Rocky Mountain spotted fever (RMSF)?
RMSF is caused by the bacterium Rickettsia rickettsii and is spread to people who are bitten by infected ticks. Don't be fooled by its name: this disease has struck people who live hundreds of miles from the Rocky Mountains. Typical symptoms include:
- Fever
- Headache
- Stomach pain
- Vomiting
- Muscle pain
- Rash, which often occurs 2-5 days after fever begins.
RMSF can be severe or even deadly if not treated in the first few days of symptoms. The recommended first line treatment for adults and children of all ages is doxycycline, a special antibiotic that's most effective if started before the fifth day of symptoms.
Health Tips

In much of the country, ticks are more likely to bite people and pets in warmer months (April-September). But in warmer parts of the country, they can be a problem year-round. You can protect yourself by:
- Avoiding contact with ticks. Stay out of wooded and bushy areas with high grass and leaves on the ground. Walk in the center of trails.
- Repelling ticks. On skin not covered by clothes, use insect repellents that contain 20% or more DEET (Diethyl-meta-toluamide, the best insect repellent). You should also treat clothing and gear (such as boots and tents) with special products to prevent ticks.
- Finding and removing ticks from your body. Bathe or shower as soon as possible after coming indoors, and use a mirror to do a full-body tick check. If you see a tick, remove it with fine-tipped tweezers by grasping the tick as close to your skin's surface as possible. Pull upward with steady, even pressure - don't twist or jerk. Clean your wound with iodine, rubbing alcohol, or soap and water.
- Check your pets, coats, and day packs. Put clothes in a dryer on high heat for an hour to kill remaining ticks.
4. There's something fishy going on. What do you think it is?
Answer 1: People who have been bitten by ticks are spreading it to others
[Incorrect]
Sorry, only bites from infected ticks can spread RMSF. Doctors are often tricked by RMSF. When doctors see that more than one person in a family is sick, they assume the family has caught a contagious virus or bacteria. Since families often play outside together, or because they may have lots of ticks in their backyard, it's common for more than one person in a family to get RMSF.
Now that we know what we're dealing with, we need to take steps to contain the outbreak!
Answer 2: Some patients didn't realize they'd been bitten by ticks
[Correct]
Correct! Data aren't always as accurate as we'd like. You had asked people if they'd been bitten by ticks, and many had said "No." But they were wrong. They had been bitten!
Tick bites are very small and usually painless. Some people are even bitten by tick larvae, which are as small as the head of a pin.
Now that you know what you're dealing with, you need to take steps to make sure the outbreak doesn't spread!
Answer 3: RMSF doesn't happen in this state - the results must be wrong
[Incorrect]
Every day, we make discoveries that certain diseases exist in places we hadn't expected. What's more, changes in climate could affect the places where insects and animals live.
In this case, it looks like ticks that never carried the RMSF-causing bacteria before are carrying it now. Or maybe there's a new kind of tick in town.
Since we finally know what disease we're dealing with, we need to take steps to make sure the outbreak doesn't spread!
Clue 5

Tests reveal that this outbreak of Rocky Mountain spotted fever has been spread by the brown dog tick (Rhipicephalus sanguineus). This is the first time the brown dog tick has been found to carry RMSF.
Worse, this tick is commonly found across much of the US, and it feeds mostly on dogs.
That means dog owners in other parts of the county could be at risk if the disease spreads to new areas.
The best strategy for protecting residents from RMSF is by keeping brown dog ticks off of dogs and out of people's yards. But what's the best way to do this?
Health Tips

Dogs can easily be bitten by ticks and bring them into your home. Dogs can also get RMSF and die from the disease, just like people. And there's no vaccine to prevent RMSF. The best way to protect your family and your pet is by giving your dog a special collar or other product that prevents ticks.
To reduce the chances that a tick will pass disease to you or your pets:
- Regularly use a collar or other treatment that prevents your dog from getting ticks.
- Check your pets for ticks daily, especially after they spend time outdoors.
- If you find a tick on your dog, remove it right away with tweezers or your gloved hand.
- Ask your veterinarian to do a tick check at each exam.
- Talk to your vet about diseases spread by ticks in your area and ways to prevent them.
- Keep your lawn mown, and cut back at tall weeds so ticks don't have a place to settle.
5. What would you do next to prevent future RMSF cases in this county?
Answer 1: Put a tick collar on every dog in the county and spray every yard
[Correct]
Anti-tick collars or other tick-killing treatments are the best way to keep ticks off of dogs and out of people's homes. It may sound hard to put a collar on every dog in the county (and it is) but that's a good way to go because officials will be able to see which dogs have been treated. You'll have to work carefully with local Animal Control and town residents to pull this off.
And that's not all. You should also encourage residents to spray anti-tick pesticides on their yards. They'll need to do that every few months to kill off this batch of RMSF-carrying brown dog ticks.
Answer 2: Educate residents so they can protect themselves until winter, when the ticks die
[Correct]
We'll give some points for the first part, because telling people how to protect themselves is important. But you'll need to do more than that, and waiting until winter could be dangerous! There's no guarantee the ticks will die in the winter, especially in the warm Southwest. We shouldn't just assume things will get better next year. They may get worse!
The best bet is to make sure that all the dogs in town (even strays) are wearing tick-repelling collars. And you should also spray pesticide on everyone's yards.
Answer 3: Make sure local veterinarians are vaccinating every dog they treat
[Incorrect]
On the one hand, yes, it is good advice to vaccinate dogs against diseases like rabies. But there are no vaccines against RMSF. That's why your first step really should be to make sure every dog in town (even strays) are carrying special tick-repelling collars and that every yard has been treated with pesticide.
Learn More

Your hard work helped solve this outbreak!
Although this scenario was not real, it's based on recent, deadly outbreaks of Rocky Mountain spotted fever in parts of the country that had never faced it before. Since 2010, cases of RMSF have been reported in nearly every state in the US.
Avoid ticks when hiking, camping, and playing in the woods. If you own a pet, make sure they wear an anti-tick collar, and check them regularly when they come in from outside. Pets that are not protected can bring ticks into our yards, homes, and even our beds.
Note: Several aspects of the original outbreaks and investigations have been altered to fit the format and length of this application.
Back To Top
Birthday Party Gone Bad

- Number Sick: 52
- Hospitalizations: 5
- Deaths: 0
- Location: US (1 State)
It all began with a seemingly innocent birthday party at the Community Swim Club.
What is the worst thing that can happen at a 5-year old's birthday party? Sticky fingers? Fights in the bouncy house? Headaches induced by lots of screaming kids? Usually, but after this party, these things would have been a welcome side effect. Instead, the side effects included:
- Tiredness
- Stomach cramps/pain
- Vomiting
- Watery diarrhea that lasted about a week.
Clue 1

The health department gets a report that five children who attended the party have been admitted to a local hospital with severe diarrhea. The next day, a parent calls the local health department to report that her four kids (who all attended the same birthday party) also have severe diarrhea. CDC's team of Epidemic Intelligence Service (EIS) officers, known as "Disease Detectives," is called in to help investigate.
The lead EIS officer asks you to interview the parents of the children. One mother tells you that she heard that the homemade ice cream served at the party had been made with raw eggs, and she suspects foodborne illness.
Tip

If you suspect foodborne illness that is linked to an event (for example, a birthday party) focus on foods that the patients have in common. But keep an open mind about other possible outbreak sources, such as drinks.
Even though foodborne illness might be suspected, there might be other things that are to blame for the outbreak.
1. The lead investigator asks for your opinion. What would you do next?
Answer 1: Ask party guests if they ate cake and ice cream at the party
[Correct]
When investigating an outbreak, it's important to identify everything the patients have in common, including food, drinks, and activities in which they participated. This will help you begin to figure out what things might have contributed to the outbreak and if the ice cream really is to blame.
You call the family who hosted the party to learn more about the party and to get a list of names and phone numbers of kids and parents who attended.
Start interviewing!
Answer 2: Tell the parents who have sick kids that the raw eggs are to blame
[Incorrect]
Even though the raw eggs could be causing the sickness, you need to do a little more investigating to be sure. It's important to identify everything the patients have in common, including food, drinks, and activities in which they participated. You must confirm your information before alerting the public.
You call the family who hosted the party to learn more about the party and to get a list of names and phone numbers of kids and parents who attended.
Start interviewing!
Answer 3: Call the family who hosted the party to learn more about the party
[Correct]
By calling the family who hosted the party, you can go straight to the source. You should ask the party hosts for a list of names and phone numbers of kids and parents who attended the party. You need to interview them to identify everything the patients have in common, including food, drinks, and activities in which they participated.
Start interviewing!
Clue 2

After talking to the family who hosted the birthday party, you learn that about 30 kids and 16 adults attended the party on Sunday, August 1, at the Community Swim Club.
After the guests arrived, most of the kids played games and swam in the activity pool. After all of the games and swimming, the guests ate cake and ice cream.
The party hosts state that the ice cream was not made with raw eggs. In fact, 2 children who are sick left the party before the food was served. So, you decide to interview all who attended the party.
2. Which question do you think is the most important to ask during the interviews?
Answer 1: What foods did you eat at the party?
[Correct]
You're correct. It is important to get a complete food history from patients, especially when foodborne illness is suspected. By doing so, you will have a better chance of identifying items that the patients have in common.
Also, keep an open mind about all possible outbreak sources as there might be other things that are to blame for the outbreak.
Keep up the good work!
Answer 2: Did you go swimming at the birthday party?
[Correct]
Good thinking! There are many germs that can be spread by water. So, it's a good idea to find out if the people who are sick also swam in the pool.
Keep up the good work!
Answer 3: Do you have a weakened immune system?
[Correct]
You are right to ask each patient about their immune system. Many infections can be serious in a person with a weakened immune system. Examples of people with weakened immune systems include those with AIDS as well as cancer and transplant patients who are taking certain drugs.
However, a weakened immune system isn't the cause of the outbreak. It's important to figure out what foods, drinks, and activities the patients have in common.
Keep working to solve this outbreak!
Clue 3

Your investigation skills pay off! After talking with the kids and parents, you discover that the patients did not eat the same foods and quickly rule out foodborne illness.
Test results for 9 sick kids who attended the party came back positive for Cryptosporidium (or "Crypto"). The health department puts out an alert to encourage testing for Crypto (since it's not routinely done in most laboratories). Soon after, a local hospital reports 13 new Crypto infections in patients who did not attend the birthday party.
Definition

What is Cryptosporidium (or "Crypto")?
Crypto is a parasite that can cause watery diarrhea (that lasts a week or more), stomach cramps or pain, vomiting, and tiredness. Crypto is easily spread between people and from animals to people. You can get Crypto by:
- Coming into contact with feces (poop) of a person or animal infected with Crypto and then touching your mouth.
- Eating uncooked foods contaminated with (containing) Crypto.
- Swallowing water contaminated with Crypto.
Symptoms usually begin within a week of infection and can last a week or more in people with healthy immune systems. Learn how to protect yourself from getting sick.
Health Tips

Kids and adults can take steps to help protect themselves and others from Crypto and other germs:
- Practice good handwashing, especially before eating, after using the toilet, changing diapers or helping someone use the toilet, and handling an animal or animal waste.
- Don't swim when you have diarrhea. You can spread germs in the water and make other people sick.
- Don't take kids sick with diarrhea to child care facilities until the diarrhea has stopped. This will help protect other kids and staff.
3. What do you think is the most important thing for your team to do next?
Answer 1: Determine if the new cases are connected to the outbreak from the party
[Correct]
You are right on target! A less experienced Disease Detective might have simply assumed the patients are connected since they are all infected with Crypto. The best way to find out if the cases are connected is to interview the patients to see what (if anything) they have in common.
Keep working to solve this outbreak!
Answer 2: Interview the new patients to see what they have in common
[Correct]
If it isn't food that's causing these cases, you'll need to figure out how this parasite is being spread. The best way to find out if the cases are connected is to interview the patients to see what (if anything) they have in common.
Keep working to solve this outbreak!
Answer 3: Stop the investigation because you identified the germ that caused the outbreak
[Incorrect]
Even though you know Crypto caused these cases, you need to do a little more investigating. It's important to figure out how patients were infected with the parasite to help prevent others from getting sick.
So, you decide to call the new patients to see what (if anything) they have in common and determine if their sickness is connected to the outbreak from the party.
Keep working to solve this outbreak!
Clue 4

After talking with several of the new patients, you discover that they all swam in the Community Swim Club's activity pool on the weekend of July 31-August 1.
In reviewing the data, you learn that most of the individuals got sick within 1 week of swimming in the activity pool. Data about each of the known cases were collected, including:
- Age
- Gender
- Date and time of swimming in the activity pool.
Data

So far, you have learned that:
- 22 people are sick.
- 5 people have been hospitalized.
- Most patients became sick within 1 week of swimming in the Community Swim Club's activity pool.
Learn more about an epidemic curve (epi curve).
Cases

Data about each of the known cases were collected.
The data showed that many of the people who are sick were in the activity pool on the morning of Saturday, July 31, for an infant-parent swim class. Others were in the activity pool during the birthday party on the afternoon of Sunday, August 1.
Definition

What's an epidemic curve (epi curve)?
An epi curve shows how an outbreak changes over time. It includes:
- Date when each person became sick
- Number of people who became sick on each day
Epi curves are updated as new data come in, so they are always changing. The shape of the curve can provide clues about the possible source of an outbreak.
Learn how to read an epi curve.
4. Based on the data, what do most of the patients have in common?
Answer 1: Most patients are adults
[Incorrect]
The data show that only 4 of the patients were over the age of 12 years.
With 18 of the patients under the age of 13 years, you'll need to find out why so many kids are getting sick.
Answer 2: Most patients are female
[Incorrect]
Twelve males and 10 females are sick, so the sex of the patient isn't a clue.
The key to this outbreak is the age of the patients. Did you notice that 18 of the patients are under the age of 13 years? There's something fishy going on here.
In order to solve this outbreak, you'll need to find out why so many kids are getting sick.
Answer 3: Most patients are children
[Correct]
You are correct! The key to this outbreak is the age of the patients. With 18 of the patients under the age of 13 years, there's something fishy going on here.
In order to solve this outbreak, you'll need to find out why so many kids are getting sick.
Clue 5

The source of the outbreak is likely the swim club, so you request the attendance records for the weekend of interest.
Of the 157 people who visited the swim club that weekend, you discover that an additional 30 people have been sick with watery diarrhea lasting about 1 week. You talk to the new patients to find out about the activities they participated in while at the club.
Data

During the interviews, you ask each person what they did at the swim club during their visit and ask one of the EIS officers to calculate the "attack rate" for each activity.
| Attack Rate | = | the number of people who participated in an activity and are sick |
| the total number of people who participated in an activity |
Based on the interviews, the following attack rates were calculated:
- Used the locker rooms: 24%
- Used shower facilities: 29%
- Went into the activity pool: 58%
- Ate while at the pool: 59%
- Swallowed water while in the activity pool: 98%
Hint: To identify the likely source of the outbreak, look for a high attack rate among those who participated in a specific activity and low attack rate among those who did not participate.
Tip

During the interviews, several parents report that the diaper of one of the infants leaked diarrhea into the activity pool water during the infant-parent swim class. When you review pool records for the day of this class, you find that the pool did not receive any extra chlorine treatment after the diaper leaked.
Most germs are killed by chlorine within minutes, but Crypto can survive for days even in a pool with proper chlorine levels. To kill Crypto in a pool, the pool must be closed to swimmers and the chlorine levels must be raised to high levels for hours. This is why it's important to keep germs out of the water in the first place.
5. What activity do you think caused people to get sick?
Answer 1: Using the locker room
[Incorrect]
Based on the data from the interviews, it looks as though the activity pool was the source of the outbreak. In fact, 98% of those who swallowed water from the activity pool got sick.
You and the team suspect the outbreak began on the morning of July 31 during the infant-parent swim class and was probably the result of the diarrheal incident in the water (or in plain language, a poopy diaper, eeew!). Since the activity pool is mainly used by children, including the kids at the birthday party on August 1, many children got sick after using the pool.
Answer 2: Eating at the club
[Incorrect]
Based on the data from the interviews, it looks as though the activity pool was the source of the outbreak. In fact, 98% of those who swallowed water from the activity pool got sick.
You and the team suspect the outbreak began on the morning of July 31 during the infant-parent swim class and was probably the result of the diarrheal incident in the water (or in plain language, a poopy diaper, eeew!). Since the activity pool is mainly used by children, including the kids at the birthday party on August 1, many children got sick after using the pool.
Answer 3: Swallowing water from the activity pool
[Correct]
Your detective skills are right on! Based on the data from the interviews, it looks as though the activity pool was the source of the outbreak. In fact, 98% of those who swallowed water from the activity pool got sick.
You and the team suspect the outbreak began on the morning of July 31 during the infant-parent swim class and was probably the result of the diarrheal incident in the water (or in plain language, a poopy diaper, eeew!). Since the activity pool is mainly used by children, including the kids at the birthday party on August 1, many children got sick after using the pool.
Learn More

Recreational water illnesses (RWIs), like those in this fictional outbreak, are caused by Crypto and other germs, which are spread by swallowing, coming into contact with, or inhaling mists or aerosols of contaminated water.
All swimmers can actively protect themselves and other swimmers from RWIs by following these simple steps every time they swim:
- Don't swim when you have diarrhea; one person with diarrhea can easily contaminate an entire pool with germs.
- Check the chlorine and pH levels before getting in the water.
- Proper chlorine (1-3 mg/L or ppm) and pH (7.2-7.8) levels maximize germ-killing power.
- Don't swallow the water you swim in; it might contain germs.
- Take bathroom breaks every 60 minutes.
Parents of young children should take a few extra steps:
- Take children on bathroom breaks every 60 minutes.
- Check diapers every 30-60 minutes, and change them in the bathroom or diaper-changing area and not at poolside.
CDC's Healthy Swimming Program works to protect the health of swimmers by studying RWIs and how to prevent them. The Healthy Swimming Program is part of CDC's National Center for Emerging and Zoonotic Infectious Diseases (NCEZID).
Back To Top
Up Sick Creek

- Number Sick: 404
- Hospitalizations: 115
- Deaths: 118
- Location: Kenya
It has been raining for weeks in Kenya's North Eastern Province. The rain should be a welcome sight after last year's drought. However, several villages are flooded and hundreds of villagers are complaining of fever, muscle pain, weakness, and dizziness.
Local health workers called to report a possible outbreak and asked CDC for help.
Clue 1

A Kenyan health worker reports that the villagers are in a panic. More than 400 people in the North Eastern Province have flu-like symptoms. Most of the sick are complaining of fever, muscle pain, weakness, and dizziness.
Although many of the sick felt better within the week, more than 100 were hospitalized due to extremely high fevers, blindness, and seizures. Some have slipped into a coma and some have bled to death.
Data

During your talk with the health worker, you learn that most of the cases are quite mild, while others are more severe.
In reviewing the data, you find that most of the individuals got sick from December 15 - 30, but recovered quickly (within the week).
Learn more about an epidemic curve (epi curve). Find more detailed information on how to read an epi curve.
Definition

What's an epidemic curve (epi curve)?
An epi curve shows how an outbreak changes over time. It includes:
- Date when each person became sick
- Number of people who became sick on each day
Epi curves are updated as new data come in, so they are always changing. The shape of the curve can provide clues about the possible source of an outbreak.
Learn how to read an epi curve.
1. What should you ask the health worker to do next?
Answer 1: Send all of the sick to the local hospital
[Incorrect]
Most of the cases are mild. Sending everyone to the hospital now will only make it more difficult for the staff to pay full attention to the people who need it the most. Instead, ask the health worker to identify all of the sick and interview them to find out what they have in common.
Keep working!
Answer 2: Begin interviewing those who are sick
[Correct]
Start interviewing those who have become sick to find out what they have in common. You should also find out if anything else unusual is happening in the villages.
Keep working!
Answer 3: Wait until you get there to do anything
[Incorrect]
Time is critical and we have a lot of work to do. Have the health worker interview those who are sick and find out what they have in common. You need to find out what is causing the outbreak before everyone in the villages becomes sick.
Keep working!
Clue 2

The health worker walks through heavy mud for many miles to identify the sick and interview them about their experience.
After reviewing the data from the interviews, you discover that many of the sick are herdsmen, farmers, and housewives. The interviews also reveal that thousands of the villages' sheep have died. Many more sheep are starting to show signs of sickness.
Cases

You have found that many of the people who are sick have been in contact with some of the sick animals. In fact, of those who are sick:
- 75% reported handling raw meat or raw milk.
- 67% reported having contact with a sick animal.
- 25% reported slaughtering animals.
- 10% reported having contact with a sick person.
2. What do many of the sick have in common?
Answer 1: They live near each other
[Incorrect]
Sorry, many of the people who are ill are spread out among several rural villages and very few have other family members who are also sick.
Those who are sick seem to have a few other things in common. Many are herdsmen, farmers, and housewives who have reported touching sick animals or handling raw meat.
Keep investigating to find out more.
Answer 2: They touched raw meat
[Correct]
Correct! Many of the herdsmen, farmers, and housewives reported touching sick animals or handling raw meat.
Keep investigating to find out more.
Answer 3: They have a sick family member
[Incorrect]
Sorry, not many of the sick people had a sick family member. However, many of the herdsmen, farmers, and housewives have reported touching sick animals or handling raw meat.
Keep investigating to find out more.
Clue 3
 Now that you've identified what the patients have in common, next you'll need to figure out how they got sick. So, you sit down with the local health worker to learn more about the sheep:
Now that you've identified what the patients have in common, next you'll need to figure out how they got sick. So, you sit down with the local health worker to learn more about the sheep:
- Many of the sheep live near the flooded river and eat grain from the nearby fields.
- Herdsmen have reported seeing swarms of insects around the sheep.
- The local veterinarian noticed intestinal parasites (worms that live in the intestines) in 10 of the sheep.
Data

More than 1,000 villagers were interviewed, those who were sick as well as those who were healthy. Each person was asked what they did one week before getting sick. One of the health workers calculated the "attack rate" of each item.
| Attack Rate | = | the number of people who participated in an activity and are sick |
| the total number of people who participated in an activity |
Based on the interviews, attack rates were calculated for those who participated in the following activities:
- Drank water from flooded streams: 9%
- Bitten by a mosquito: 83%
- Have been around sheep: 70%
Hint: To find a possible source of the outbreak, look for both a high attack rate for those who participated in an activity and a low attack rate among those who did not participate.
3. What do you think is causing the illness?
Answer 1: Parasites
[Incorrect]
Nope, sorry. In fact, only 10 out of the 200 sheep (or about 5%) were affected by parasites. So, it's not likely that the parasites are to blame.
If you study the data, you'll notice that 83% of people who were bitten by a mosquito became sick and only 4% of people who were NOT bitten by a mosquito became ill. It looks like the mosquitoes may play a role in this outbreak.
Answer 2: Contaminated crops
[Incorrect]
No. Other animals have eaten the same crops and seem to be just fine. In this case, it might be the insects. Mosquitoes can carry diseases, and the attack rate for those with mosquito bites was 83%. The attack rate was only 4% for those without mosquito bites.
It looks like the mosquitoes may play a role in this outbreak.
Answer 3: Mosquitoes
[Correct]
The attack rate for those with mosquito bites was 83%, and only 4% for those without mosquito bites. Since there has been so much flooding in the area, there are more insects than ever this year and insects are known to carry certain diseases.
It looks like mosquitoes may play a role in this outbreak.
Clue 4

The mosquitoes are getting worse. You have noticed insect bites on the sick sheep as well as on the people who are ill.
Since you suspect mosquitoes play a role in how the disease is being spread, you decide to test the sick for two diseases that cause similar symptoms in humans: yellow fever and Rift Valley fever (RVF).
Definition

Yellow fever or Rift Valley fever (RVF)?
Both diseases are spread to humans by mosquito bites. The most common symptoms of both yellow fever and Rift Valley fever include:
- Fever
- Weakness
- Back pain
While yellow fever primarily affects humans, Rift Valley fever may affect both animals and humans. RVF can also be spread by exposure to blood, body fluids, or tissues of infected animals. Outbreaks usually happen during years of very heavy rainfall and flooding.
Learn how to protect yourself from getting sick.
Health Tips

The best way to prevent yellow fever or Rift Valley fever (RVF) is to:
- Avoid mosquitoes.
- Use an effective insect repellent on visible skin and clothing.
- Wear long-sleeves, long pants, and socks when outdoors.
- Stay in buildings with screened or air-conditioned rooms.
- Use bed nets or mosquito netting around beds.
- Avoid exposure to blood or tissues of animals to prevent Rift Valley fever.
4. What would you do next?
Answer 1: Prevent others from getting mosquito bites
[Correct]
Yes, it looks like there is a strong link between the outbreak and mosquito bites. While the sick are being treated, make sure other people stay healthy. Use mosquito nets, insect repellents, and wear long sleeves, pants, and socks to avoid mosquitoes.
Answer 2: Treat everyone with a mosquito bite for yellow fever
[Incorrect]
Not yet. You aren't sure which virus is to blame. Besides, not every person who has been bitten by a mosquito is sick. Instead, take steps to prevent others from being bitten by a mosquito to help keep the outbreak under control.
Answer 3: Case closed. No need to do any more work.
[Incorrect]
There is a whole village depending on you to help them. They need to know what is causing the outbreak in order to keep others from becoming sick. Keep looking for clues.
Clue 5

The blood test results are in. It looks like Rift Valley fever is to blame.
In your talks with the locals, you've uncovered a few key findings that may help uncover how the outbreak spread:
- Not all of those who were ill had contact with sheep.
- Many of the villagers reported having old or damaged mosquito nets.
- All of the villages in the area experienced heavy flooding during the recent rainstorms.
Definition

What is Rift Valley fever?
Rift Valley fever (RVF) is a disease caused by a virus that affects several species of domestic animals and humans. Both humans and animals get Rift Valley fever from the bite of an infected mosquito. Humans may also get Rift Valley fever by exposure to blood, body fluids, or tissues of infected animals. Outbreaks typically happen during years of unusually heavy rainfall and flooding.
The most common symptoms include:
- Fever
- Weakness
- Back pain
- Dizziness
Most people who have Rift Valley fever get better within two days to one week, but some can die from more serious complications.
5. What was the most important factor in the spread of Rift Valley fever to humans?
Answer 1: The sheep
[Correct]
It all started with the mosquitoes…Rising floodwaters caused more mosquitoes to hatch this year. Mosquitoes carrying the Rift Valley fever virus spread the virus by biting the sheep and the people in the villages.
The investigation revealed that while some of the patients got sick after being bitten by the mosquitoes, others came into contact with the blood, guts, or raw meat or milk of sheep that were sick.
It looks like both sheep and mosquitoes are to blame for this outbreak. Your detective skills have helped to solve this outbreak.
Answer 2: The mosquitoes
[Correct]
Answer 3: Contaminated flood waters
[Incorrect]
Although the flood waters may have been contaminated with other items that could cause problems, this is not how the Rift Valley fever virus is spread.
Instead, rising floodwaters caused more mosquitoes to hatch this year. Mosquitoes carrying the Rift Valley fever virus spread the virus by biting the sheep and the people in the villages. The investigation revealed that while some of the patients got sick after being bitten by the mosquitoes, others came into contact with the blood, guts, or raw meat or milk of sheep that were sick.
It looks like both sheep and mosquitoes are to blame for this outbreak. Your detective skills have helped to solve this outbreak.
Learn More

This fictional outbreak was based on a real-life outbreak in the North Eastern Province of Kenya in 2006.
In mid-December, several unexplained deaths associated with fever and generalized bleeding were reported to the Kenya Ministry of Health (KMOH). On December 20, an investigation was launched by KMOH and involved several partners, including CDC-Kenya's Global Disease Detection Center and the World Health Organization (WHO).
Teams of investigators interviewed patients, reviewed medical records, and met with village elders and healthcare providers in villages where cases had been reported. Blood samples from patients were collected and antibodies for Rift Valley fever (RVF) were found. Reports of livestock deaths and unexplained animal abortions provided further evidence of an outbreak.
As of January 25, 2007, a total of 404 cases of RVF had been reported in Kenya with 118 deaths. To prevent further spread, live animals were vaccinated and a ban on livestock slaughtering was put into place.
Note: Several aspects of the original outbreak and investigation have been altered to fit the format and length of this application.
Back To Top
Midterm Revenge

- Number Sick: 76
- Hospitalizations: 3
- Deaths: 0
- Location: US (1 State)
Many students at a university in Texas haven't been able to keep their lunch down for the last 2 days. They've stopped showing up for their fall midterm exams. Instead, they've started showing up at the student health center.
Clue 1

A couple of students are feeling miserable after a late night of partying and eating pizza following a big win by the university's football team.
Two students called the student health center asking for an official excuse to skip midterm exams. The nurse at the health center didn't think much of this until more students started showing up with vomiting and diarrhea. Dozens of students are sick and staff at the health center suspect that a stomach bug might be going around.
Cases

Within the last 2 days, 53 students have come to the student health center with similar symptoms, all of which began suddenly. Of the 53 students:
- 91% are vomiting.
- 87% have nausea.
- 72% have diarrhea.
- 67% have stomach cramps.
- 61% have a fever.
- 53% have a headache.
The medical staff tells you that they have diagnosed the students with acute gastroenteritis. However, the routine tests at the student health center did not identify the cause.
Definition

What is Gastroenteritis?
Gastroenteritis is an inflammation of the stomach and intestines. The most common symptoms include:
- Watery diarrhea
- Vomiting
- Headache
- Fever
- Stomach cramps
The symptoms typically last for 1 to 3 days. Although viruses are the most frequent cause, gastroenteritis can also be caused by bacteria, parasites, or chemicals.
1. What should you do now?
Answer 1: Tell the sick students to stop partying so hard and go to class
[Incorrect]
Some students have fever along with vomiting, diarrhea, and other symptoms. So, there's more to this story.
Keep investigating to solve this outbreak.
Answer 2: Keep the sick students in the same area until their symptoms are gone
[Incorrect]
There's no need to keep the students away from others until their symptoms are gone. Besides, keeping 53 students in the same area for more than a few hours will probably make you and them bonkers!
Keep investigating to solve this outbreak.
Answer 3: Find out if others are sick as well
[Correct]
It's important to find out if others are sick too.
You call the local hospital and ask if they've had patients in the last 24 to 48 hours with nausea, vomiting, diarrhea, and stomach cramps. The nurse tells you that they haven't seen more than a handful of new patients with these symptoms all week.
It looks like only students from the university are getting this illness.
Keep investigating to solve this outbreak!
Clue 2

Things are getting worse. Since the beginning of the week, 76 students have visited the student health center with similar symptoms. Most of the students are getting better in a day or two. But 3 students have become dehydrated and are being treated in a local hospital.
The student health center collected stool samples from the sick students and performed bacterial testing. The results came back negative for the common bacteria and parasites that could have made the students sick. So, the samples were sent to the health department laboratory for viral testing.
Data

To find out what caused the outbreak, you need to know when it started. After talking with the staff at the student health center, you find out that:
- March 9: First students got sick.
- March 10: The number of new patients peaks.
- March 12: Symptoms began for the last people who got sick.
Symptoms from a typical stomach bug usually start 1 to 2 days after coming into contact with the virus. Based on the data, you suspect that the first person was exposed around March 8 and that the "exposure period" (the time when the students were likely exposed to the contamination) is March 7-10.
View the epidemic curve (epi curve) to see when the outbreak started. Learn more about an epi curve.
Health Tips

The best ways to stay hydrated when you have gastrointestinal illness are to:
- Drink plenty of clear liquids (water, broth, or sports drinks).
- Avoid alcohol or drinks with caffeine (colas, teas, and coffee).
- Eat ice chips or frozen ice pops.
- Use a squeeze bottle or a straw if you are too weak to drink from a cup.
Definition

What's an epidemic curve (epi curve)?
An epi curve shows how an outbreak changes over time. It includes:
- Date when each person became sick.
- Number of people who became sick on each day.
Epi curves are updated as new data come in, so they are always changing. The shape of the curve can provide clues about the possible source of an outbreak.
Learn how to read an epi curve.
2. What should you do next?
Answer 1: Talk to the students to find out what they have in common that might have made them sick
[Correct]
You're correct! You need to find out what the students have in common, such as:
- Did they go to the same party or place?
- Did they consume the same foods or drinks?
- Do they live in the same dorm?
To narrow down what might be causing the illness, interview the sick students as well as a sample of students who did not get sick ("controls") and compare their answers.
Answer 2: Shut down the dorms and send all the students home
[Incorrect]
You don't need to send anyone home. The symptoms of this illness are no fun, but they usually don't last long. Most of the sick students get better in a few days.
To narrow down what might be causing the illness, interview the sick students as well as a sample of students who did not get sick ("controls") and compare their answers.
Answer 3: Tell the students not to eat or drink anything for the next 24 hours
[Incorrect]
This may be the only time that telling a university student to "drink, drink, drink!" is the right thing to do. The students need to drink plenty of clear liquids to replace fluids lost from vomiting and diarrhea. This can help prevent dehydration.
In the meantime, you need to know if more people are getting sick. To narrow down what might be causing the illness, interview the sick students as well as a sample of students who did not get sick ("controls") and compare their answers.
Clue 3

Great news! The outbreak seems to be slowing down. No other students have gotten sick in the last 3 days. Those who are sick are beginning to feel better.
In the meantime, you've been trying to find out what caused the outbreak by interviewing the students and have learned some important information. Now, you need to look for patterns in the data to find the source of the outbreak and stop further spread of the illness.
Cases

In looking over the students' school records, you find that the 76 sick students have some things in common for the time when they were most likely exposed to the contamination (March 7-10):
- All the students live on campus in one of the university's 4 dorms.
- All drank municipal tap water from the dorms.
- All ate in the school's food court, which is 1 of 3 cafeterias on campus.
- Only a handful of the sick students have classes in the same buildings.
3. Where do you think the outbreak started?
Answer 1: The water supply in the dorms
[Correct]
The outbreak could be caused by the water in the dorms. But if that were so, many more students and people in the community would be sick. But that's not the case. Upon further investigation, you learn that the dorms use the same water as the city and no one else in the community is reporting any symptoms.
In looking at the data again, you notice that all of the sick students ate at the food court during the time when they were most likely exposed to the contamination (March 7-10). The food court is only 1 of 3 cafeterias on campus, so it's unusual that all of the students who are sick ate at the food court.
Perhaps there's something at the food court that is causing this sickness? It's your job to find out!
Answer 2: The classrooms
[Incorrect]
That's incorrect. Only a few students share the same classes. Most of the sick students don't even know each other.
In looking at the data again, you notice that all of the sick students ate at the food court during the time when they were most likely exposed to the contamination (March 7-10). The food court is only 1 of 3 cafeterias on campus, so it's unusual that all of the students who are sick ate at the food court.
Perhaps there's something at the food court that is causing this sickness? It's your job to find out!
Answer 3: The food court
[Correct]
Yes! All the sick students ate at the food court during the time when they were most likely exposed to the contaminated food (March 7-10). The food court is only 1 of 3 cafeterias on campus, so it's unusual that all of the students who are sick ate at the food court.
Take a look at what the students ate and drank to see if the illness could be caused by a particular food. It's your job to find out what's causing this outbreak.
Clue 4

While you suspect the outbreak started at the food court, you need to confirm your suspicions. So, you decide to interview other students from campus who are not sick ("controls").
You're able to talk with 273 students who don't have any symptoms. You discover that most of these students did not eat at the food court during March 7-10 and instead chose to eat at one of the other cafeterias on campus. However, 100 of the students who are not sick did eat at the food court during this time.
In order to identify why some students got sick and others did not, you need to identify the source of the exposure. So, you ask the students about the foods they ate at the food court and also interview the staff who work in the food court.
Cases

Of the 76 students who are sick, you were able to interview 62 students. You were also able to interview the 100 students who ate at the food court between March 7-10 but did not get sick ("controls"). You ask all of the students to list the foods they ate at the food court during the days in question.
Take a look at the data to figure out which foods are causing students to get sick.
Data

You use the data from the interviews to calculate the "attack rate" for each of the foods eaten at the food court during March 7-10.
Interestingly, you discover that most of the students who are sick ate sandwiches, while the students who are well tended to eat foods from the salad bar, the grill, the soup line, or the pizza counter. So, you calculate the attack rate of the foods from the sandwich line to find out what is causing students to get sick.
| Attack Rate | = | the number of people who ate a food item and are sick |
| the total number of people who ate a food item |
Hint: To identify the likely source of the outbreak, look for a high attack rate among those who ate a specific food and low attack rate among those who did not eat this food.
Tip

You also interview the workers in the food court. Helen, the person in charge of making sandwiches, tells you that she wasn't feeling well and had diarrhea and stomach cramps a few days before the outbreak began.
While you are interviewing her, you notice that she frequently touches other surfaces, including the cash register, and then goes back to handling food without washing her hands. You also notice that there aren't any signs posted about employee handwashing.
4. Based on the data, what is causing students to get sick?
Answer 1: The ham
[Correct]
You're partially right. While some students who ate the ham are sick, it looks like there were several items from the sandwich line that caused students to get sick.
You start to wonder if the food worker did not wash her hands properly and contaminated more than one of the items used to make sandwiches when she was sick.
Keep going! There's still more you need to know to prevent this from happening again.
Answer 2: The cheese
[Correct]
You're partially right. While some students who ate the cheese are sick, it looks like there were several items from the sandwich line that caused students to get sick.
You start to wonder if the food worker did not wash her hands properly and contaminated more than one of the items used to make sandwiches when she was sick.
Keep going! There's still more you need to know to prevent this from happening again.
Answer 3: More than one item from the sandwich line
[Correct]
You're exactly right. It looks like there were several items from the sandwich line that caused students to get sick.
You start to wonder if the food worker did not wash her hands properly and contaminated more than one of the items used to make sandwiches when she was sick.
Keep going! There's still more you need to know to prevent this from happening again.
Clue 5

The results are in! The health department calls to tell you that the samples from the sick students tested positive for norovirus.
You suspect that the sick food court worker spread the virus when she was sick with diarrhea and handled the foods in the sandwich line.
Learn how you can protect yourself from norovirus.
Definition

What is Norovirus?
Norovirus is very contagious. You can get infected with this virus by:
- Eating foods or drinking liquids contaminated with norovirus.
- Touching objects and surfaces contaminated with norovirus then putting your fingers in your mouth.
- Having close contact with someone who is infected.
The most common symptoms are diarrhea, vomiting, nausea, and stomach pain. Most people who get sick with norovirus feel better within 1 to 3 days.
Learn how to protect yourself from norovirus.
Health Tips

The best way to help prevent norovirus infection is to:
- Wash your hands carefully with soap and water.
- Rinse fruits and veggies carefully.
- Cook seafood to proper temperatures.
- When you are sick, do not care for or make food for others.
- Avoid touching ready-to-eat foods with your bare hands.
- Clean and disinfect contaminated surfaces.
- Wash soiled laundry thoroughly.
5. What should you do to prevent another outbreak like this one?
Answer 1: Educate the food court workers to avoid preparing food while sick
[Correct]
You should also remind the food court workers to always:
- Wash hands carefully with soap and water, especially after bathroom use.
- When sick, do not make food for others.
- Avoid touching ready-to-eat foods with bare hands.
- Clean and disinfect contaminated surfaces.
- Rinse fruits and veggies carefully.
- Clean and disinfect kitchen utensils, counters, and surfaces.
- Wash table linens, napkins, and other laundry thoroughly.
In addition, throw away all left over food items that the sick food court worker may have handled and disinfect the food court.
Answer 2: Reinforce the need to properly wash hands before preparing food
[Correct]
You should remind the food court workers to always:
- Wash hands carefully with soap and water, especially after bathroom use.
- When sick, do not make food for others.
- Avoid touching ready-to-eat foods with bare hands.
- Clean and disinfect contaminated surfaces.
- Rinse fruits and veggies carefully.
- Clean and disinfect kitchen utensils, counters, and surfaces.
- Wash table linens, napkins, and other laundry thoroughly.
In addition, throw away all left over food items that the sick food court worker may have handled and disinfect the food court.
Answer 3: Require all food court staff to submit lab work every week to ensure they are not infected
[Incorrect]
It's not necessary to test all the food court workers. Testing for norovirus is not widely available and tests may be positive after you're no longer contagious. Instead, food court workers should not handle food while they are sick and for 3 days after they feel better.
You should remind the food court workers to always:
- Wash hands carefully with soap and water, especially after bathroom use.
- When sick, do not make food for others.
- Avoid touching ready-to-eat foods with bare hands.
- Clean and disinfect contaminated surfaces.
- Rinse fruits and veggies carefully.
- Clean and disinfect kitchen utensils, counters, and surfaces.
- Wash table linens, napkins, and other laundry thoroughly.
In addition, throw away all left over food items that the sick food court worker may have handled and disinfect the food court.
Learn More

This outbreak was fictional but parts of it were based on a real-life investigation at a university in Texas in 1998. To solve the real outbreak, many epidemiologists and scientists worked closely with the university and the health department.
The best course of action to prevent outbreaks such as this is to:
- Educate or remind owners, managers, and workers that working while sick is one of the main causes of foodborne outbreaks.
- Educate or remind owners, managers, and workers about the importance of hand washing and avoiding bare-handed contact with ready-to-eat foods.
- Encourage owners and managers to establish written policies that require workers to report symptoms.
- Encourage the presence of a kitchen manager certified in food safety in retail food establishments.
Back To Top
African Epidemic

- Number Sick: 110
- Hospitalizations: 45
- Deaths: 31
- Location: Guinea
It's late in the year in Guinea, a country in West Africa. People from one of the villages have been going to the local healer with fevers, headaches, vomiting, and muscle pains. Sadly, several people have already died and more are getting sick.
As an officer in the CDC Epidemic Intelligence Service (EIS), you'll help solve the outbreak in the village of Dandano.
Clue 1

Village elders don't know what is causing about 30 of the villagers to get sick. Family members are doing their best to care for them.
You need to find out how these people got sick. By tracking their activities, you can narrow down the initial source of the illness. This is a critical step in disease prevention and the start of contact tracing.
Cases

You start by interviewing the 30 sick people to find out what they were doing before becoming ill.
Many villagers work in the nearby fields with livestock or crops. Several others draw water from a well a few miles away. Some travelled outside the village to the closest city for work.
Most of the sick villagers visited the traditional healer. A traditional healer helps treat most minor illnesses and problems. They use knowledge and skills unique to their culture to help treat and prevent illness.
Definition

Contact tracing is finding everyone who comes in direct contact with a sick person. Doctors then watch those people for symptoms for several days.
If that person starts to show symptoms, there are 3 possible next steps: isolation, testing or additional care. Then the cycle starts again, the new sick person's contacts will be located and watched for days. Contact tracing can be a lot of work, but it is important to help stop the spread of a disease.
1. What should you do next?
Answer 1: Talk further with the people who saw the traditional healer
[Correct]
It seems like the traditional healer might be the common thread among the sick people so far. Lots of people seem to have developed the same kind of symptoms after visiting him. Finding out what the sick people have in common means you can find out more about the disease. Keep working to solve the outbreak!
Answer 2: Call a press conference
[Incorrect]
It's not entirely clear what the disease even is yet. It's too early to announce that a disease is spreading. Announcing something like this could scare the public! You need to know exactly what you're dealing with before telling everyone.
It seems like the traditional healer might be the common thread among the sick people so far. Lots of people seem to have developed the same kind of symptoms after visiting him. Finding out what the sick people have in common means you can find out more about the disease. Keep working to solve the outbreak!
Answer 3: Isolate the village
[Incorrect]
Isolating everyone could keep the outbreak from spreading. But it also means you won't be able to work closely with the villagers anymore. It's also too early to isolate the sick people since you don't know what the disease is yet. There's also no evidence yet of what's causing it to spread.
Many of the sick people saw the village healer. You should probably investigate that a little more. Keep working to solve the outbreak!
Clue 2

After talking with those who saw the traditional healer you learn that he was also sick and later died. You use the dates that people visited the healer to help with your investigation.
There are now 35 people confirmed sick in Dandano and 3 have died. There may be more, but you can't confirm how many because the healer hid the actual numbers of sick people.
Other villages nearby are starting to experience the same problems. You send blood samples of sick people for testing to find out what is causing people to get sick.
Other organizations like the World Health Organization (WHO) and Doctors Without Borders are called in to help fight the disease.
Data

It's important to find how long it takes for a disease to appear after coming in contact with another sick person. This is called the incubation period. It is calculated by the longest amount of time between when a person is exposed to a disease and when they begin to show symptoms. This information helps medical officers know how long to monitor someone before deciding if they are sick or well.
You gather data on a sample of the sick people who saw the healer. You note how long it took before they started to show symptoms. You find out that most people visited the healer for unrelated reasons like back aches or broken arms. They later started to exhibit similar symptoms.
2. How long should you monitor people who could be sick?
Answer 1: 3 days
[Incorrect]
The disease can take anywhere from 2 to 21 days to show up, and the average is 8-10 days. To be safe, you tell medical workers to monitor people who might be sick for 42 days (two incubation periods) after symptoms first appear. This is a common practice so that you are absolutely certain that someone doesn't have the disease. Anyone who shows symptoms in that time should be considered sick!
Keep working to save lives!
Answer 2: 7 days
[Incorrect]
The disease can take anywhere from 2 to 21 days to show up, and the average is 8-10 days. To be safe, you tell medical workers to monitor people who might be sick for 42 days (two incubation periods) after symptoms first appear. This is a common practice so that you are absolutely certain that someone doesn't have the disease. Anyone who shows symptoms in that time should be considered sick!
Keep working to save lives!
Answer 3: 21 days
[Correct]
Good eye! The disease can take anywhere from 2 to 21 days to show up, and the average is 8-10 days. To be safe, you tell medical workers to monitor people who might be sick for 42 days (two incubation periods) after symptoms first appear. This is a common practice so that you are absolutely certain that someone doesn't have the disease. Anyone who shows symptoms in that time should be considered sick!
Keep working to save lives!
Clue 3

The test results confirm that these villagers have Ebola. In the village of Dandano, 75 more people have gotten sick, and 10 more have died. This brings the total to 110 sick and 13 deaths.
The disease is spreading fast in neighboring villages as well. You need to figure out who the disease affects and if certain people are more prone to getting sick.
At the local missionary clinic, the medical workers who are caring for the sick people are also getting sick themselves. Two nurses are now showing symptoms: fevers, headaches, vomiting, and muscle pains! They have been giving meals, washing, and taking blood samples from sick people. You warn the rest of the staff to be very careful while caring for them. You recommend they wear protective clothing to prevent the spread of the disease.
Definition

What is Ebola?
Ebola is a rare and deadly disease caused by infection with an Ebola virus species. These virus species are found in several African countries. Since its discovery in 1976, Ebola outbreaks have appeared occasionally in Africa and in the Philippines.
The natural host of Ebola remains unknown, but researchers believe the virus starts in animals - most likely bats. Ebola can be spread among people through direct contact with:
- Blood or body fluids like urine, saliva, sweat, poop, or vomit of a person who is sick with or died from Ebola, or
- Objects that a person who is or was sick has touched.
Symptoms of Ebola can include fever, severe headache, muscle pain, weakness, fatigue, diarrhea, vomiting, abdominal (stomach) pain and unexplained hemorrhage (bleeding or bruising).
Data

Now that you know the disease is Ebola, you want to find out what groups of people are particularly affected. You need to find out what the people who are sick have in common. This will help you determine if one group is affected more than another.
You note ages, occupations, and gender of people who are sick and compile it into charts. You compare the same information to people who are well, and look for any trends in the data.
A partner organization shares the data they have also collected on attack rates in their regions. You can compare your results to the rest of the country to see if certain regions are particularly affected by the disease.
| Attack Rate | = | the number of people who are sick |
| the total number of people |
Notes

In order to minimize contact with people who are sick, healthcare workers begin wearing personal protective equipment (PPE). PPE is specialized clothing or equipment worn for protection against infectious diseases. PPE might include gloves, masks, goggles, boots and protective gowns.
PPE helps by creating a protective barrier between sick person and a healthcare worker. Wearing PPE will help the Guinean healthcare workers provide care to sick people, while protecting themselves from getting sick.
After healthcare workers begin wearing PPE, you notice that fewer healthcare workers are getting sick. The PPE is working!
3. What group of people are more affected by Ebola?
Answer 1: Adults
[Incorrect]
It seems like the disease is affecting everyone! Based on the data all people - young and old, male and female - are getting sick. This means that Ebola isn't restricted to certain kinds of people. If the disease can affect anyone that also means it can spread quickly!
Nobody is safe from Ebola - you'll need to work fast and solve the outbreak soon to save lives!
Answer 2: People in villages
[Incorrect]
It seems like the disease is affecting everyone! Based on the data all people - young and old, male and female - are getting sick. This means that Ebola isn't restricted to certain kinds of people. If the disease can affect anyone that also means it can spread quickly!
Nobody is safe from Ebola - you'll need to work fast and solve the outbreak soon to save lives!
Answer 3: Everyone is affected by Ebola
[Correct]
It seems like the disease is affecting everyone! Based on the data all people - young and old, male and female - are getting sick. This means that Ebola isn't restricted to certain kinds of people. If the disease can affect anyone that also means it can spread quickly!
Nobody is safe from Ebola - you'll need to work fast and solve the outbreak soon to save lives!
Clue 4

The best way to stop the spread of Ebola is to isolate the people who are sick. Once you know this, you can separate people and observe them for symptoms over a 42-day period.
But, you are struggling to identify the people who are sick. Many sick people are saying they are healthy so that friends and family won't ignore them. This is a big problem when conducting contact tracing. It's hard for you to trace who has come in contact with a sick person and who hasn't.
Mothers and fathers are doing their best to stay with, hold, and comfort their sick children. But healthy villagers want to isolate the sick and keep them away by boarding up their homes.
Cases

You hear that a neighboring village held a funeral for a midwife who passed away last month. Over 100 people attended the funeral; 18 of the people who attended died soon after the funeral. You find out that the midwife had shown symptoms of Ebola before passing away.
Through your investigation you know that Ebola is transmitted through contact with corpses or bodily fluids of an infected person. Many of the traditional burial practices in this area typically involve washing, touching, and kissing the body of the dead. So it's possible that the funeral attendees could have had direct contact with the body and body fluids.
4. What's the best way to balance the spread of Ebola and respect burial traditions?
Answer 1: Nothing - you can't balance culture against the spread of Ebola
[Incorrect]
At this point, there's still a lot you can do to help save lives. Encouraging the use of PPE as well as safe burial practices can help contain the spread of Ebola. By communicating the benefits of these behaviors, you can get the public to stay safe!
Keep working to save lives
Answer 2: Educate the public on safe burial practices
[Correct]
There is a lot of conflict between what people want to do and what people should be doing. It might be hard to convince people to use modified body handling and burial practices. But you have to keep teaching them that it will save lives in the long run.
Answer 3: Stop all traditional burials - we need to stop Ebola NOW!
[Incorrect]
Stopping all traditional burials is difficult. Many people are dying and people want to pay their respects to their loved ones who are dying from Ebola. Instead, encourage the village to use safe burial and body handling practices. This way, people can still pay their respects while preventing the spread of Ebola.
There are still cases occurring, so keep working to save lives!
Clue 5

You develop some Public Service Announcements (PSAs) to teach people about safe burial practices and other ways to prevent Ebola. Local TV and radio stations are starting to play the PSAs you helped create. A trusted doctor shares this vital information over the airwaves.
The villagers begin to use these practices, which limits the spread of Ebola. Nearby villages and neighboring countries also educate people in their areas to help keep the disease from affecting them. For now, you've contained the spread of Ebola within Guinea. But symptoms don't appear until several days after contact. So it's possible that people are traveling to other parts of the continent without knowing that they could have Ebola.
Notes

Your public health notices include radio messages, posters, and other informational postings. You are trying to share the facts about Ebola. This includes how it can be transmitted, prevented, treated, where it can be found, symptoms, and other information to help people understand the disease better.
You want to help villagers understand their role in the fight against Ebola. You know that simply sharing this information throughout Guinea can actually save lives. People will become more aware of the risks and avoid actions that could spread Ebola.
5. What should you do to prevent an Ebola outbreak from continuing to spread?
Answer 1: Screen travelers for symptoms before leaving and after arriving
[Correct]
This is definitely an effective option to help limit spread. At airports, seaports, and bus stations, medical workers check travelers for symptoms of Ebola. They ask if travelers have come into contact with someone who has had Ebola. By screening travelers before they leave and after they arrive at their destination, you can help limit the spread of disease. These screenings keep anyone with symptoms from traveling while allowing healthy people to travel as needed.
Congratulations, your hard work helped to solve this outbreak and save lives!
Answer 2: Don't let anyone in or out of the affected area
[Incorrect]
Keeping people from moving in and out of the affected areas could pose serious problems. Some of the people work outside their areas and won't be able to make a living if you prevent travel. And people may not be able to get the care, medicine, or help they need to get better!
Let's keep the borders open to get people the help they need. At airports, seaports, and bus stations, medical workers check travelers for symptoms of Ebola. They ask if travelers have come into contact with someone who has had Ebola. By screening travelers before they leave and after they arrive at their destination, you can help limit the spread of disease. These screenings keep anyone with symptoms from traveling while allowing healthy people to travel as needed. Your hard work helped to save lives!
Answer 3: Require doctor's approval for all travelers before they leave
[Incorrect]
Requiring a doctor's note for travelers only inconveniences people who are trying to move in and out of affected areas. This could slow down the people who are trying to get medicine or give care to those who are sick.
To limit the spread of Ebola, screen travelers before they leave and after they arrive. This will help you determine who is healthy enough to travel. At airports, seaports, and bus stations, medical workers will check travelers for symptoms of Ebola. They will also ask if they've come into contact with someone who has had Ebola. You can help limit the spread of disease by keeping anyone with symptoms from traveling while allowing healthy people to travel as needed.
Your hard work helped to save lives!
Learn More

Your hard work helped solve this outbreak!
This fictional outbreak is based on the Ebola outbreaks that occurred throughout West Africa from 2014 until 2016. This was the largest outbreak of Ebola in history. More than 28,000 people became sick and more than 11,000 people died.
Multiple health organizations like the CDC and the World Health Organization (WHO) were sent to multiple countries in Africa. Several other countries like the United States, the United Kingdom, Spain, and Italy also reported cases of Ebola. At the height of the epidemic, there were thousands of people dedicated to fighting the spread of Ebola.
By using safe treatment methods and effective travel screenings, the CDC was able to help limit the spread of Ebola. On March 29, 2016, the WHO declared that the Ebola outbreak was no longer an international public health emergency.
Note: Several aspects of the original outbreaks and investigations have been altered to fit the format and length of this application.
Back To Top
Washed Out

- Number Sick: 828
- Hospitalizations: 213
- Deaths: 55
- Location: Ethiopia
Refugees from South Sudan are fleeing to escape from armed violence and are settling in an Ethiopian refugee camp.
You hear that 3 refugees with symptoms of fever, fatigue, nausea, and yellow eyes have died in the past week, and more might be sick with the same symptoms.
Your help is needed to stop this outbreak!
Clue 1

The population of the Ethiopian refugee camp Jengo has surged to over 100,000 refugees, coinciding with the onset of heavy rains and flooding.
You are working with the United Nations' High Commissioner for Refugees to assess the public health and WASH needs of the population (WASH stands for water, sanitation, and hygiene).
This week, the deaths of 2 pregnant women and 1 child are reported in the camp. Both women were in the third trimester of their pregnancies. It is unknown when their symptoms began, but all 3 patients were reported to have the following symptoms: yellow eyes (jaundice), fever, fatigue, and nausea.
Tip

Based on your assessment of the camp so far, you know that:
- Heavy rains have led to swarms of mosquitos and standing water surrounding refugees' tents.
- Flooding in the camp has caused the few latrines (a toilet or outhouse, often used by groups in a camp) to flood, contaminating the groundwater supply with feces.
Camp doctors suspect that the deaths are from yellow fever or malaria, which are common illnesses in the region.
When you learn about these deaths, you worry that you don't yet know what this disease is and when it began.
The camp clinic can conduct rapid tests for malaria, but they don't have the equipment or supplies to test for other diseases.
1. Based on what you know now, what should you do next?
Answer 1: Evacuate refugees to other camps as soon as possible
[Incorrect]
There are over 100,000 refugees in the camp who have nowhere else to go. It would be a huge undertaking to move them before you know exactly what is going on.
Learning more about what the people who are sick have in common may give you some clues about the source of the outbreak. Time to collect more information about the cases. Keep investigating to find out more!
Answer 2: Collect more info about the people who are sick or died
[Correct]
Learning more about what the people who are sick have in common may give you some clues about the source of the outbreak. Good work! Time to start your investigation!
Answer 3: Do autopsies on the 2 pregnant women who died
[Incorrect]
Autopsies are not commonly done in this part of the world. Also, you're a public health investigator, not a doctor! Even for the camp doctors, autopsies may be difficult to do in a refugee camp without the right equipment and supplies. There's no time to waste. You should try to learn more about what the people who are sick have in common as it may give you clues about the source of the outbreak.
Clue 2

Over the next couple of weeks, community health workers identify 8 more patients with yellow eyes. They send the jaundiced patients to the camp clinic, but doctors can't make a final diagnosis. The symptom of jaundice is not unique - patients could have yellow fever, a type of Hepatitis, or even poisoning.
The camp doctors want to know exactly which disease is killing patients so they know which treatments to use, and how to prevent future cases.
Because the camp's lab doesn't have advanced diagnostic tests, blood samples are sent to a specialized laboratory in Nairobi, Kenya for testing. However, it will take weeks to safely transport the samples to the lab and get the test results.
The camp doctors are overwhelmed with people who are sick.
Notes

The clinic is overwhelmed with people of all ages battling watery diarrheal diseases, but most of them do not have jaundice.
Doctors are having a hard time managing the high number of patients with different symptoms.
For now, they are treating all patients by giving them oral rehydration solution, which is water mixed with sugar, salt, and zinc which patients drink to treat dehydration. Sicker patients are hospitalized for IV fluid replacement.
Health Tips

Diarrhea is the passage of 3 or more loose or liquid stools per day. Diarrhea is usually a symptom of a stomach infection, which can be caused by a variety of bacterial, viral, and parasitic organisms.
Infection is spread through contaminated food or drinking water, or from person-to-person because of poor hygiene.
Interventions to prevent diarrheal diseases include safe drinking water, use of improved sanitation, and hand washing with soap; all of which can reduce risk of disease. These types of programs are known as WASH (water, sanitation, and hygiene).
Diarrhea can be treated with oral rehydration solution (clean water, sugar, and salt) and with zinc tablets.
Cases

While you're waiting for the lab to return test results from Nairobi, you have some time to analyze information about the people who have become sick with jaundice.
In the last 2 weeks, 11 patients have been diagnosed with jaundice and 7 have died, but only 4 of the 11 patients have tested positive for malaria. Most of these patients have been experiencing symptoms from 5 - 23 days. 7 patients are female, and 4 are male. The camp clinic also ran rapid tests for Malaria. Now, you are able to see all of the data in one place, so you can look for trends in the data.
Next, you have to ask yourself some tough questions. Do the patients who died have anything in common? Is there any relationship between malaria and this mysterious disease?
2. What does the data tell you?
Answer 1: Children and the elderly are most likely to get jaundice
[Incorrect]
Look at your data again; none of the cases so far are above the age of 35. A couple of children have jaundice, but most of the cases are teens and young adults.
You look at the data more closely and realize that most of the female cases are pregnant women, and 3 out of 4 pregnant women have died - more than any other group. Don't get discouraged, keep working to solve the outbreak!
Answer 2: Malaria is responsible for all jaundice cases
[Incorrect]
Less than half of the jaundice cases also had a positive malaria test. Malaria is endemic (meaning regularly found) in this part of Ethiopia. In areas with endemic malaria, it is important to look for other diseases these patients may also have.
You look at the data again and realize that most of the female patients are pregnant women, and 3 out of 4 pregnant women have died - more than any other group. Keep investigating, people are depending on you!
Answer 3: Pregnant women are more seriously affected by jaundice
[Correct]
Good work, you interpreted the data correctly. Most of the female cases are pregnant women, and 3 out of 4 pregnant women have died - more than any other group. Keep investigating to find out what is going on!
Clue 3

Although the camp clinic was able to run rapid tests for Malaria, it sent samples to another lab for more advanced diagnostic tests. After several weeks, you get a phone call from the lab in Nairobi. You're expecting the test results, but you find out the blood samples you sent weren't kept cold enough while they traveled from the refugee camp to the lab in Nairobi. The lab doesn't want to waste its limited resources testing damaged samples - the test results would be meaningless. That means the lab isn't able to tell you what is making patients sick. But the refugees and camp doctors are still relying on you to help them!
You want to act quickly before the outbreak gets much worse. You're not sure exactly what is causing pregnant women with jaundice to die, but health conditions in the refugee camp are poor. Many infectious diseases have related causes. For example, removing mosquitoes prevents both malaria and yellow fever. You don't know what is causing the jaundice, so you decide to focus on preventing diarrheal diseases, which will have a large impact on the whole camp.
Data

Fortunately, community health workers have surveyed almost 400 people in the camp about hygiene and sanitation practices related to the continuing diarrhea outbreak.
The data shows the cases (people who have had diarrhea) are less likely than the controls (people who have not had diarrhea), to use the recommended amount of chlorine to make their water safe to drink. Cases also are less likely to use a latrine, have soap in the home, or know that drinking untreated drinking water can cause diarrhea.
Health Tips

Why put chlorine in water?
Adding a safe amount of chlorine to water (about one tablet or capful of watered down solution to about 20 liters of water) and waiting 30 minutes before drinking is proven to reduce most bacteria and viruses. Adding chlorine to water is simpler and costs less than other ways to make drinking water safe.
3. What project is most likely to prevent diarrhea?
Answer 1: Give refugees drinking water correctly treated with chlorine
[Incorrect]
Giving refugees drinking water treated with chlorine is one important piece of the puzzle, but it does not solve the other water, sanitation, and hygiene problems in the camp. Refugees also don't have enough handwashing stations or latrines. These problems all contribute to the spread of diarrhea. Helping people with clean drinking water, handwashing, and latrines, is known as WASH, and they work better together. Keep going to solve this outbreak before it gets worse!
Answer 2: Install handwashing stations throughout the camp and add more latrines
[Incorrect]
Installing handwashing stations and adding latrines throughout the camp will help, but it does not solve the whole problem. Refugees also don't have enough access to clean drinking water treated with chlorine. These problems all contribute to the diarrhea problem in the camp. If you only try one or two types of projects, you won't solve the whole problem. Helping people with clean drinking water, handwashing, and latrines, is known as WASH, and they work better together. Keep going to solve this outbreak before it gets worse!
Answer 3: Both A and B
[Correct]
Picking and choosing different projects might be easier, but it won't solve the whole problem. The inadequate number and use of latrines, contaminated drinking water, and lack of good hand hygiene all contribute to the diarrhea problem in the camp, so addressing them together will make the most difference. Helping people with clean drinking water, handwashing, and latrines, is known as WASH, and they work better together. Keep going to solve this outbreak before it gets worse!
Clue 4

As the conflict in South Sudan continues, a new group of refugees settle in Camp Jengo. This new group has not been exposed to the diseases circulating in the camp, so they don't have immunity. Several weeks pass, and the camp improves water, sanitation, and hygiene conditions by installing handwashing stations, adding latrines, and providing clean drinking water treated with chlorine. Community health workers also conduct small group education sessions on the importance of handwashing with soap, using latrines, and drinking treated water. The number of cases of diarrhea and jaundice begins to fall.
Even though you never figured out what exactly was killing pregnant women, you congratulate yourself on a job well done. Just as you are beginning to feel you have solved the outbreak, a reoccurrence happens. Two months later, several more patients have jaundice again, with more pregnant women dying.
You have no choice but to try again to get lab results. You collect more blood samples, and make sure that they are properly packed so they stay at the right temperature on the 3-day bumpy car ride to Nairobi.
Definition

Immunity means the power to keep yourself from being affected by a disease. Exposure to a pathogen (such as a virus or bacteria) triggers the immune system to produce antibodies to a disease. Antibodies are proteins produced by the body that destroy disease-carrying organisms. Antibodies are disease-specific. For example, measles antibody will protect a person who is exposed to measles disease, but will have no effect if he or she is exposed to mumps.
Cases

An epi curve shows the number of cases over a 3-month period of time. During the first month, cases briefly increase, then taper off as WASH projects are implemented. But 2 months later, clusters of cases start to pop up again. What has changed in the camp that could explain this?
4. What could cause this mysterious disease to surge again, months later?
Answer 1: You should have added more latrines in the camp
[Incorrect]
The WASH projects you started had an impact at first. Although it is possible that you could have done a better job with your projects, something else is going on. Keep investigating to solve this outbreak once and for all!
Answer 2: The new group of refugees is in danger of infection
[Correct]
You know that adding latrines, clean drinking water, and handwashing stations were an important step in improving the overall health of the refugees in the camp. Plus, you saw an impact right away when the number of cases began to drop. But the new groups of people arriving in the camp have not been exposed to the virus, so they do not have immunity and are more likely to get sick. Keep investigating to solve this outbreak once and for all!
Answer 3: Refugees are scared to go to the clinics for treatment
[Incorrect]
If refugees were scared to go to the clinic, it would take a longer time to realize that cases have returned, and you wouldn't have such detailed case information. None of the evidence indicates that this is a problem. Keep investigating to solve this outbreak once and for all!
Clue 5

You finally get the test results from Nairobi - it turns out that patients are dying of Hepatitis E. There is no specific treatment for Hepatitis E, but fortunately the water, sanitation, and hygiene (WASH) projects you started to reduce diarrheal disease also help prevent Hepatitis E. The oral rehydration solution given by doctors is also helpful.
Still, Hepatitis E is hard to control: why else would it return after case counts dropped for months? Water, sanitation, and hygiene actions take time to complete. If any piece of a WASH program is unreliable, (for example, cancelled soap deliveries or a lack of chlorine to make water safe to drink), more people will continue to become infected. The camp managers ask you to write a report with recommendations for controlling Hepatitis E, so you begin by looking at the key risk factors.
Data

You open your field laptop computer to analyze the data again to see what the cases have in common.
The table shows that adults between 25-54 years old are most likely to be infected. Nearly half of infected cases had contact with another jaundiced person.
Interestingly, many people who drank surface water got sick, and over twice as many people who got sick also took care of animals. Many cases also shared a latrine with 7 or more other households.
Definition

Hepatitis E is a liver infection caused by the Hepatitis E virus (HEV). In developing countries HEV infection does not result in chronic Hepatitis E. While rare in the United States, Hepatitis E is common in many parts of the world. It is usually associated with contaminated water supply in countries with poor sanitation. After exposure it may take 2-8 weeks for symptoms to appear, and some people have no symptoms at all. Symptoms of Hepatitis E include:
- Fever, tiredness, not feeling hungry, nausea, vomiting, stomach pain, dark colored pee, clay-colored stools, joint pain, and jaundice (yellowing of the eyes)
While it affects all ages, teens and young adults are most likely to get Hepatitis E.
As you've seen in this outbreak, Hepatitis E can seriously affect pregnant women. There is no commercially available Hepatitis E vaccine, and there is no specific treatment. The sickness usually improves when patients rest and get proper food and hydration.
5. What recommendations are most practical for the camp to prevent Hepatitis E?
Answer 1: Drain ponds of standing water in the camp
[Incorrect]
You're right that ponds of standing water are a health threat: they attract disease-spreading mosquitoes, and sometimes people drink dirty water right out of them. But that is just one piece of the puzzle. If you just focus on draining the ponds, it will be a lot of work, and every time it rains you'll have to start over. Most importantly, it does not solve the other water, sanitation, and hygiene problems in the camp. Helping people with clean drinking water, handwashing, and latrines, is known as WASH, and all these projects work better together.
Answer 2: Continue carrying out and improving water, sanitation, and hygiene projects
[Correct]
Even though the other answer choices are also connected to health, choosing just one thing to work on won't solve the whole problem. Hepatitis E and diarrhea spread in many different ways related to poor hygiene, water quality, and sanitation. Constantly draining ponds or taking away people's livelihood by removing all domestic animals are not practical solutions for the camp. Helping people with clean drinking water, handwashing, and latrines, is known as WASH, and all these projects work better together.
Answer 3: Remove all domestic animals from the camp
[Incorrect]
The data shows that people who are around animals are more likely to get sick. But this association doesn't mean that being around animals is causing people to get sick with Hepatitis E. You've observed that young women are likely to do shepherding work in the camp. Young women are also the group most at risk for Hepatitis E. Women watching animals all day don't have access to clean water while they're working, so they are more likely to drink surface water that could be contaminated. Also, it doesn't make sense to take people's income and food away by removing animals from the camp. Removing animals does not solve the main water, sanitation, and hygiene problems in the camp. Helping people with clean drinking water, handwashing, and latrines, is known as WASH, and all these projects work better together.
Learn More

Learn more about the real-life outbreak that inspired this scenario.
This fictional outbreak was based partly on a real outbreak of Hepatitis E in 4 refugee camps in South Sudan. CDC sent experts in emergency response, WASH, and Hepatitis to help solve this outbreak in 2012. They collaborated with the United Nations High Commissioner for Refugees and Doctors Without Borders, as well as other humanitarian health partners. The objectives of their mission were to assess the water, sanitation, and hygiene (WASH) conditions in the camps. This helped to determine if Hepatitis E virus was present in different water sources, the vulnerability of the population to continued spread of this disease, and identified risk factors for infection.
While the disease detectives found that refugees could get clean water, soap, and use latrines, knowledge of jaundice was low, and few households were using enough chlorine in their drinking water to make it safe. About 25% of refugees reported drinking untreated surface water from ponds or streams because of poor water supply in the camp. The team also discovered that over 20% of refugees had recently been infected with Hepatitis E, and more than half of the population was vulnerable to become infected.
Based on their investigation, the team recommended that water, sanitation, and hygiene efforts be strengthened in all of the affected camps. They also suggested doing more investigations to learn more about how taking care of animals is related to the spread of Hepatitis E. Much like in this outbreak scenario, it took a while to figure out what was really going on in the camp. But once they knew which disease they were dealing with, they took action by doing WASH projects to address as many sources of infection as possible.
Back To Top
Mystery at the Border

- Number Sick: 31
- Hospitalizations: 5
- Deaths: 0
- Location: US-Mexico Border
The Arizona Department of Public Health contacts you for help after learning that several people in a rural town in Arizona, near the Mexican border, have developed a rare and grave condition.
Within days of feeling ill, paralysis sets in, making it nearly impossible for patients to breath or move! Five are hospitalized because of their grave condition. What is it? How did they get it? Is it spreading?
Clue 1

Karina is a 22-year-old college student who's studying to become a Spanish professor. She commutes from Renalto, a town in Arizona near the US-Mexico border, to Saguaro, Mexico, Monday through Friday to attend the local university, known for its excellent Spanish curriculum.
About 3 weeks ago in late April, Karina had diarrhea and fever for a few days. She recovered and didn't think much of it. In the past few days she's noticed unusual numbness and tingling in her hands and feet. Her legs started feeling heavy, and she's finding it difficult to walk. Then yesterday she was unable to stand up when she got out of bed, and her arms started feeling weak as well. For the past month, Karina has been experiencing back pain. She suspected that it was from all the stress of finals. She visited her doctor a few weeks ago, but her pain didn't go away. In fact, she is feeling worse!
Frightened by these unusual symptoms, Karina rushes to the emergency room. The doctor isn't sure what it is wrong, but he suspects it might be a rare condition called Guillain-Barré syndrome (GBS). He's treated 3 other patients suffering from a similar ailment this week.
If Karina's doctor confirms that she and the others have GBS, this cluster of cases could indicate something even more serious!
Definition

Guillain-Barré syndrome (GBS) is a rare disorder in which a person's own immune system damages their nerve cells, causing an acute flaccid paralysis, in which people develop weakness in their muscles that worsens over days to a week or so. The affected muscles are limp, and the person has no reflexes when a doctor tests the muscles with a hammer.
GBS can cause symptoms that last for a few weeks to several months. Most people recover fully from GBS, but some people have lasting nerve damage. People sometimes die from problems related to GBS, such as having difficulty breathing when their lung and chest muscles are involved.
Doctors use a series of tests and a patient's history to diagnose a person with GBS. About 1 out of 100,000 people in the United States develops GBS each year. When a person has GBS, they usually have been sick with a different infection first, like a respiratory infection (an infection that affects the lungs) or a gastrointestinal infection (an infection that affects the stomach).
1. What should you do first?
Answer 1: Temporarily close the US-Mexico border crossings
[Incorrect]
It's too soon to close the border since you don't know what's causing this mystery illness and if closing the border will help prevent additional cases. Closing the border would have a big impact on the economy and the daily activities of people who live in the border region.
You need to work with the local health departments in Arizona and Mexico to find out how many people have experienced weakness or paralysis without an obvious cause who may be suffering from GBS. You should monitor the number of people with GBS to see if there is an increase in the number of people getting sick; this is called surveillance.
Answer 2: Isolate patients and ask healthy people to stay home
[Incorrect]
It's too soon to know if isolating patients and having well people stay at home will help prevent them getting this mystery illness. There must be something else you could do!
You should work with the local health departments in Arizona and Mexico to find out how many people have experienced weakness or paralysis without an obvious cause and may be suffering from GBS. You should monitor the number of people with GBS to see if there is an increase in the number of people getting sick; this is called surveillance.
Answer 3: Ask local officials to look for others who are sick with GBS
[Correct]
You need to work with the local health departments in Arizona and Mexico to find out how many people have experienced weakness or paralysis without an obvious cause and may be suffering from GBS. You recommend that local officials look for similar cases in the region to figure out how many others may be affected.
You will then need to monitor the number of people who develop GBS to see if there is an increase in the number of people getting sick; this is called surveillance.
Clue 2

Karina's doctor confirms that she has GBS. The local Arizona health department informs you of 8 more people diagnosed with GBS in April and May, bringing the number to 25. All of them live near the US-Mexico border. This is way more cases than is normal in this area!
What is triggering the onset of these cases?
You decide to form an outbreak investigation team made up of state, local, and federal officials to figure out why so many people are getting sick with GBS. First, you interview the sick patients located on the American side of the border in Renalto, Arizona. Next, alongside Mexican disease investigators, you travel to the local hospitals in Saguaro to speak with the GBS patients so you can review medical records of all those who are sick.
Data

You want to learn more about the people who are sick with GBS, including their symptoms, when they got sick, their recent travel activity, foods they recently ate, and more. It turns out that some patients can't speak with you since they're paralyzed and machines are helping them breathe. Their families help answer questions for them.
After the interviews are completed, you develop a Characteristics and Activities chart. The chart details the responses of the 25 people who are sick, noting the town and country they live in, their age and gender, and which towns they traveled to in the weeks prior to getting GBS.
Several medical records suggest diarrhea, with a few specifically mentioning laboratory-confirmed infections of Campylobacter jejuni.
Definition

Campylobacter jejuni is a species of bacteria that can cause disease in humans and animals. Many infections are associated with eating raw or undercooked poultry, or from eating food contaminated by raw poultry. These infections are also spread by drinking unpasteurized milk, untreated water, or water that is not treated well enough. These bacteria are not usually spread from one person to another, but this can happen if people drink water or eat food contaminated with diarrhea from an infected person.
Campylobacter jejuni infections are one of the most common causes of illness with diarrhea in the United States. Most cases occur as isolated, sporadic events and not as part of recognized outbreaks. Although illness from Campylobacter jejuni is common, with an estimated 1.3 million infections in the United States each year, most cases are not confirmed by laboratory testing.
People who are sick typically have diarrhea, cramping, stomach pains, and fever within 2-5 days after being exposed. Some infected persons do not have any symptoms. The illness usually lasts about 1 week, and most people recover completely without any specific treatment. Campylobacter jejuni infection can sometimes lead to long-term health problems like arthritis or GBS.
Health Tips

Some simple food-handling practices can help prevent infections of Campylobacter jejuni, such as:
- cooking poultry thoroughly,
- washing hands with soap before preparing food and after handling raw foods of animal origin, and
- not drinking unpasteurized milk or water that is untreated or insufficiently treated.
2. What do the sick people have most in common?
Answer 1: Many have been to Renalto, AZ, and had a recent stomach infection
[Correct]
The two things many of the patients in your Characteristics and Activities Chart have in common are that many spent time in Renalto, Arizona, and were ill with diarrhea.
Keep up the good work!
Answer 2: They've all been to San Pedro, Mexico, and had a cold
[Incorrect]
It only looks like two of the people who are sick have been to San Pedro, and there's no mention of anyone having a cold.
The two things many of the patients in your Characteristics and Activities Chart have in common is that many spent time in Renalto, Arizona, and had diarrhea.
Keep working on preventing more people from getting sick!
Answer 3: We don't have enough information to tell yet
[Incorrect]
The two things many of the patients in your Characteristics and Activities Chart have in common is that many spent time in Renalto, Arizona, and had diarrhea.
Keep working on preventing more people from getting sick!
Clue 3

Most patients remember being sick with diarrhea before getting GBS, and a few patients tested positive for Campylobacter jejuni infections.
You decide to learn more about what may have caused the stomach illness, particularly since this type of bacteria can trigger GBS.
There is a report of more people who are sick, so you travel to Renalto, Arizona, to see if you can find more clues to help you find the source of the GBS outbreak.
Cases

The number of people who have GBS climbs to 31.
In Renalto, there are 6 new cases, one of them recently diagnosed with a Campylobacter jejuni infection.
So far, based on your investigation, you feel confident that Campylobacter jejuni infections are responsible for the GBS cases for most, if not all, of the patients.
Now you need to find out how they got sick with these bacteria, and make sure other people don't suffer the same fate.
Data

You interview the 6 new patients in Renalto.
Then, for each of the 31 GBS cases, you try to interview three healthy people who are similar in age and ethnicity to the people who are sick so they can act as controls. You talk to 75 healthy people who serve as controls.
It is important to compare what the people who are sick with GBS ate and drank with what the healthy people (controls) ate and drank, as this can help identify the source of outbreak.
You then calculate and study the odds ratio to see if you can find the source of the outbreak.
Notes

Renalto is a small city in a rural part of southern Arizona. The biggest industries are tourism related to a national park, agriculture, raising cattle, and the military.
Because the area receives very little rainfall, local farms rely on irrigation water from the Colorado River and from groundwater pumped up by wells.
Definition

A case-control study is designed to help determine if being exposed to something (food, water, etc.) is related to the people who are sick. To conduct a case-control study, you must follow the steps below.
- First, identify the people who are sick (this is known as the case group or the group known to have the outcome which is the disease or condition being studied).
- Next, identify healthy people who are similar to the people who are sick (this is known as the control group or the group that is free from the outcome).
- Then, interview the 2 groups to learn which people in each group were exposed to different items.
- Lastly, compare the number of times the people in each group were exposed to an item. You are looking to see if the people who were sick (the case group) were exposed more frequently to an item than the healthy people (the control group).
An odds ratio (OR) is a measure of association between an exposure and an outcome. The OR represents the odds that an outcome will occur given a particular exposure, compared to the odds of the outcome occurring without that exposure. Odds ratios are most commonly used in case-control studies, however they can also be used in other study designs such as cross-sectional and cohort studies (with some modifications and/or assumptions).
3. Based on the data, which of these exposures should you look into next?
Answer 1: The chicken
[Correct]
Chicken is a common source of Campylobacter jejuni infection. Since all the people with GBS had eaten chicken leading up to getting GBS, and a significantly higher number of people with GBS ate chicken than healthy controls, you review the types of chicken that patients reported eating during the interview.
Answer 2: The pork
[Incorrect]
It looks like only 18% of the people with GBS had eaten pork, which isn't that many.
Chicken is a common source of Campylobacter jejuni infection. Since all the people with GBS had eaten chicken leading up to getting GBS, and a significantly higher number of people with GBS ate chicken than healthy controls, you review the types of chicken that patients reported eating during the interview.
Answer 3: The raw (unpasteurized) milk
[Incorrect]
Even though raw (unpasteurized) milk is a common source of Campylobacter jejuni infection, it looks like only 5% of the patients drank raw (unpasteurized) milk, which isn't that many.
Chicken is a common source of Campylobacter jejuni infection. Since all the people with GBS had eaten chicken leading up to getting GBS, and a significantly higher number of people with GBS ate chicken than healthy controls, you review the types of chicken that patients reported eating during the interview.
Clue 4

While investigating whether chicken could be the source of this outbreak, you discover that the people with GBS ate different types of chicken (frozen, fresh, pieces, whole) from various brands sold in big grocery stores on both sides of the border. It turns out that no single store, restaurant, or chain was reported by more than a few patients.
After all this work, chicken doesn't seem to be the source of the outbreak after all! None of the foods that commonly cause Campylobacter jejuni infection seem to be the cause of this outbreak.
But what about water? Both sick and well people drank water in some form (as most people do), and almost all of them had minimal exposure to tap water (for example brushing teeth or showering). Contaminated foods are often distributed far and wide, but contamination of tap water tends to be much more local. Since everyone who is sick spent time in Renalto, Arizona, you decide to investigate the water systems next.
Data

You decide you need to learn more about local water systems. You know just where to start: the environmental health experts.
You and your colleagues meet with water authorities from Saguaro and Renalto, and assemble a team for testing the local water quality.
Together, you review logbooks of water tests from water samples taken from wells, tap water, river water, and irrigation canals in different neighborhoods.
The team also decides to test other sources of drinking water, such as kiosks where people fill large bottles of water.
4. Based on the data, what have you discovered?
Answer 1: No bacteria were found at the waste water treatment plant
[Incorrect]
Look carefully at the log book! Campylobacter jejuni bacteria were found in samples taken from a river downstream from the waste water treatment plant discharge point in Renalto, AZ. This was no surprise since many people had been ill with diarrhea from campylobacter infection. It is common for bacteria to be found in natural waterways around wastewater treatment plants' discharge points. Use caution in interpreting positive results since water bodies can be contaminated by other sources such as droppings from birds or other wildlife, or nearby water streams. Nearby this site is a waterfall located under a known bird migration path.
However, the rest of the locations, including all of the samples taken from drinking water sources and taps, tested negative for the bacteria. Only a few of the sick people drank water from the tap. Most people living in the area drank bottled water or water from the filling kiosks; but the kiosks don't seem to be the problem since no two people who were sick reported using the same kiosk. Also, the municipal tap water is chlorinated and it only takes a little chlorine in water to kill the Campylobacter jejuni.
So you're stumped.
Answer 2: Water testing did not identify the source of contamination
[Correct]
You're disappointed to find that many of the tests come up inconclusive. The only site with a positive result for the Campylobacter bacteria was a river downstream from the wastewater treatment plant discharge point, the rest of the locations tested negative.
It is common for bacteria to be found in natural waterways around wastewater treatment plants' discharge points. Use caution in interpreting positive results since water bodies can be contaminated by other sources such as droppings from birds or other wildlife, or nearby water streams. Nearby this site is a waterfall located under a known bird migration path. While there were two locations where high levels of "total coliform levels" (other types of bacteria) were found, these weren't necessarily the kind of bacteria that make people sick. This is not enough information to identify the source of contamination.
Despite most people having had a minimal level of exposure to tap water (for example brushing their teeth or showering), only a few of the sick people drank water from the tap which made them susceptible to a higher dose of the campylobacter bacteria. Most everyone drank bottled water or water from the filling kiosks, but the kiosks don't seem to be the problem since no two people sick reported using the same kiosk.
Also, the municipal tap water is chlorinated, and it only takes a little chlorine in water to kill Campylobacter. So you're stumped.
Answer 3: There was a lot of bacteria in wells
[Incorrect]
The only site with a positive result for the Campylobacter bacteria was a river downstream from the wastewater treatment plant discharge point, the rest of the locations tested negative. While there were two locations where high levels of total coliform levels of other types of bacteria were found, these weren't necessarily the kind of bacteria that make people sick.
Only a few of the sick people drank water from the tap; most everyone drank bottled water or water from the filling kiosks, but the kiosks don't seem to be the problem since no two people sick reported using the same kiosk.
Also, the municipal tap water is chlorinated, and it only takes a little chlorine in water to kill Campylobacter jejuni. So you're stumped.
Clue 5

After hours of reviewing your notes, it occurs to you … what if there had been a problem with chlorination of the drinking water?
Even if people didn't drink tap water, they may have used it to rinse off some of their food (like vegetables or fruits that people eat raw without peeling).
You decide to look back at what the patients, like Karina, told you about the fruits and vegetables they ate before getting sick. It turns out that the people who are sick with GBS ate more fruits and vegetables that are typically eaten without cooking than the healthy people in the control group.
People could have been exposed to contaminated tap water even if they didn't drink it. You decide to look back at the possibility of tap water contamination since the water samples tested only represented a single point in time. But you still are not sure how the tap water could be the source of the outbreak since chlorine kills Campylobacter jejuni.
Notes

You and your team decide to talk to local water authorities in Renalto, and learn the city gets its water from shallow groundwater wells. The groundwater has metals in it that discolor the water when chlorine is added.
Unfortunately, some people complained after receiving coffee-colored water coming from their taps, so the operators lowered the chlorine dosage to reduce the discoloration because of the chlorine.
The water authorities also mentioned that a recent earthquake wreaked havoc on part of the irrigation canals of Renalto and ruptured sewage pipes in some neighborhoods. They've been working overtime to fix it.
Next, you decide you need to gather more data about the chlorine levels of the water.
Data

Your environmental health colleagues design an environmental study to help determine if groundwater contamination might have been the problem. The environmental study includes:
- Reviewing chlorine log books and the chlorine levels by date and location,
- Reviewing the source of water for the region and a distribution map, and
- Reviewing any environmental events that may have occurred in the time before the outbreak.
The log book shows chlorine levels at 50 homes in Renalto on May 9th and June 1st. You create maps to show the chlorine levels in different sectors of the city.
On the first sampling, on May 9, you notice lower chlorine levels in the far eastern and western sectors than in the rest of the city. You also see that one of the people who has GBS lives near the eastern area. On the next sampling date, June 1, you see there are more areas that had low levels of chlorine, and that most of the people who have GBS live in areas where the chlorine levels are low.
5. At the second chlorine reading, low levels of chlorine were found in drinking water in which section of the city?
Answer 1: The eastern section
[Incorrect]
About a month before people started getting sick, there were heavy rains and flooding in Renalto, and then the earthquake happened. Runoff during the flooding from a local Renalto farm that has many cattle, as well as sewage leaking into the groundwater from burst pipes after the Earthquake could have contaminated ground water. And the water company was so busy responding to burst pipes, they didn't immediately notice that the automatic chlorinator failed, which allowed contaminated water to go from source to tap.
People in certain areas of Renalto may have briefly been at risk for exposure, so anyone exposed to the contaminated tap water (most likely by washing fruits and vegetables that they later ate raw since most people did not drink the tap water) was at risk for getting the Campylobacter jejuni infection. As it turns out, Karina was washing her vegetables in tap water during the time the chlorinator failed.
After looking at all these factors, this outbreak was the result of many things happening at the same time. The perfect storm for an unlikely outbreak!
Answer 2: The southwestern section
[Incorrect]
Low levels of chlorine were found throughout most of the city.
About a month before people started getting sick, there were heavy rains and flooding in Renalto, and then the earthquake happened. Runoff during the flooding from a local Renalto farm that has many cattle, as well as sewage leaking into the groundwater from burst pipes after the Earthquake could have contaminated ground water. And the water company was so busy responding to burst pipes, they didn't immediately notice that the automatic chlorinator failed, which allowed contaminated water to go from source to tap.
People in certain areas of Renalto may have briefly been at risk for exposure, so anyone exposed to the contaminated tap water (most likely by washing fruits and vegetables that they later ate raw since most people did not drink the tap water) was at risk for getting the Campylobacter jejuni infection. As it turns out, Karina was washing her vegetables in tap water during the time the chlorinator failed.
After looking at all these factors, this outbreak was the result of many things happening at the same time. The perfect storm for an unlikely outbreak!
Answer 3: Throughout most of the city
[Correct]
About a month before people started getting sick, there were heavy rains and flooding in Renalto, and then the earthquake happened. Runoff during the flooding from a local Renalto farm that has many cattle, as well as sewage leaking into the groundwater from burst pipes after the earthquake could have contaminated ground water. And the water company was so busy responding to burst pipes, they didn't immediately notice that some of the automatic chlorinators failed, which allowed contaminated water to go from source to tap.
People in certain areas of Renalto may have briefly been at risk for exposure, so anyone exposed to the contaminated tap water (most likely by washing fruits and vegetables that they later ate raw since most people did not drink the tap water) was at risk for getting the Campylobacter jejuni infection. As it turns out, Karina was washing her vegetables in tap water during the time the chlorinator failed.
After looking at all these factors, this outbreak was the result of many things happening at the same time. The perfect storm for an unlikely outbreak!
Learn More

CDC Works 24x7
Although this scenario is not real, there have been other similar binational outbreaks for which CDC worked with another country to investigate an outbreak.
Disease Detectives from local, state, and federal levels in the United States and Mexico worked together in 2011 to determine the reason for what was the largest outbreak of acute flaccid paralysis cases in the Western part of the world at the time. Like this scenario, the real outbreak occurred in a remote region along the US-Mexico border, in the states of Arizona and Sonora (Mexico).
In Mexico, public health experts used national reporting data to identify people with GBS in Mexico. In Arizona, active case-finding and physician outreach helped identify suspected GBS cases. Normally, the expected incidence in the regional population is four people with GBS per year, but between May 4 and July 21, authorities found 31 cases of acute flaccid paralysis; of those, 26 classified as GBS.
Similar to previously documented outbreaks, the evidence collected during this outbreak had many factors that likely led back to an exposure to water, which possibly contained bacteria such as Campylobacter. The Disease Detectives discovered that 2 weeks before suffering paralysis, many of the cases had been sick with diarrhea.
Bacteria in the water supply and the increased risk of illness could have been caused by unfavorable environmental conditions, such as the Colorado River overflowing, a disruption in well pipeline networks, and birds migrating over the region exposing crops and waterways to possible infected feces.
Because of this 2011 outbreak, water and environmental experts from the United States and Mexico worked together to better monitor water quality in the region and prevent future health issues. Lab-testing capacity improved, allowing labs to use new techniques to test for Campylobacter. It was an important milestone in US-Mexico binational outbreak collaboration, and since then, federal, state, and local public health authorities continue to prevent disease in this border region.
Back To Top
Alphabet Soup

- Number Sick: 3525
- Hospitalizations: 749
- Deaths: 10
- Location: Luxembourg
There's a mysterious outbreak in a small country in Northwestern part of Europe. The local public health department is asking for your help.
It's spring and several people have been admitted into the local hospital with pneumonia and flu-like symptoms - high fever, muscle aches, headache, and dizziness. During this same time, a general practitioner from a rural village reported an increase in pneumonia cases among patients in his community.
It's not clear what the outbreak is and how it is spreading. Your help is needed to apply the A-Z's of epidemiology and solve the case.
Clue 1

It's late spring and a 39-year-old history professor named Dieter has been enjoying the spring weather by reading outside, taking long hikes, and going on bike rides through the countryside, zipping past local farms and beautiful scenery.
In early June, Dieter came down with a high fever, headache, and cough. Dieter went to the doctor and was diagnosed with a viral illness and told to go home, drink plenty of fluids, and get some rest. Over the next few days, Dieter's symptoms continued to get worse and he was admitted to a local hospital where he received a chest x-ray and was diagnosed with pneumonia. Dieter was placed on antibiotics, which didn't seem to help make him feel any better. Unfortunately, Dieter is not the only one who is sick.
Notes

While reviewing Dieter's charts, the hospital doctor notices that Dieter is one of 6 patients admitted to the hospital in the last few weeks. All had similar symptoms and none have improved after receiving antibiotics.
One of the other patients, Fionna, a stay-at-home mom who lives on a small cattle ranch was pregnant when she was admitted. After 5 days with a high fever, Fionna had a miscarriage. Blood tests ruled out the most common infectious causes of miscarriage.
The doctor calls the local department of public health, only to learn that Dieter and Fionna are not the only people who are sick. There is a much larger outbreak happening.
Cases

The local department of public health tells you that there are:
- 19 people that have similar symptoms are sick in the city of Madux, including 6 patients in your own hospital
- 5 people are sick in and around Gallinburg
This brings the total number of people sick to 24. Most of the sick are adults, although there are 3 patients under the age of 19.
The people seem to be of different ages, have different careers, live in different regions, and even have different diagnoses. You need to figure out how these people are connected, what is causing this outbreak, and how the outbreak is spreading.
Data

The local health department has begun to collect data on the number of people sick. So far, many people have similar symptoms but the diagnoses are all different.
| Diagnosis | Number of Sick |
| Pneumonia | 15 |
| Hepatitis | 2 |
| Endocarditis | 3 |
| Other (mainly fever) | 4 |
You decide to chart the date that people first became sick in an Epi Curve to see if you can see a trend in the data.
Definition

An epidemiologic curve, or epi curve, is a tool used by epidemiologists (better known as Disease Detectives), while investigating an outbreak. An epi curve can be used to understand how an outbreak is being spread.
While it is still early, it appears that this outbreak is a point source outbreak. In a point source outbreak, people come into contact with the source of the outbreak for a short time (such as a single event). The number of cases increases rapidly and falls slowly, with most of the cases happening around the same time.
1. In a point source outbreak, when do people come into contact with the common source of the outbreak?
Answer 1: Over a long period of time
[Incorrect]
While it is still early, it appears that this outbreak is a point source outbreak. In a point source outbreak, people come into contact with the source of the outbreak for a short time (such as a single event). The number of cases increases rapidly and falls slowly, with most of the cases happening around the same time.
Answer 2: For a short time (in a single event)
[Correct]
While it is still early, it appears that this outbreak is a point source outbreak. In a point source outbreak, people come into contact with the source of the outbreak for a short time (such as a single event). The number of cases increases rapidly and falls slowly, with most of the cases happening around the same time.
Answer 3: There is no common source as it spreads from person-to-person
[Incorrect]
While it is still early, it appears that this outbreak is a point source outbreak. In a point source outbreak, people come into contact with the source of the outbreak for a short time (such as a single event). The number of cases increases rapidly and falls slowly, with most of the cases happening around the same time.
Clue 2

You're not sure what is causing this outbreak. Fionna has been sick for 2 weeks and can't shake off the fever or night sweats. She is also one of 3 people who are now suffering from photophobia (eye sensitivity to light), pain in muscles and joints, and difficulty sleeping.
You also don't know how the sickness is being spread as there are multiple people in one family who are sick, but in other households only one person in a family is sick. You aren't sure if the illness is contagious.
Since Fionna is one of 6 people sick who live on a farm, you decide to ask all of the sick people what kinds of animals they've come into contact with lately.
Cases

The local public health department interviews all the people who are sick and finds that while a fair number of people had contact with household pets and farm animals. However, 57.7% of people sick did not have any contact with animals.
During your interviews, you learn that local veterinarian was called out to a local goat farm about a month ago because of an "abortion storm" (an episode in which several pregnant goats miscarry at about the same time). You find that 7.7% of people who are sick had contact with an animal that had recently given birth or had an abortion.
Definition

A zoonotic disease can be passed between animals and humans. Zoonotic diseases can be caused by viruses, bacteria, parasites, and fungi. These diseases are very common. Scientists estimate that more than 6 out of every 10 infectious diseases in humans are spread from animals.
People can get zoonotic diseases in many different ways, including:
- Having contact with the saliva, blood, urine, or feces of an infected animal
- Being bitten by a tick or mosquito
- Eating or drinking something unsafe (such as unpasteurized milk, undercooked meat, or unwashed fruits and vegetables that are contaminated with feces from an infected animal)
2. Based on the data, how do you think the outbreak is spreading?
Answer 1: Human-to-Human
[Incorrect]
It's too soon to tell what's causing this outbreak. Even though approximately 58% of the people did not have contact with an animal, you can't rule animals out just yet, especially since you just learned about the abortion storm. Keep investigating to find out what's causing this outbreak.
Answer 2: Animals
[Incorrect]
It's too soon to tell what's causing this outbreak. Even though approximately 58% of the people did not have contact with an animal, you can't rule animals out just yet, especially since you just learned about the abortion storm. Keep investigating to find out what's causing this outbreak.
Answer 3: It's too soon to tell
[Correct]
You're correct that it's too soon to tell what's causing this outbreak. Even though around 58% of the people did not have contact with an animal, you can't rule animals out just yet, especially since you just learned about the abortion storm. Keep investigating to find out what's causing this outbreak.
Clue 3

There are more than 50 cases of sick people and the numbers keep rising every day. You haven't figured out what is making everyone sick or how it is spreading.
Although nearly 58% of the sick haven't had any contact with animals, you decide to follow up on the tip about the goat farm where there was an abortion storm a few weeks ago.
Herman, the owner of the farm, says he has about 1,000 goats which produce goat milk and cheeses which he sells throughout the region, including at the local famer's market. In the last 2 months, 35 pregnant goats on his farm have aborted and Herman says his farm is not the only farm to have a recent abortion storm.
Notes

You ask Herman more about the abortion storm, as this can be a sign of infection with a bacteria called Coxiella burnetii which causes a disease called Q fever.
Sheep, goats, and cattle are the animals which typically spread Q fever to people. The bacteria that causes Q fever are shed in the body fluids, including reproductive materials, of infected animals.
Herman mentions that 3 other local farms have also had recent abortion storms. He also tells you that he and his oldest son had flu-like symptoms about a month ago. They never went to the doctor, and they got better after about a week. The other 4 family members never felt sick. You begin to wonder if their sicknesses could be part of the same outbreak you're investigating.
Definition

Q Fever, or Coxiella burnetii, the bacterium which causes Q Fever is usually shed in animals' reproductive fluids, milk products, and manure. It is very hardy and can survive in the environment for long periods and can be spread over long distances by the wind.
Many people who get Q fever will never have symptoms; others will get a bad flu-like illness which will eventually fade. A small percentage of people will develop severe symptoms or a chronic infection. Those with heart conditions are most at risk of developing major complications, and women who were infected during a pregnancy are at risk for miscarriages.
3. What should you do next?
Answer 1: Test the goats for bacterium
[Correct]
Testing the goats for the Coxiella burnetii bacterium is the right answer! This is one test that you have a perfect score on! Before you decide to take additional actions such as quarantine the goats or warning the public, you first need to be certain what is causing this outbreak.
Answer 2: Quarantine the goats
[Incorrect]
Testing the goats for the Coxiella burnetii bacterium is the right answer. Before you decide to take additional actions such as quarantine the goats or warning the public, you first need to be certain what is causing this outbreak.
Answer 3: Warn the public about consuming goat milk and cheeses
[Incorrect]
Testing the goats for the Coxiella burnetii bacterium is the right answer. Before you decide to take additional actions such as quarantine the goats or warning the public, you first need to be certain what is causing this outbreak.
Clue 4

After testing the goats on Herman's farm and the 3 other farms that recently had abortion storms, you discover the goats on these farms are infected with Coxiella burnetii, the bacterium which causes Q fever. Widespread testing of nearby farms reveals that several farms in the area have goats and sheep with Q fever.
Ninety-five people are sick, but the diagnosis have been different for many people. There are several aspects of Q fever that make it challenging for healthcare providers to diagnose and treat. The symptoms vary from patient to patient and can be difficult to distinguish from other diseases.
The symptoms usually develop within 2-3 weeks of exposure, although as many as half of humans exposed to Coxiella burnetii do not show symptoms.
Notes

When the hospital doctor treating Dieter, Fionna, and several others who have similar symptoms, learns that a local farm has recently had abortion storms, caused by Coxiella burnetii, the doctor suspects that the patients might be suffering from Q fever. He orders test results for each of the patients in his care.
As the first positive results come in, the doctor alerts the local health department who promptly informs other doctors and hospitals in the area. As more and more cases are reported to the local health department, you begin to figure out how this outbreak is spreading.
Health Tips

An early diagnosis of Q fever must be made solely on a doctor's suspicion. Since Q fever symptoms are similar to many other illnesses, diagnosing Q fever can be challenging and may be missed.
Lab tests often appear negative in the first 7-10 days of illness. Therefore, healthcare providers must use their judgment to treat patients based on suspicion alone.
Healthcare providers may find important information in the patient's history and physical examination which may aid in the diagnosis. Information such as recent travel to rural or agricultural communities where infected livestock may be present is helpful in making a diagnosis.
Treatment is most effective if started within the first 3 days. Therefore, doctors should never delay treatment until lab tests confirm Q fever.
Data

With 95 people sick with Q fever, you work to figure out what all the people have in common and how the outbreak is spreading. You start by reviewing patients' medical records and interviewing all who are sick.
You learn that most of the people sick are men (60%), aged 40 - 60 years (68%), and that pneumonia was the most common early diagnosis (62%). You also learn that only 3.2% of the patients were working in agriculture and 0.5% in the meat-processing industry. Since there isn't a trend that helps you understand how the outbreak is spreading, you continue your research.
Next, you look at where the goat farms with the abortion storms are located and where the people who got sick live. You notice that many of the sick live within 5 km of an infected farm, but that's still a good distance away. Since you know that Q fever can be spread by the wind, you look at the number of people who got sick each week and overlay the number of days with strong winds in that week. Looking at the data, you notice that during the week where there was a large abortion storm, there were also strong winds. In the 2-3 weeks that followed, there was a large increase in the number of people getting sick.
4. Based on the data, what is the greatest risk factor for developing Q fever?
Answer 1: Drinking unpasteurized goat milk sold at local farmers markets
[Incorrect]
You're exactly right, the greatest risk factor for developing Q fever was the strength of the winds following the abortion storms. You are one savvy detective. Now that you know what is causing this outbreak, how can you help prevent this from happening again?
Answer 2: Coming into contact with someone who works on the goat farm
[Incorrect]
The greatest risk factor for developing Q fever was the strength of the winds following the abortion storms. Now that you know what is causing this outbreak, how can you help prevent this from happening again?
Answer 3: Strength and direction of winds after abortion storms
[Correct]
The greatest risk factor for developing Q fever was the strength of the winds following the abortion storms. Now that you know what is causing this outbreak, how can you help prevent this from happening again?
Clue 5

A disease detective's job is never done! Over the course of the next 3 years, dozens of disease detectives worked to control this outbreak. As one of the largest outbreaks of Q fever in history, it's your job to figure what can be done in the future to control and prevent this from happening again.
To do this, you decide to review all sides of this outbreak to better understand what happened and why. In looking at the data, you see that over the last 3 years, 3,525 people got sick from Q fever and 749 people were hospitalized. During this time, abortion waves because of Coxiella burnetii were reported on 28 goat farms and 2 sheep farms. Some goat farms had abortion rates up to 60%.
Tip

As the lead disease detective on this case, you also need to think about health education and ways to educate the public about Q fever. It's your job to create strategies for educating the public and trying to change health behaviors to prevent a new outbreak.
You recommend and help the government create a mass education program, complete with materials targeted to the public, veterinarians, physicians, and the news media.
Notes

To help stop the spread of Q fever, you recommend to the government various veterinary measures, including new hygiene procedures, limiting the movement of goats/sheep, and placing a temporary ban on new breeding. Based on your research, you believe that these measures will control the outbreak.
However, the federal government decides to make a controversial decision to slaughter more than 50,000 dairy goats on 55 of the country's nearly 400 farms to prevent the disease from spreading further.
Data

Last, you research the effectiveness of the educational campaigns you recommended. You'd like to identify trends and regional differences in public opinions and behaviors. As a disease detective, you want to learn which measures were most effective in improving awareness of Q fever and increasing the number of people who took preventative measures to protect themselves. So, you decide to conduct a study to learn more.
In your study, you find that public knowledge about Q fever increased significantly during the outbreak. You also learn that the assumed severity of the disease also increased among the public.
However, the most surprising thing you learn is that even though more people were aware of the diseases and the severity, there were low levels of vulnerability (only 15% of people thought that they were susceptible to getting Q fever) presumed.
5. Is it a concern that only a few people thought they were vulnerable to getting Q fever?
Answer 1: No, because more people were aware of the disease
[Incorrect]
While you may be a risk taker, it's very concerning that only a small number of people thought that they were vulnerable to getting Q fever. If people do not think they are at risk, they are not likely to comply with preventative measures.
It's important that people perceive a risk (when there is one) and implement health behavior changes to protect themselves. However, you don't want to unnecessarily worry or scare the public. A job of a disease detective is a tricky one and is never done!
Answer 2: Yes, because if people think they are at risk, they are more likely to comply with preventative measures
[Correct]
While you may be a risk taker, it's very concerning that only a small number of people thought that they were vulnerable to getting Q fever. If people do not think they are at risk, they are not likely to comply with preventative measures.
It's important that people sense a risk (when there is one) and implement health behavior changes to protect themselves. However, you don't want to unnecessarily worry or scare the public. A disease detective's job is a tricky one and is never done!
Answer 3: It's too soon to tell
[Incorrect]
While you may be a risk taker, it's very concerning that only a small number of people thought that they were vulnerable to getting Q fever. If people do not think they are at risk, they are not likely to comply with preventative measures.
It's important that people perceive a risk (when there is one) and implement health behavior changes to protect themselves. However, you don't want to unnecessarily worry or scare the public. A job of a disease detective is a tricky one and is never done!
Learn More

Although this scenario is not real, there have been other similar outbreaks in other European countries. This outbreak is not typical, as this outbreak affected a large number of individuals. In fact, the CDC only receives reports of a couple of hundred cases a year as cases of Q fever are grossly under reported.
Since Q fever may resemble other diseases, be mild, or even cause no symptoms in some people, cases of human Q fever are likely under recognized in the United States and elsewhere. Around 3% of the healthy adult U.S. population and 10-20% of persons in high-risk occupations (veterinarians, farmers, etc.) have antibodies to C. burnetii, suggesting past infection.
There are several aspects of Q fever that make it challenging for healthcare providers to diagnose and treat. The symptoms vary from patient to patient and can be difficult to distinguish from other diseases. Treatment is more likely to be effective if started in the first 3 days of symptoms. Diagnostic tests based on the detection of antibodies will often appear negative in the first 7-10 days of illness. Therefore, healthcare providers must use their judgment to treat patients based on clinical suspicion alone.
Back To Top
Spring Break Fever

- Number Sick: 12
- Hospitalizations: 3
- Deaths: 0
- Location: US (1 State)
After an adventurous spring break trip, a group of fraternity brothers have come down with fever, body aches, eye pain, rash, and bleeding! With school back in session, they need to get back on their feet ASAP. Can you find out what's gotten into these feverish frat brothers?
Clue 1

Four days after returning from an epic spring break trip, Craig and 2 of his housemates went to the campus clinic with fever, chills, and body aches. These are common flu symptoms and it is flu season, but there hasn't been much flu on campus this year.
Craig is the first to see the doctor, who runs a rapid test for influenza (flu). The test comes back positive. Knowing that the 3 fraternity brothers are housemates, the doctor thinks that they all probably have the flu. She suggests that they stay in their rooms to avoid getting others sick and get some rest
Cases

When Craig arrived at the clinic he reported pain all over his body, fever, an intense headache, and coughing.
Brian and Jordan, who came to the clinic with Craig, had fevers above 102°F. Brian said it started when he was in class the previous afternoon. He walked into class feeling fine, but suddenly felt like something was wrong, and when class was over he was so tired he headed straight to bed. Jordan said he felt bad earlier in the day, with a headache that didn't let him concentrate.
The next morning, Jordan went back to the clinic feeling worse and with an odd-looking rash on his chest. The doctor was concerned and ordered a flu test.
As Jordan waited for the result, 3 more sick frat brothers came in. Each of them had a fever, two reported splitting headaches and one had nausea. He said he felt like his "bones were breaking"!
These symptoms are concerning and seem less like flu. When Jordan's flu test comes back negative, the doctor calls a Disease Detective for help!
Definition

Nausea (noun): the feeling you have in your stomach when you think you are going to vomit.
1. What should you do next?
Answer 1: Order blood tests
[Correct]
Correct! Getting more information on how the fraternity brothers' bodies are responding to their illness may shed some light on what is causing the sickness, whether it's the flu or something else.
Keep going, you have a lot of work ahead of you!
Answer 2: Prescribe antibiotics
[Incorrect]
Not quite. Right now you don't have any evidence that the fraternity brothers are suffering from an illness caused by a bacteria. Over-prescribing antibiotics is one way that some bacteria develop resistance, so careful decision-making in prescribing antibiotics is important.
Keep going, you have a lot of work ahead of you!
Answer 3: Order influenza tests
[Incorrect]
Not quite. While this could help rule out influenza, some of the brothers are showing non-flu symptoms. Also, Jordan has already tested negative for flu.
By conducting a blood test you can get more information on how the fraternity brothers' bodies are responding to their illness and may shed some light on what is causing the sickness, whether it's the flu or something else.
Keep going, you have a lot of work ahead of you!
Clue 2

The phone at the clinic has been ringing off the hook all day with worried parents calling to find out what is wrong with their sons. Meanwhile, the blood tests come back with evidence of a viral infection that is not the flu.
In the last couple of hours, 3 of the 6 sick fraternity brothers have been admitted to the hospital. Their blood cell counts are low, which can result in severe bruising, nose bleeds, and bloody gums!
To make matters worse, the clinic just found out that there are 4 more sick fraternity brothers with symptoms similar to the other guys!
In the course of interviewing the patients, you find out that 20 fraternity brothers went on a trip to the Caribbean. They had been planning the trip ever since Craig had found a deal on some bungalows near the beach.
Data

You also learn that the fraternity brothers spent 7 days and 6 nights in the Caribbean. They returned to campus on March 22nd, the day before classes were back in session.
To get a better handle on the data you've collected, you make an epidemic curve, which can help you determine the pathogen (bacteria or virus) that's infected the brothers.
Since all of the brothers got sick 2-6 days after returning to campus, you look for a pathogen that has an incubation period (the time from when a person gets infected to the time when symptoms start) of 3 to 12 days.
Definition

An epidemic (epi) curve shows how an outbreak changes over time. It includes:
- Date when a person became sick.
- Number of people who became sick on each day.
Epi curves are updated as new data come in, so they are always changing. The shape of the curve can provide many clues about an outbreak, including how it's spread. Outbreaks can spread in the following ways:
- Point source — the sick people came into contact with the source of the outbreak for a short time. This is kind of outbreak usually has an epi curve with a single peak.
- Continuous common source — the sick people came into contact with the source of the outbreak over a longer period of time (i.e. months, years, etc.). The epi curve increases slowly over a long period of time and might level off.
- Propagated outbreak — there may be an initial common source but then sick people transmit the pathogen to others, creating a larger outbreak. The epi curve may look like a point source curve initially, but then has repeated peaks, which indicate new transmission cycles.
Learn more about epi curves.
Notes

The brothers had to unexpectedly share their bungalows with some annoying mosquitoes, and after 1 night of being bitten, half of the group left and got hotel rooms. But they didn't let this pesky setback ruin their vacation. In fact, they met up every day to hang out and soak up the "island life"–trying local cuisines (including foods that may not have been cooked in the most sanitary conditions), surfing, hiking, and lounging by the pool.
From what they remember, no one felt sick on the trip.
2. Based on the shape of the epi curve, how do you think the brothers got sick?
Answer 1: They were exposed to the same disease source for a long period of time
[Incorrect]
Not quite. If they had all been exposed for a long period of time, their dates of when they first got sick (illness onset) would probably not have been so close together.
Instead, notice how all of the brothers felt sick around the same short period of time. This means that they were exposed to the same disease source for a short amount of time.
Your job now is to find out what they were exposed to that has made them so sick.
But hurry, time is of the essence!
Answer 2: They were exposed to the same disease source for a short amount of time
[Correct]
You nailed it! Since the dates of when each brother first got sick (illness onset) are clustered around each other, it's likely that they were all exposed around the same time. Your job now is to find out what they were exposed to that has made them so sick.
But hurry, time is of the essence!
Answer 3: They passed the disease to each other
[Incorrect]
If the brothers were passing the disease to each other, you would expect to see sporadic dates of when each brother first felt sick (illness onset), which would look like many peaks on the epi curve.
Instead, notice how all of the brothers felt sick around the same short period of time. This means that they were exposed to the same disease source for a short amount of time.
Your job now is to find out what they were exposed to that has made them so sick.
But hurry, time is of the essence!
Clue 3

You take a closer look at the activities each fraternity brother participated in while on vacation. Maybe there is a link between a specific activity and the illness.
The doctor calls to let you know that another fraternity brother stopped by the clinic with similar symptoms as his friends. That brings the total case count to 11!
Data

You organize the list of activities that each fraternity brother did on vacation into a table. Then, you calculate the attack rate for each activity based on those who did and did not participate. If any activity stands out, it may be a potential cause or link to the sickness.
| Attack Rate | = | the number of people who participated in an activity and are sick |
| the total number of people who participated in an activity |
Tip: To identify the likely source of the outbreak, look for an activity that has a high attack rate among those who performed a specific activity AND a low attack rate among those who did not.
3. Based on the information you've gathered, what could be making the brothers sick?
Answer 1: Mosquito-borne diseases
[Correct]
That's right! The brothers who stayed in the mosquito-infested bungalows during the entire vacation were most likely to get sick. So, it seems like you have a mosquito-borne pathogen on your hands.
Keep going, you need to figure out what the disease is!
Answer 2: Water-borne diseases
[Incorrect]
Close, but not quite. Although several of the sick brothers went swimming, not all of them did and many of those who went swimming are well.
What should grab your attention is that the attack rate is highest for the brothers who were in the mosquito-infested bungalows. It looks like mosquitoes could be the cause of all this trouble.
But keep going, you need to figure out what the disease is.
Answer 3: Food-borne diseases
[Incorrect]
Nope. Lots of the brothers, both sick and well, ate at street vendors and in restaurants, so food is less likely to be the culprit. Notice that the attack rate is highest for the brothers who were in the mosquito-infested bungalows. It looks like mosquitoes could be the cause of all this trouble.
But keep going, you need to figure out what the disease is.
Clue 4

After deciding that this outbreak may have been caused by a mosquito-transmitted pathogen, you ask the doctors at the clinic and hospital to order tests for mosquito-borne diseases. A few days later, lab tests for several patients come back positive for dengue virus infection. Dengue viruses are transmitted through the bite of infected mosquitoes. People with dengue can have fever, headache, body and eye pain, weakness, and in some cases bleeding (i.e. bruising and nosebleeds).
The fraternity brothers were probably exposed to the virus at the bungalows, since that's where they all stayed for at least 1 night. While all of the brothers reported at least a few bites, even those who didn't get sick, some may have been bitten by mosquitoes that weren't infected with the virus.
Notes

The species of mosquito that transmit dengue are Aedes aegypti (ay-deez ə-gyp-tai) and Aedes albopictus (ay-deez al-boh-pik-tus), which live in and around homes and typically bite people during the day. Although they are usually most abundant in the summer months, these mosquitoes are present year round. So, people who live in or travel to tropic or sub-tropics regions, including the Caribbean, can get sick with dengue at any time of the year. (Areas where a disease is naturally occurring are referred to as endemic regions).
It usually takes 4-10 days to begin feeling sick after being bitten by an infected mosquito. Common symptoms of dengue include fever, aches and pains, rash, fatigue, and minor hemorrhagic manifestations (e.g., nose bleed, unusual bruising, bleeding from the gums, etc.).
Although there is no specific medication or vaccine available to treat or prevent dengue, seeking medical attention at the early stages of the illness can reduce the likelihood of death for people who may experience more serious symptoms. The best way to avoid getting dengue is to wear mosquito repellent, and sleep in places that have air conditioning and/or screens on windows and doors.
4. What should you do to follow up on this outbreak?
Answer 1: Quarantine the fraternity brothers
[Incorrect]
Unless there is risk of passing the disease directly from person-to-person, and with dengue there is not, it's not necessary to quarantine the brothers.
Instead, the first step is to notify the local health department so they can try to prevent others from getting sick.
Keep going! You're so close to solving the outbreak.
Answer 2: Restrict travel to the Caribbean
[Incorrect]
Not a bad guess, but this is probably going too far. We don't yet know how widespread the dengue activity is in the region, so making a blanket travel restriction is probably not appropriate.
Instead, the first step is to notify the local health department so they can try to prevent others from getting sick.
Keep going! You're so close to solving the outbreak.
Answer 3: Contact the Caribbean island's health department
[Correct]
Right! Although dengue is endemic throughout the Caribbean, the local health department needs to be notified of these cases so that they can try to prevent others from getting sick by initiating mosquito control campaigns (like spraying to kill mosquitoes).
Keep going! You're so close to solving the outbreak.
Clue 5

Now that you've figured out what made the fraternity brothers sick, your job is over, right? Not quite!
You receive a call from the university clinic informing you that another fraternity brother, Alex, has been hospitalized with what they suspect are dengue-like symptoms. However, Alex stayed on campus during spring break and it's been about 3 weeks since the brothers returned from the Caribbean! What's going on?
Health Tips

One of the biggest risk factors for getting dengue is having a household member or neighbor who recently had the illness. This is because the mosquitoes that transmit dengue (Aedes aegypti and Aedes albopictus) live nearby and inside homes. When someone is home sick with dengue, the mosquitoes feed on them and then become infected. After 10 days or so, the mosquitoes become infectious and can transmit the virus to humans when they feed again.
If you reside in a part of the world that has Aedes mosquitoes and live in the same household or near someone who has dengue, it's very important to take the following steps to protect yourself:
- Wear mosquito repellent.
- Stay in housing with air conditioning and/or screens on windows and doors.
- Empty any water-containers that have standing water and can therefore serve as mosquito breeding sites.
- Seek medical care if you experience an illness with fever and tell the doctor that you live close to someone who recently had dengue.
Data

It looks like the fraternity brothers introduced the dengue virus to campus. Since there are mosquitoes in the area that can carry the disease, a few probably bit the sick brothers and are now infecting others. In other words, there's a local dengue outbreak!
To confirm your suspicion that the 2 outbreaks are linked, you update the epi curve to see if the time sequence matches.
5. What should you do next?
Answer 1: Notify the health department
[Correct]
Yes! Before you do anything else, call the local health officials. They need to know about this case so that they can notify health care providers in the area to be on the lookout for dengue cases, and make recommendations to the public.
Well done! You solved the outbreak.
Answer 2: Call the local hospitals to put them on alert for an increases of dengue cases
[Incorrect]
Oops, you're getting ahead of yourself. It's the responsibility of the local health department to notify other hospitals, not the Disease Detective.
Well done though. You solved the outbreak!
Answer 3: Notify the media
[Incorrect]
Although the media may want to know about this outbreak, there are more important steps to take first.
Call the local health department so they can notify health care providers in the area to be on the lookout for dengue cases, and make recommendations to the public.
Well done though. You solved the outbreak!
Learn More

This fictional outbreak scenario was inspired by two real-life outbreaks.
In 2010, US missionaries went on a week-long trip to Haiti. After staying in a house with no air conditioning and windows that had no screens, 7 of the 25 missionaries became ill with dengue after they returned to the US. 5 of the 7 cases were then hospitalized. All of the missionaries recovered, but the patients' physicians and family members were very worried about the "mystery illness" that they all had. CDC's Dengue Branch, including EIS officers, worked with the Nebraska Department of Health and Human Services and Georgia Department of Public Health to investigate the cases, collect specimens, and identify risk factors for infection. It turns out that most of the missionaries didn't know that Haiti was endemic (naturally occurring) for dengue, so they didn't wear mosquito repellent during their visit.
The second part of the scenario was based on recent experiences in south Florida, where travelers returning from the Caribbean introduced the virus. After local mosquitoes bit the infected travelers they transmitted it to other people in Florida, resulting in a local dengue outbreak.
Back To Top
Sick-o Kiddos

- Number Sick: 51
- Hospitalizations: 6
- Deaths: 0
- Location: US (3 States)
You'll need a strong stomach if you want to solve this outbreak!
Twenty-eight people, mostly kids, have come down with a nasty stomach bug in one California county. Diarrhea, vomiting, stomach cramps, the works! This is a bad illness, and the fact that so many people in one county got it quickly is suspicious of a foodborne illness.
There are already 6 people in the hospital. We need your help to find the source before anyone else gets sick, especially if there is a contaminated food still on the market!
Clue 1

It's early June, the last week of school for this California community, and everyone's getting ready for summer break. But the worst illness of the year has waited until now to rear its head!
Over a 3 day period, 1 county health department received reports of 25 kids and 3 adults who are sick with diarrhea, vomiting, fever, and stomach cramps. All but 2 of the sick kids go to the same elementary school. One of the sick adults is a teacher at the school, too.
The health department follows up with the doctors who've been treating the cases and learns that several physicians have ordered lab tests on their patients' stool samples to see what kind of infection is causing their symptoms. The tests indicate Salmonella, a type of bacteria.
The health department then asks the hospital laboratories to send the isolates to the public health laboratory so they can determine the "DNA fingerprint" of the Salmonella bacteria. Just like humans, Salmonella bacteria have unique "DNA fingerprints".
As you compare the test results, you realize that the "DNA fingerprints" match for all of the sick people, which means that they're infected with the same strain of Salmonella. From now on, we'll call this the "outbreak strain".
You need to find out what the source of the outbreak is before more people get sick!
Data

One of the first things you need to do is to make an epidemic curve, which is also known as an epi curve. This shows how an outbreak changes over time. It includes:
- Illness onset, which is the date when a person first became sick.
- Number of people who became sick on each day.
Epi curves are updated as new data come in, so they are always changing. The shape of the curve can provide clues about the possible source of an outbreak.
Learn how to read an epi curve.
Definition

What is Salmonella?
Salmonella is a bacterium that causes an infection called salmonellosis. Most people infected with Salmonella get diarrhea, fever, and abdominal cramps 12 to 72 hours after they're infected. The illness usually lasts 4 to 7 days, and most people recover without treatment.
For some people, like children under the age of 5, people with weakened immune systems, and older adults over the age of 65, the illnesses can be more severe. Sometimes the diarrhea can be so bad that the person needs to be hospitalized. In some cases, the infection can spread from a person's intestines to the blood stream, and can cause death unless treated promptly with antibiotics.
Although the majority of infections are foodborne (e.g., from animal or plant-derived foods), zoonotic (from infected animals) Salmonella infections are an important public health problem.
Notes

DNA is short for deoxyribonucleic acid, which carries genetic information in the cells of animals, plants, bacteria, and some viruses. DNA provides instructions on how living organisms and viruses should look, grow, and sometimes behave. It can also be used to identify one organism from another, just like a fingerprint.
1. What day were most of the sick people likely exposed to Salmonella?
Answer 1: May 16 or sooner
[Correct]
That's right! Because so many of the sick people first felt ill on May 18, and since people usually show symptoms 12-72 hours after being exposed to Salmonella, it's likely that they first got the bacteria on May 16 or a day or so earlier.
Keep investigating before it spreads!
Answer 2: May 18
[Incorrect]
The epi curve shows you that most of the sick people first showed their symptoms on May 18. But because Salmonella usually has an incubation period of 12-72 hours, which is the time it takes after being exposed to a germ to start feeling sick, it's likely that they first got the bacteria on May 16 or a day or so sooner. It also could have been May 17.
Keep investigating before it spreads!
Answer 3: May 19 or later
[Incorrect]
Sorry, most people had already been sick for a day or two by May 19, so this can't be the day they were first exposed to the bacteria. Unless they had a time machine or something.
Keep investigating!
Clue 2

Most of the sick kids go to the town's main elementary school. One of their teachers, Lisa, isn't sick, but she blames herself for the illnesses. She took a large group on a field trip to the local community garden on May 16, and she wonders if the kids ate something bad at the picnic. They had brought boxed lunches from the cafeteria, but she wonders if she left them out in the heat too long before the kids ate them.
She's also worried that some of the kids played in the small stream at the garden, as there were posted signs warning that it might have high levels of bacteria in it.
Data

You interview the sick people and the parents of the sick children to find out what the cases have in common. You need to find out what foods they ate, what activities they did, and what kinds of animals they've been around during the week before they got sick.
Since most of them went on the school field trip, a lot of the cases ate the same foods. You notice that many of them also have pets at home, which can spread germs to people.
In addition to the sick kids who went on the field trip, there are two sick kids and one sick adult who don't seem to have any connection to the school.
Health Tips

To avoid Salmonella infection, be sure to:
- Cook meats, casseroles, and other dishes containing eggs to the proper internal temperature using a food thermometer. Cook eggs until both the yolk and the white are firm. Scrambled eggs should not be runny.
- Avoid foods containing raw (unpasteurized) milk or raw eggs.
- Wash hands, kitchen work surfaces, and utensils with soap and water immediately after they have been in contact with raw meat or poultry.
- Be particularly careful with foods prepared for children under 5 years, older adults over the age of 65, and people with weakened immune systems, including pregnant women.
- If you are served undercooked meat, poultry, or eggs in a restaurant, don't eat it and send it back to the kitchen for further cooking.
- Wash your hands after touching animals or anything in the area where they live and roam.
2. What should you investigate next?
Answer 1: The chicken from the school lunches
[Incorrect]
Sorry, not quite. You might have heard that there have been outbreaks where people got sick from eating chicken contaminated with Salmonella. That's true, and we will keep that in mind, but we should also consider other possible sources.
While it may seem that 14 of the 28 (50%) sick people ate chicken is a high number, there's another activity that occurred even more frequently that may be causing the illnesses. Notice that 26 of the 28 (93%) sick people visited the local community garden before they got sick.
It's time to take a field trip of your own and find out what happened at the community garden!
Answer 2: The community garden
[Correct]
Good answer! While it's true that there have been recent outbreaks of Salmonella infection due to contact with pets (like small turtles and hedgehogs) or from eating contaminated foods, (like cantaloupe, peanut butter, or chicken) you didn't let that fool you.
Instead, you noticed that 26 of the 28 (93%) sick people went to the local community garden before they got sick. That means you need to find out what happened there.
You're doing great. Keep going!
Answer 3: Sick people's pets
[Incorrect]
Good try, but not quite. Perhaps you've heard that there have been past outbreaks where people were infected with Salmonella from pets, including small turtles and hedgehogs. That's true, and we will keep that in mind, but we should also consider other possible sources.
Instead, you notice that 26 of the 28 (93%) sick people went to the local community garden before they got sick.
It's time to take a field trip of your own and find out what happened at the community garden!
Clue 3

Most of the sick people (26 out of 28) went to the community garden. Twenty of them came as part of the school field trip on a Friday, and another 6 went there the next day. You ask one of the teachers, Lisa, more about the field trip to find out what her kids did.
She tells you that 75 kids from her school visited the garden. A gardener showed them where they grow vegetables and flowers, and the kids helped dig holes and plant seeds in the soil. After lunch, they played in a sand box and in an adobe hut. A few visited the chicken coop and a couple others played in the nearby stream. She doesn't think any of them visited the beekeeper's area or the goat pen.
Bad news: 5 more people from the same community have been identified with the outbreak strain of Salmonella! But this doesn't necessarily mean that they were infected by the same source as the earlier group of sick people. You'll need to work quickly to find out if there is a connection between the two groups.
Data

To get a better sense of what it was at the community garden that potentially made people sick, you also need to talk to people who went to the community garden but aren't sick. So you talk to every child (or their parent) and teacher who went on the field trip, whether they later got sick or not.
You need to ask each person what they did at the garden so you can calculate the "attack rate" for each exposure that might have made people sick. So, you quickly to try to contact as many of the sick and well persons who went on the field trip. You were able to interview 20 sick people and 55 people who didn't get sick about what they did at the garden.
| Attack Rate | = | the number of people who participated in an activity and are sick |
| the total number of people who participated in an activity (or did not participate) |
Tip

To identify the likely source of the outbreak, look for a high attack rate among those who participated in a specific activity AND a low attack rate among those who did not participate.
3. Based on your data, which of the following is most likely to blame?
Answer 1: Playing in the stream
[Incorrect]
The kids' teacher may have been worried about the level of bacteria in the stream, but the data did not show that the kids who played in the stream were any more likely to get sick than those that did not.
What should grab your attention are the attack rates for people who played in the sandbox (68%) and people who had contact with the chickens (67%). The attack rates among those who did not do these things are much lower. These higher attack rates mean you should investigate these activities more closely.
You need to take a closer look to solve the outbreak!
Answer 2: Digging in the garden
[Incorrect]
It's true that 19 of the people who dug in the garden got sick. But lots of healthy people did that, too, and there is only a small difference in the attack rates between those who did and those who did not.
What should grab your attention are the attack rates for people who played in the sandbox (68%) and people who had contact with the chickens (67%). These higher attack rates mean you should investigate these activities more closely.
You need to take a closer look to solve the outbreak!
Answer 3: Playing in the sandbox
[Correct]
Great job! You're right, the attack rate for people who played in the sandbox is 68%. The attack rate for those that did not play in the sandbox was only 8%. That is a big difference.
You may have also noticed that people who visited the chicken coop also had a high attack rate at 67%, while the attack rate was only 24% for those that did not. Those two things most likely have something to do with the outbreak.
Keep investigating!
Clue 4

It might seem strange that two seemingly unrelated things would both have pretty high attack rates. But then you talk to one of the workers at the community garden, and it starts to make more sense!
It turns out that the night before the field trip someone forgot to latch the door of the chicken coop. When the gardener showed up early Friday morning, the chickens were loose! They were having a great time digging around in the sandbox and searching for scraps of food under the picnic tables. Since the chickens spent most of the night in and around the sand box, they left chicken droppings behind. They were eventually rounded up and put away in their coop just before the school kids arrived.
Notes

It's important to remember that you don't have to eat contaminated food to get sick with a Salmonella infection. You can also get it from live animals that carry the bacteria in their intestines or on their bodies whether they have skin, scales, feathers, or fur. Also, anywhere the infected animals live and roam can be potentially contaminated with harmful bacteria that can make people sick even if they didn't touch the animals.
Laboratory tests confirm that the community garden's chickens have the same strain of Salmonella as the sick people. So it's safe to say that the infected chickens spread their germs around the garden when they escaped from their coop. Since the chickens spent a lot of time in the sandbox, the kids who played in the sand and later put their hands in their mouths or noses (yuck!) were most likely to get sick.
Other people may have gotten infected if they touched the chickens or anything in the coop area without washing their hands afterward.
Cases

Your colleagues at the Centers for Disease Control and Prevention have been carefully monitoring PulseNet, a national database of bacterial DNA fingerprints to see if anyone else has been infected with the outbreak strain of Salmonella. Sure enough, there are 18 other people who have been infected with Salmonella with the same DNA fingerprint but they live in Missouri and Wyoming, hundreds of miles from California!
Your colleagues in Missouri and Wyoming work to contact the 18 sick people to find out what they might have in common with the ill people in California.
4. What is most likely true about the sick people in Missouri and Wyoming?
Answer 1: They've recently been near chickens
[Correct]
That's right. Since the sick people in California got infected with the outbreak strain of Salmonella from chickens, there's a strong chance that the new cases in these other states got it that way as well. But we'll need to do some investigating first to find out.
You've almost figured it out, only one step to go!
Answer 2: They've been to local community gardens
[Incorrect]
Remember, it wasn't the garden itself that got people sick, it was the chickens!
Since the sick people in California got infected with the outbreak strain of Salmonella from chickens, there's a strong chance that the new cases in these other states got it that way as well. But we'll need to do some investigating first to find out.
You've almost figured it out, only one step to go!
Answer 3: They've been on local field trips
[Incorrect]
Remember, it wasn't the field trip itself that got people sick, it was the chickens!
Since the sick people in California got the outbreak strain of Salmonella from chickens, there's a strong chance that the new cases in these other states got it that way as well. But we'll need to do some investigating first to find out.
You've almost figured it out, only one step to go!
Clue 5

You need to figure out how the sick people in Missouri and Wyoming became ill with the outbreak strain of Salmonella.
Your colleagues in Missouri and Wyoming are able to interview the additional 18 sick people, and you learn that 16 of the 18 people recently had contact with chickens. In fact, 11 of the 16 said they have chickens in their backyards, and they tell you they recently bought these chickens from several different feed stores. (Feed stores are places where people can buy some types of animals, animal feed, and farm supplies.)
The next thing you try to find out is where the people in California, Missouri, and Wyoming got their chickens.
Cases

You learn that all of the feed stores identified in the traceback investigation got their chickens as baby chicks from the same mail-order hatchery in Kansas, as did the community garden in California. A mail-order hatchery is a company that hatches and sells baby chicks, ducklings, and other baby poultry to consumers and feed stores.
It turns out that the mail-order hatchery supplies chicks to customers in Wyoming, California, and Missouri. The outbreak strain of Salmonella likely started at the mail-order hatchery and infected the chicks, which were then shipped to feed stores. People who bought the chicks from feed stores brought them home and got infected.
To confirm your theory, you travel to Kansas to conduct tests for Salmonella bacteria at the hatchery. Not only do you find Salmonella at the hatchery, it matches the DNA fingerprint of the outbreak strain that infected the sick people in California, Wyoming, and Missouri.
Definition

A traceback investigation is conducted to find the ultimate source of contamination during an outbreak. Information is gathered such as purchase receipts, invoices, and shipping records to determine where the outbreak first started. These investigations usually involve many partners in human and animal health agencies at the local, state, and federal level.
The information gathered during traceback investigations can also help suggest ways to prevent similar outbreaks from happening in the future.
Health Tips

To help avoid Salmonella infection from live poultry, follow these simple tips:
DO
- Wash hands thoroughly with soap and water right after touching live poultry or anything in the area where they live and roam. Use hand sanitizer if soap and water are not readily available. (Adults should supervise hand washing for young children).
- Clean any equipment or materials associated with raising or caring for live poultry outside the house, such as cages or feed or water containers.
DON'T
- Don't let children younger than 5 years of age, older adults, or people with weakened immune systems handle or touch chicks, ducklings, or other live poultry.
- Don't snuggle or kiss the birds, touch your mouth, or eat or drink around live poultry.
- Don't let live poultry inside the house, in bathrooms, or especially in areas where food or drink is prepared, served, or stored, such as kitchens or outdoor patios.
- Don't give live baby poultry as gifts to young children.
5. What should you do to prevent this outbreak from spreading?
Answer 1: Advise people not to eat chicken for 2-3 months.
[Incorrect]
There's no reason people should avoid eating chicken, as you don't have any evidence that this strain of Salmonella has infected raw poultry that's sold as food.
Instead, you need to:
- Communicate to the public about the outbreak and its source so that customers who recently ordered chickens from this hatchery can take precautions to avoid becoming ill.
- Coordinate with local public health and agriculture officials in Kansas to work with the hatchery to put interventions in place to eliminate this strain of Salmonella and prevent future outbreaks.
Your hard work helped solve the outbreak!
Answer 2: Recommend that people not keep chickens in their yards
[Incorrect]
People may want to keep their own chickens, if local ordinances permit it. They just need to make sure they're following safety tips, like washing their hands after touching chickens and their environments.
What you need to do next is:
- Communicate to the public about the outbreak and its source so that customers who recently ordered chickens from this hatchery can take precautions to avoid becoming ill.
- Coordinate with local public health and agriculture officials in Kansas to work with the hatchery to put interventions in place to eliminate this strain of Salmonella and prevent future outbreaks.
Your hard work helped solve the outbreak!
Answer 3: Find out who else bought chickens from the hatchery
[Correct]
That's right! The next thing to do is figure out who else bought chickens from the Kansas hatchery. Those chickens could be infected too, which means the new owners could get sick. You'll need to communicate to the public about the outbreak and its source so that customers who recently ordered chickens from this hatchery can take precautions to avoid becoming ill.
Also, it's important to coordinate with local public health and agriculture officials in Kansas to work with the hatchery to put interventions in place to eliminate this strain of Salmonella and prevent future outbreaks.
Congratulations, you solved the outbreak!
Learn More

Your hard work helped solve this outbreak!
Though this scenario is not real, it's based on recent outbreaks involving live poultry. Remember that you can become infected with Salmonella not only from contaminated foods but also from live animals and their environments.
In addition to live poultry, there have been recent outbreaks in the U.S. linked to chickens, ducklings, hedgehogs, small turtles, and frogs.
In recent years, more people have been putting chicken coops in their backyards and buying their own chickens to hatch eggs or use for meat. If you and your family have chickens or are considering getting chickens, be sure to learn and follow safety tips about how to handle your birds, and always wash your hands after coming into contact with chickens or their environment.
It is also important to never bring chickens and other live poultry inside your house, in bathrooms, or especially in areas where food or drink is prepared, served, or stored, such as kitchens, or outdoor patios.
Clean any equipment or materials associated with raising or caring for chickens and other live poultry outside your house, such as cages or feed or water containers.
These recommendations are important and apply to all live poultry regardless of the age of the birds or where they were purchased.
Your doctor, veterinarian, and other groups such as extension agents and 4-H leaders, are also an excellent resource about the risk of human salmonellosis from contact with live poultry and how to reduce that risk.
Note: Aspects of the original outbreaks and investigations have been altered to fit the format and length of this application.
Back To Top
Lockdown Blues

- Number Sick: 11
- Hospitalizations: 1
- Deaths: 0
- Location: US (1 State)
Prison lock down! Hundreds of inmates in a Texas prison may have been exposed to a highly contagious rash. One prisoner has been hospitalized and one prison guard has contracted the rash. Inmates are confined to their cells and no visitors are allowed to enter the prison. This has led to substantial disruptions in routine prison activities and court cases grind to a halt with cases and exposed inmates prohibited from leaving the prison for scheduled court hearings.
We need your help. Your mission is to find out what the disease is and how to stop it.
Clue 1

Sam is an inmate and kitchen staff member at Bensil federal prison. One night, while loading dishes, he notices a rash with a few itchy blisters on his arm. He goes back to his cell and finds more blisters on his chest and stomach so he decides to visit the prison's health clinic. The doctor thinks Sam has bug bites, since there's been a recent problem with bed bugs in the prison. He sends Sam back to his cell with cream for his skin rash. The next day Sam is feeling a little better and goes back to work in the kitchen.
Over the next two weeks, 9 other inmates complain of not feeling well and very itchy rashes that have kept them up all night. Some have also had fever and felt very tired. Greg, a prison guard, has also developed a rash with fever. All of the sick inmates rush to the health clinic demanding creams, pills, basically anything that will relieve the itchiness and fever.
Since there are many cases of rash illness occurring in a short period of time, the doctor suspects that he may have an outbreak on his hands. There are many things that can cause rashes, but the doctor suspects chickenpox.
Cases

You start your investigation by checking the medical logs and records of any inmate who was treated for a rash in the prison health clinic in the last 4 weeks. Since you think this might be chickenpox, you look up the chickenpox clinical case definition: An illness that includes a rash with red bumps and/or fluid-filled blisters that are all over the body (generalized) without another known diagnosis.
Based on the clinical definition, you organize the medical records of the inmates that have rashes into two piles, probable cases and confirmed cases of chickenpox. You also start to collect specimens, like blister fluid and scabs from as many cases as possible for lab tests to help you figure out what's causing the rashes.
Definition

What is a clinical case definition?
A clinical case definition is used to figure out who should be included in an outbreak investigation. A different case definition is used depending on the type of suspected illness.
The clinical case definition for chickenpox is: An illness that includes a rash with red bumps and/or fluid-filled blisters that are all over the body (generalized) without another known diagnosis.
In this situation, the clinical case definition for chickenpox is used to figure out who has the disease, which is known as a confirmed case and who might have the disease, which is referred to as a probable case.
- Confirmed case of chickenpox: A person who has a positive lab test or has symptoms of chickenpox (meaning that they meet the clinical case definition) and is linked to another confirmed or probable case.
- Probable case of chickenpox: A person who has symptoms of chickenpox (meaning that they meet the clinical case definition) but does not have a positive lab test or is not linked to another probable or confirmed case.
Notes

Chickenpox is caused by a virus that spreads easily from an infected person to others who have never had the illness or received the chickenpox vaccine. It can be spread by:
- Breathing in virus particles that come from chickenpox blisters or by the cough or sneeze of an infected person.
- Touching the virus particles that come from chickenpox blisters.
It takes 10 to 21 days after exposure for someone to develop chickenpox.
Symptoms usually include:
- Blister-like rash
- Itching
- Tiredness
- Fever
A person is infectious, meaning they can spread the disease, starting 1 to 2 days before they get the rash, up until all of their chickenpox blisters have formed scabs. Chickenpox can be serious, especially in babies, adults, and people with weakened immune systems. Some people develop complications, like pneumonia, which can lead to hospitalizations, and even death.
1. Now that you suspect chickenpox, what are some of the next steps you should take?
Answer 1: Collect samples from probable & confirmed cases, examine every inmate, and separate everyone
[Incorrect]
Not so fast. You were right to collect specimens from cases to confirm that they have chickenpox. But you don't want to waste a lot of time examining every inmate, especially since there are hundreds of inmates in the prison.
Focus only on inmates you think had close contact with a probable or confirmed case. And definitely don't quarantine everyone, especially if they aren't sick, or weren't exposed.
Let's go, you've got work to do!
Answer 2: Isolate & collect samples from probable & confirmed cases, and identify & quarantine exposed persons
[Correct]
You want to isolate the people who are considered probable and confirmed cases of chickenpox to stop the disease from spreading.
If you Identify and quarantine exposed inmates you can keep an eye on these individuals to see if they develop the disease and if they should get vaccinated to help protect them. Also, separating inmates who are at risk of developing disease, allows you to prevent others from getting sick.
Since you suspect chickenpox, collecting and testing specimens will help you confirm your suspicion.
Let's go, you've got work to do!
Answer 3: Isolate probable and confirmed cases, quarantine exposed persons, and vaccinate everyone
[Incorrect]
You were right to isolate probable and confirmed cases to stop the disease from spreading. You were also right to quarantine exposed inmates. However, you don't want to spend lots of time and money vaccinating every inmate in prison. Many of the inmates most likely had chickenpox as a child and don't need to be vaccinated.
Let's go, you've got work to do!
Clue 2

You receive word that Sam's kitchen supervisor has been hospitalized with pneumonia and has a severe rash, with hundreds of blisters covering his body.
In order to learn more about the disease that's devastating the prison, and identify who may have been exposed and who needs to be placed in quarantine, you interview and gather information from the confirmed and probable cases. Then, you create a line list to figure out where the outbreak may have started and where you should focus your investigation.
As you work, 5 more inmates visit the clinic with a rash on their hands and arms. With these new cases popping-up, it doesn't look like the prison lockdown will end anytime soon. The prisoners are getting restless and medical supplies, like anti-itching creams, are running low!
Better work fast!
Data

A line list is a table that has key information about each sick person. Each row represents a case (sick person), and each column has important information about the case, like age, sex, and symptoms. Other characteristics like where a person lives or works can also be included in a line list to help determine what characteristics put a person at higher risk of becoming a case.
2. Based on data from the line list, where should you focus your investigation?
Answer 1: Laundry
[Incorrect]
Sorry, you need to study your data more closely. Less than half of the cases worked in the laundry room while most of the cases live in Unit A.
There also seems to be subtle differences in some of the inmates' symptoms. Notice that the last 5 cases don't meet the clinical case definition of chickenpox. They do NOT have a rash all over their body! This makes you think you may be dealing with two different illnesses. You need to quickly figure out what the second illness is and stop it, especially if it's contagious. Otherwise, there could be 2 different outbreaks happening at the prison!
No time to spare, let's see if the lab results can shed some light on what's really going on.
Answer 2: Kitchen
[Incorrect]
You need to study the data more closely. The kitchen may seem like a good place to start since that's where Sam worked. However, not many of the other cases worked in the kitchen. It looks like you should look into living quarters instead.
But wait, there also seems to be subtle differences in some of the inmates' symptoms. Notice that the last 5 cases don't meet the clinical case definition of chickenpox. They do NOT have a rash all over their body. This makes you think you may be dealing with two different illnesses. You need to quickly figure out what the second illness is and stop it, especially if it's contagious. Otherwise, there could be 2 different outbreaks happening at the prison!
No time to spare, let's see if the lab results can shed some light on what's really going on.
Answer 3: Unit A
[Correct]
Great job! You carefully studied the data and noticed that most of the cases live in Unit A.
You may have also noticed subtle differences in some of the inmates' symptoms. While the line list shows that most inmates have the same rash location and red bumps, the last 5 cases don't meet the clinical case definition of chickenpox. They do NOT have a rash all over their body!
This makes you think you may be dealing with two different illnesses. You need to quickly figure out what the second illness is and stop it, especially if it's contagious. Otherwise, there could be 2 different outbreaks happening at the prison!
Let's see if the lab results can shed some light on what's really going on.
Clue 3

Lab results are back and confirm that the hospitalized prisoner along with the sick inmates from Unit A and the guard have chickenpox. However, the 5 inmates from the other housing units do not. Their lab results are negative for chickenpox.
You remember from the line list that all 5 inmates work in the laundry room. After a short interview with one of them you learn that the prison recently changed laundry detergents. Since each inmate only has a rash on their hands they have been diagnosed with contact dermatitis.
Now you can focus your efforts on the inmates in Unit A, since that's where all of the confirmed cases live. You consider all Unit A inmates exposed, which is about 100 people. But you discover that only 21 inmates had close contact with cases, so you quarantine them immediately.
Notes

What is contact dermatitis?
Contact dermatitis is a condition where the skin becomes red, sore, or irritated after touching something that you're allergic to or an irritant (such as a chemical). It's not life threatening, but can be very uncomfortable. It can lead to itchy or burning rashes.
Contact dermatitis isn't contagious, which means it can't spread from one person to another. The rash only appears soon, sometimes even minutes, after touching something that you're allergic to. The rash usually occurs only on the part of the body that touched the substance.
Contact dermatitis can be mistaken for chickenpox since both lead to an itchy rash with red bumps. Both can also initially start in only one location. However, the chickenpox rash will usually spread to the rest of the body.
Cases

The guards are overworked and tired from working double shifts to monitor the inmates in isolation and quarantine. Even worse, inmates are becoming restless and unruly because they can't have any visitors or even have their meals in the cafeteria. You need to quickly figure out who of these 21 inmates is at risk for getting chickenpox and who has evidence of immunity (protection against chickenpox). This will help you decide who should be removed from quarantine.
Definition

Evidence of immunity to chickenpox means a person has proof of protection against the disease. If you meet at least 1 of the following criteria, then you have evidence of immunity to chickenpox:
- You were born in the United States before 1980.
- You received 2-doses of chickenpox vaccine.
- You have laboratory evidence of having the disease in the past or you have confirmation of current disease from a laboratory.
- You have confirmation from a healthcare provider that you have had chickenpox or shingles in the past.
You DO NOT have evidence of immunity to chickenpox if you do not have any of the above.
Birth in the United States before 1980 should not be considered evidence of immunity for health care personnel, pregnant women, and immunocompromised persons.
Data

You create another table to figure out who among the 21 exposed inmates have evidence of immunity.
3. How many exposed prisoners in Unit A have evidence of immunity?
Answer 1: 13
[Correct]
The 3 inmates who previously had chickenpox and the 8 inmates born in the United States before 1980 have evidence of immunity. Also, the inmates who've had 2 doses of chickenpox vaccine also have evidence of immunity. That makes 13 in all who can be removed from quarantine.
But for the people who've never had chickenpox or only got 1 dose of the chickenpox vaccine, they don't have evidence of immunity and must remain in quarantine for 21 days after their last exposure to a case. Talk about bad news.
Answer 2: 11
[Incorrect]
The 3 inmates who previously had chickenpox and the 8 inmates born in the United States before 1980 have evidence of immunity, which makes a total of 11. But, don't forget about the people who've had 2 doses of the chickenpox vaccine, they have evidence of immunity too. That makes 13 in all that can be removed from quarantine.
But the inmates who've never had chickenpox or only got 1 dose of the chickenpox vaccine, they don't have evidence of immunity and therefore need to remain in quarantine for 21 days after their last exposure to a case. Talk about bad news.
Answer 3: 15
[Incorrect]
Let's double check the numbers. The 3 inmates who previously had chickenpox and the 8 inmates born in the United States before 1980 have evidence of immunity. The inmates who've had 2 doses of the chickenpox vaccine also have evidence of immunity. That makes 13 in all who can be removed from quarantine.
The inmates who've never had chickenpox or only got 1 dose of the chickenpox vaccine do not have evidence of immunity and therefore need to remain in quarantine for 21 days after their last exposure to a case.
By letting a few more out of quarantine, you risk the chance of having more people get sick with chickenpox.
Clue 4

Just as you're getting a handle on the situation at Bensil, you receive a call from Gaplin Prison, which is another correctional facility in the area. Eight inmates at Gaplin have chickenpox! You immediately wonder if the two outbreaks are linked. After all, prisons share staff and inmates are sometimes transferred between prisons. You head to Gaplin to learn more about the inmates with chickenpox and what could have started the outbreak.
Cases

You learn that Carl, one of the inmates with chickenpox from Bensil, was on the same bus with inmates from Gaplin 7 days before his rash developed. The bus was pretty full, so he sat right next to a few of the Gaplin prisoners during the ride.
Moreover, Greg, the sick guard from Bensil prison also works at the Gaplin facility. Greg is newly married and has a baby on the way so he picks up extra shifts whenever he can. He was on duty at Gaplin the day before he developed a rash.
Data

To find out who caused the outbreak you need to know when it started. After speaking with the sick Gaplin prisoners you find out that the first inmate became sick on March 11. To see if the two outbreaks are related you make an epi curve showing the chickenpox outbreak at each prison.
Definition

What's an epidemic curve (epi curve)?
An epi curve shows how an outbreak changes over time. It includes:
- Date when each person became sick.
- Number of people who become sick on each day.
Epi curves are updated as new data come in, so they are always changing. The shape of the curve can provide clues about the possible source of an outbreak, or how the outbreak may have started. It also helps to show you whether the outbreak is reaching a peak or if it's coming to an end.
Learn how to read an epi curve.
4. Who do you think most likely spread the disease to Gaplin prison?
Answer 1: Carl, the inmate
[Incorrect]
Sorry! But Carl didn't spread the disease to Gaplin prison. Carl was on the bus 7 days before his rash started. People are infectious (can spread this disease) 1 to 2 days before the rash develops, up until all their chickenpox blisters have formed scabs. This means Carl could not have spread the disease to the Gaplin inmates on the bus ride.
You are getting close to ending this outbreak, only one more clue!
Answer 2: Greg, the guard
[Correct]
You got it! Greg spread the disease to Gaplin prison because he was on duty the day before his rash started. A person with chickenpox can spread the disease 1 to 2 days before they get the rash, up until all their chickenpox blisters have formed scabs. Since Greg was working at Gaplin prison 1 day before his rash started, he likely spread the disease to Gaplin prison.
You are getting close to ending this outbreak, only one more clue!
Answer 3: Both Greg and Carl
[Incorrect]
Sorry but a person with chickenpox can spread the disease 1 to 2 days before they get the rash up, until all their chickenpox blisters have formed scabs. Carl, the inmate, did not spread the disease since he was on the bus 7 days before his rash started. However, Greg was on duty at Gaplin prison the day before his rash started. So he caused the chickenpox outbreak at Gaplin prison.
You are getting close to ending this outbreak, only one more clue!
Clue 5

It's been 28 grueling days of quarantine for the exposed prisoners and relentless double shifts for the guards! The prison wardens at both facilities are anxious to return to their normal routines and activities. The inmates are eager to be let out of their cells and have visitors again.
While in quarantine, 3 of the 8 exposed Bensil prisoners ended up getting sick with chickenpox. The others did not.
Now that you know what the disease is and how it spread, you work to make sure the outbreak is completely over.
5. What else should you do to stop the spread of chickenpox and end the outbreak?
Answer 1: Vaccinate exposed inmates who are not protected against chickenpox
[Correct]
Correct! People who have evidence of immunity do not need to be vaccinated. Now you can focus on vaccinating exposed people who are not protected against chickenpox and end the outbreak. This includes inmates who have never had chickenpox or only had 1 dose of chickenpox vaccine.
It's also important to work with the prison to develop a comprehensive prevention plan to avoid outbreaks like this in the future. The plan should include chickenpox education for staff and inmates, early detection, isolation of cases and quarantine of exposed persons, as well as vaccination of persons who are not protected against chickenpox.
Congratulations, you solved the outbreak! The inmates, staff, and all their families thank you for your hard work.
Answer 2: Vaccinate those who got chickenpox
[Incorrect]
Vaccination is important but people who have evidence of immunity do not need to be vaccinated. Only people who have never had chickenpox or only had 1 dose of the chickenpox vaccine need to be vaccinated.
It's also important to work with the prison to develop a comprehensive prevention plan to avoid outbreaks like this in the future. The plan should include chickenpox education for staff and inmates, early detection, isolation of cases and quarantine of exposed persons, as well as vaccination of persons who are not protected against chickenpox.
Congratulations, you solved the outbreak! The inmates, staff and all their families thank you for your hard work.
Answer 3: Vaccinate everyone who was exposed to chickenpox
[Incorrect]
Vaccination is important but not everyone needs to be vaccinated. Only people who do not have evidence of immunity need to be vaccinated. This includes inmates who have never had chickenpox or only had 1 dose of the chickenpox vaccine.
It's also important to work with the prison to develop a comprehensive prevention plan to avoid outbreaks like this in the future. The plan should include chickenpox education for staff and inmates, early detection, isolation of cases and quarantine of exposed persons, as well as vaccination of persons who are not protected against chickenpox.
Congratulations, you solved the outbreak! The inmates, staff and all their families thank you for your hard work.
Learn More

This outbreak was fictional but parts of it were based on real-life events. During January and February 1989, 3 cases of chickenpox occurred at the Federal Correctional Institution in Lexington, Kentucky. At the time of the outbreak, 1,276 inmates were housed in the facility.
The first case of chickenpox developed in a 25-year-old woman who was visited by her 8-year-old daughter who had chickenpox. The second case occurred a few weeks later in a 23-year-old who styled the hair of the first case within 24 hours of case 1 developing a rash. The third case was identified in a 19-year-old woman who had class with the second case.
The investigation found that 99% of the inmates had protection against chickenpox. Despite this high number of inmates protected against the disease, this outbreak shows how prison conditions, including close living quarters, are ideal for the spread of a highly contagious disease, like chickenpox.
Developing a chickenpox prevention plan is one way for the prison to avoid outbreaks in the future. The prevention plan should include education of staff and inmates, early detection, isolation of cases and quarantine of exposed persons, as well as vaccination of persons who are not protected against chickenpox.
Back To Top
Fever in the Field

- Number Sick: 72
- Hospitalizations: 11
- Deaths: 1
- Location: US (1 state)
There's a new outbreak starting in the middle of the country, and your help is needed to make sure it doesn't spread!
It's early May in a small, rural county in the Midwest. School kids are getting sick with what seems to be a new illness that is spreading fast. Your help is needed to contain it before it becomes more widespread!
Clue 1

Laura is a 16-year-old high school junior who hopes to go to college on a softball scholarship in a couple of years. She's been practicing for her upcoming softball game, when suddenly she and two of her teammates come down with a fever, cough, and extreme tiredness. Worried, the softball coach sends the girls home. Five other students also come down with similar symptoms on the same day.
Desperate to get better and not miss another game, Laura and her friends head to the urgent care clinic to get checked out. While doctors are waiting for test results, more calls start coming in about similar illnesses.
Data

You gather medical records of the 15 sick people and ask them questions to see what they have in common.
Most of them have the following symptoms:
- Cough
- Sore throat
- Weakness
- Fever (as high as 105 degrees)
One person also has nausea, and 2 others feel light-headed and dizzy.
1. Which of the following is true?
Answer 1: Most of the sick are teenagers
[Correct]
You're right! 11 of the 15 sick people are teenagers. You're not sure if this is a coincidence or if age has something to do with the outbreak. It's definitely worth exploring further.
Keep working to figure out the illness and how everyone got sick!
Answer 2: Most of the sick are kids younger than 13
[Incorrect]
Sorry, but most of those who are sick are teenagers. With 11 of the 15 patients being between the ages of 13 and 18, age may have something to do with the outbreak. It's definitely worth exploring further.
Keep working to prevent this outbreak from spreading further!
Answer 3: Most of the sick go to Freemont High
[Incorrect]
It's true that a lot of the sick people go to school at Freemont High: 7 out of 15. But that doesn't count as "most."
Here's what should grab your attention: 11 of the 15 sick people are teenagers.
You'll need to do some more digging around to figure out if age has anything to do with the outbreak.
Keep working to prevent this outbreak from spreading further!
Clue 2

The illness is spreading quickly. There are now 24 sick people! Laura and most of her friends are so sick that they've been out of school for more than a week. Worse, a 2-year-old boy and a 3-year-old girl have been hospitalized. The tests come back positive for an influenza (flu) virus infection, that's caused by a very unusual influenza virus.
It turns out that most of the sick people are students, but they go to different schools in a large county. You need to figure out how the illness could have spread across schools so fast.
Definition

What is novel influenza?
Seasonal flu is a respiratory disease (a disease affecting the lungs) caused by seasonal influenza viruses. These are viruses that spread in people and cause flu epidemics every year, usually in the fall and winter months in the United States. Flu is usually spread from close contact with people via coughing or sneezing. Seasonal flu viruses are constantly changing, which means that the flu viruses that infect people one year can be different from the flu people get sick with the next year. This is one reason why you need to get a flu vaccine every season. Each season's vaccine is tailored to match what experts predict will be the most common viruses that season.
Novel flu viruses are viruses that are not usually seen in people—these viruses normally only infect animals such as birds or pigs. But they can infect people too, and even change in ways that let them spread between people like seasonal flu. Although novel flu virus infections are rare, they can be dangerous because seasonal flu vaccines usually don't protect against them and people usually won't have much natural immune protection against them.
Data

You decide to interview the sick teenagers, with the consent of their parents.
Based on the information you gathered, you see that they have a few things in common. Many of them played in or attended a state-wide baseball and softball tournament in Freemont, featuring teams from all across the state. Also, the county fair was recently in town, attracting big crowds. A few of the sick teenagers have traveled to other states and even other countries.
In order to get a better idea of how the sick teens were first exposed to this particular novel flu virus, you need to take a closer look and see how they spent their time over the past few weeks. You also need to interview a number of healthy teens who did those same activities. (We call this a case-control study.)
Tip

To figure out which activity most likely led to flu exposure, search through the data table to find the activity with the highest value for prevalence (which means the proportion of a population that has a certain condition) among sick teens AND the lowest value for prevalence among healthy teens.
2. Which of the following is most likely responsible for the outbreak?
Answer 1: Belonging to the Agriculture Club
[Incorrect]
You're right to suspect the Agriculture Club, since the prevalence rate is so much higher among the sick people (67%) than the healthy people (30%).
But take a look at the people who went to the county fair. The prevalence rate for those sick people (90%) is even higher, while people who didn't go to the fair had a rate of only 20%.
Keep investigating!
Answer 2: Going to the county fair
[Correct]
That's right! Nearly all of the sick people (90%) went to the county fair. That may be where they got sick, but you still don't know how, or what it was that infected them.
Keep investigating!
Answer 3: Being a teenager
[Incorrect]
It is true that the data shows you that all of those who are sick in this group are teenagers, but that's because you were looking only at teenagers. So everyone in this data table is a teen, even the healthy people.
But take a look at the people who went to the county fair. The prevalence rate for those sick people (90%) is high, while people who didn't go had a rate of only 20%.
Keep investigating!
Clue 3

The illness is spreading! There are now 54 sick people, including 9 adults. According to a recent update, a 67-year-old man and 3 kids are in the hospital.
You meet with the fair organizers who say that more than 10,000 people came to the fair during the 5 day event. There were carnival rides, food stands, a concert, a barn dance, and a number of animal exhibits. Of course, many people who went to the fair are perfectly healthy.
Since this is a novel flu virus with no other cases reported, you suspect that it may have come from an animal. You take a closer look at what kinds of animals the sick people were exposed to.
Data

As you talk to the sick and healthy teens who went to the fair, you're especially interested in the types of animals they were around. Some animals get the flu too, but their flu viruses usually aren't passed on to people. However, every now and then, an animal's flu strain (or type of flu) changes in a way that allows it to be spread among people easily.
You learn that many of the sick and healthy teens that you interviewed spent time around cows, chickens, and pigs. Some of them only spent an hour or two with animals, and some spent as many as 10 hours with them.
3. Why did so many people at the county fair get sick?
Answer 1: They spent a lot of time near pigs
[Correct]
That's right! You've discovered that the more time the teens you interviewed spent around pigs, the more likely they were to get sick. In fact, 40% of the people you interviewed who spent 8 hours near pigs got sick, while only 25% of the people who spent 6 hours were infected with the flu, and people who didn't go near pigs were completely healthy. That's a pretty strong link.
Flu outbreaks can spread quickly, so you need to keep working before it spreads even more!
Answer 2: They spent a lot of time near chickens
[Incorrect]
Sorry. The data do not seem to indicate that chickens were the source of infection.
Instead, the more time the teens you interviewed spent around pigs, the more likely they were to get sick. In fact, 40% of the people you interviewed who spent 8 hours near pigs got sick, while only 25% of the people who spent 6 hours were infected with the flu, and people who didn't go near pigs were completely healthy. That's a pretty strong link.
Flu outbreaks can spread quickly, so you need to keep working before it spreads even more!
Answer 3: We still can't tell
[Incorrect]
Take a closer look. The data show you pretty clearly that the more time the people you interviewed spent around pigs, the more likely they were to get sick.
Flu outbreaks can spread quickly, so you need to keep working before this spreads even farther!
Clue 4

It's been 19 days since Laura and her friends first got sick from this novel flu. There are now at least 72 sick people in this county alone, 11 have been hospitalized, and one person has died!
It also looks like the flu crossed the state line! You talk to health departments across the country and learn that there are at least 4,000 confirmed cases in 36 states, with dozens of people hospitalized. From the looks of it, you have a large outbreak on your hands, which may even turn into a pandemic!
With the number of cases quickly rising you begin to wonder whether all of these people attended the county fair or if they got infected somewhere else.
Definition

What's a pandemic?
A pandemic occurs when a disease spreads and affects a very large number of people across the globe .
Scientists monitor novel flu viruses carefully. A novel flu virus might cause a pandemic if the virus can spread efficiently from person to person and if most people don't have any immunity to the new virus. If the new flu virus can only be spread from animals to people or from one person to another, but no further, then it probably won't cause a pandemic. People can have some immunity to flu viruses that are similar to viruses they've had in the past. If a new flu virus is very different from earlier flu viruses, it may be more likely to cause a pandemic.
Though most people recover from seasonal flu after a week or two, a small percentage of people with flu die every year. A novel flu virus could be much more serious, and if a novel flu virus caused a severe pandemic, many people could die. This happened during the 1918 influenza pandemic, during which millions of people died.
Data

After careful consideration, you rule out the possibility that all of the new cases that are popping up across the country are a result of people attending the county fair. You arrange a virtual meeting with health departments across the United States to get more information about the cases.
Based on the information you gathered, you calculate the relative risk to figure out why so many people are getting sick.
Tip

Relative Risk (RR) describes the likelihood of some event (like getting food poisoning) occurring in a group of people with a potential risk factor (like eating spinach) compared to a group without that risk factor (in this example, not eating spinach). If the RR of getting sick after eating contaminated spinach was 5, then people who ate contaminated spinach would be 5 times more likely to get sick than people who did not eat contaminated spinach. The closer the relative risk is to 1, the greater the likelihood that an event occurring (like getting food poisoning) is about the same for both groups.
4. What do you think is the reason for the large increase in sick people?
Answer 1: The sick people lived throughout the United States on farms with pigs
[Incorrect]
You can forget about pigs now. It looks like people who live with someone that has this flu are at high risk of getting sick too! This means the new flu virus has developed the ability to be spread easily from person to person. It may have started by spreading from pigs to people at that county fair, but now it's spreading from person to person, and fast!
Can you stop it from spreading even more? Hurry!
Answer 2: Mosquitoes are spreading the virus across great distances
[Incorrect]
Nope. Mosquitoes don't spread the flu. Most flu is spread between people, although a few animals (i.e. birds and pigs) can spread it too.
From the looks of it, people who live with someone who has this new flu virus are at a high risk of getting sick too. This means that the new flu virus has developed the ability to spread easily from person to person. It may have started by spreading from pigs to people at that county fair, but now it's spreading from person to person, and fast!
Can you stop it from spreading even more? Hurry!
Answer 3: The virus can now spread from person to person
[Correct]
That's right! This new flu virus has developed the ability to be spread easily from person to person. It may have started by spreading from pigs to people at that county fair, but now it's spreading from person to person, and fast!
You're so close. One more clue to solve the outbreak!
Clue 5

After confirming your suspicion that the new flu virus is now being spread from person to person, you work with other experts at the Centers for Disease and Control and Prevention (CDC), as well as state health departments across the country, to keep track of the number of people who are sick. At last count, there were at least 52,100 sick people, 1,702 people in the hospital, and 94 deaths.
Worse, you learn that there are now thousands of cases in different countries. People are scared; the story of the new flu is all over the newspapers, Internet, and TV news! You tell people to stay home from work or school if they feel sick, so they don't spread the flu to others.
Health Tips

To reduce your chances of getting the flu, follow these steps:
- Get a flu vaccine every year. This is the most important step in protecting yourself against seasonal flu viruses. Everyone 6 months of age and older, with a few exceptions, should get a seasonal flu vaccine. If a vaccine is made to protect against a novel influenza virus, get that vaccine too. Try to avoid close contact with sick people. If you are sick with flu-like illness, stay home for at least 24 hours after your fever is gone except to get medical care or for other necessities. (Your fever should be gone without the use of a fever-reducing medicine.) While sick, limit contact with others as much as possible to keep from infecting them. Cover your nose and mouth with a tissue when you cough or sneeze. Throw the tissue in the trash after you use it. Wash your hands often with soap and water. If soap and water are not available, use an alcohol-based hand rub. Avoid touching your eyes, nose, and mouth. Germs spread this way. Clean and disinfect surfaces and objects that may be contaminated with germs like the flu.
5. What should you recommend that people do next?
Answer 1: Make sure to get a pandemic vaccine if one is offered
[Correct]
That's right. The best way to fight the flu is to make sure that as many people as possible have received a vaccine that will protect them from the virus. This is true for seasonal and novel flu strains.
If the vaccine isn't available yet, you should work to educate the public on ways to prevent the flu and its spread, like avoiding contact with people who are sick, washing hands often, and staying home if they're sick.
Congratulations, you solved the outbreak!
Answer 2: Avoid contact with sick people if they haven't been vaccinated
[Incorrect]
Everyone should avoid contact with sick people, regardless of whether they've been vaccinated or not. Since the flu vaccine is considered the best form of protection, it's a good idea to recommend people to get vaccinated as soon as possible.
If the pandemic vaccine isn't available yet, you should work to educate the public on ways to prevent the flu and its spread, like avoiding contact with people who are sick, washing hands often, and staying home if they're sick.
Your hard work helped solve the outbreak!
Answer 3: Wash their hands before coughing or sneezing
[Incorrect]
It's always a good idea to wash your hands often, to avoid getting sick. But if you're using your hands to cover your mouth while you cough or sneeze, be sure to head to the nearest sink to wash your hands right after. Otherwise, you can easily spread your germs to whatever or whoever you touch next.
In general, the best way to fight the flu is to make sure that as many people as possible get a vaccine that will protect them from the virus. This is true for seasonal and novel flu viruses.
If a pandemic vaccine isn't available yet, you should work to educate the public on ways to prevent the flu and its spread, like avoiding contact with people who are sick, washing hands often, and staying home if they're sick.
Your hard work helped solve the outbreak!
Learn More

Your hard work helped solve the outbreak!
Although this outbreak was not real, it's based on similar outbreaks that have occurred in the past. Experts at CDC are constantly on the watch for new flu viruses that could potentially spread worldwide, infecting millions.
In recent years, novel influenza viruses, from birds and pigs, have infected many people. Luckily none of these viruses have caused a pandemic since the 2009 H1N1 virus. Investigations into novel flu cases help scientists understand how and where the next flu pandemic may begin and allow for the creation of new, targeted flu vaccines that can protect us from novel flu viruses.
Millions of people get seasonal flu every year. While most recover some people die. People who are at greatest risk of severe or fatal flu illness include very young children, older adults, pregnant women and people with certain chronic health conditions. Make sure to "Take 3" actions to fight flu every year— (1) get a seasonal flu vaccine, (2) follow important safety steps like good hand washing and avoiding others when sick, and (3) take antiviral drugs if your doctor prescribes them. Antiviral drugs may be especially important in a pandemic if vaccine is not available yet.
Note: Several aspects of the original outbreak and investigation have been altered to fit the format and length of this application.
Back To Top
What Type Of Content Is This? Layer Map Scene App Quizlet
Source: https://www.cdc.gov/mobile/applications/sto/508STO.html
Posted by: pagehimern.blogspot.com

0 Response to "What Type Of Content Is This? Layer Map Scene App Quizlet"
Post a Comment